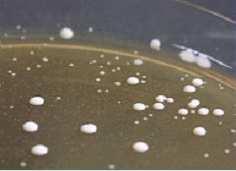

Temas Selectos de Ingeniería de Alimentos 2 – 2 (2008)
Cuerpo editorial
Dra. María Eugenia Barcenas Pozos
Dra. María Teresa Jiménez Munguía
M.
C. Fidel Vergara Balderas
I. A. Verónica Rodríguez Martínez
Temas Selectos de Ingeniería de Alimentos

Contenido
Temas Selectos de Ingeniería de Alimentos 2 – 2 (2008)
Temas Selectos de Ingeniería de Alimentos
Cuerpoeditorial................................... ......................................i
Editorial.......................................... ........................................iii
Organicvs.Conventionalfoods:abitofdilemmaforyou?........................................................1
Aplicacióndesustanciasantimicrobianasapelículasyrecubrimientoscomestibles.................4
Descripcióneimportanciadealgunosmodelospredictivosutilizadoscomoherramientapara laconservacióndealimentos.....................................................................................................14
DinámicadeSistemas:unaherramientaparalamicrobiologíapredictiva...............................27
Mecanismosdeacciónantimicrobianadetimolycarvacrolsobremicroorganismosdeinterés enalimentos...............................................................................................................................41
Tecnologíadeobstáculoscomométododeinhibicióndelcrecimientodemohosenalimentos ...................................................................................................................................................52
Desarrollodeunproductodezapotenegro(Diospyrosdigyna)dealtahumedad....................69
Efectodeagentesreductoresenlapropagaciónde Lactobacilluscasei enleche....................79
Evaluacióndemezclasbinariasyternariasdecarvacrol,timolyeugenolparalainhibiciónde Listeriainnocua ...................87
Modelacióndelainactivacióntermoultrasónicade Staphyloccocusaureus,unenfoque multifactorial..................................... ...................................102

Temas Selectos de Ingeniería de Alimentos 2 – 2 (2008)
Temas Selectos de Ingeniería de Alimentos
Editorial En este número se publican un artículo especial, cinco artículos de revisión ycuatro artículos deinvestigaciónenlaconservaciónydesarrollodealimentos.
Nos llena de orgullo la publicación del artículo especial que obtuvo el tercer lugar en el concurso de escritura técnica del IFT (Institute of Food Technologists) en la División de Educación.EstepremioloobtuvonuestraalumnadelicenciaturaLarissaValeriaJunco,quien cursaactualmenteel7ºsemestredeIngenieríadeAlimentos.
También queremos reconocer en estas líneas la labor realizada a través de la publicación de Temas Selectos de Ingeniería de Alimentos por los profesores y estudiantes del Posgrado en Ciencias de Alimentos, en particular en este número a los estudiantes del programa de doctorado. El trabajo que se realiza mediante la publicación de esta revista permite la recopilación de información de tecnologías de punta y datos previamente publicados en una formaorganizadayclara.
Finalmente,estosesfuerzosparadivulgarelconocimientoeneláreadelacienciaytecnología de los alimentos permiten desarrollar en los estudiantes la habilidad de la escritura y facilitan elaccesodeestosconocimientosalacomunidaduniversitaria.
Dra.CeciliaAnayaBerríos VicerrectoradeInvestigación,PosgradoyExtensiónUniversitaria UDLAP

Organic
Temas Selectos de Ingeniería de Alimentos 2 – 2 (2008): 1 – 3
vs.
Conventional foods:a bit of dilemma for you?
Tercerlugar:UndergraduateTechnicalWritingCompetition2008,InstituteofFood Technologists(IFT)EducationDivision
L. Valerio – Junco *
DepartamentodeIngenieríaQuímicayAlimentos,UniversidaddelasAméricas–Puebla. SanAndrésCholula,Pue.,México.
You’re standing in front of the fruit and vegetables section in your local market, and you have the option of choosing between organic and non-organic products. Which wouldyoupick?
Over the last years, there has been a considerable increase in the market for organic foods. “Modern” consumers, interested in health and wellbeing (might be your case), are demanding more “natural” and less processed foods (Winter and Davis, 2006). Probably, you have decided to buy organic fruits, vegetables, milk, poultry or meat because you are concerned about the environment and the immeasurable use of pesticides,severefarmingmethodsorbelieve that organic foods are safer or more nutritious than conventional ones. Although these alternative foods tend to be pretty higher in price, they appear to have become increasinglypopular;it’slikea“fashion”.
* Estudiante de séptimo semestre de Ingeniería de Alimentos. Tel.: +52 222 229 2126, fax: +52 222 229 2727. Direccion electrónica: larissa.valeriojo@udlap.mx
Whether you're already a fan of organic foods, you want to buy wisely or are just interested in the topic, here are some facts about organic foods that can help in order to stopthedilemmayoumightfacewhilegoing through your shopping list at the supermarket.
The opening inevitable question is: what are organic foods? According to Williamson (2007) the term “organic” is used to describe the food grown without the use of artificial fertilizers or pesticides, in a way based on crop rotation and assuring the soil’s fertility. The name also refers to animal welfare and no use of antibiotics. Organic products sold as such must be produced according to organic food production laws or regulations, as registered and approved by organic certification bodies like: USDA Organic (United States) or Soil Association (UK), between others. These bodies are responsible of appointing inspectors to visit farms and check, for example, that land has been farmed organically for a determined conversion period (normally of 2-3 years) before the food is sold as organic (Winter andDavis,2006).
L. Valerio – Junco / Temas Selectos
de
Ingeniería
Recent research has centered on investigating the effects of motives, beliefs and values on attitudes towards organic produce, purchase intentions and/or purchase frequency, reporting mixed results. What is more, these reasons have often been separated into two categories consisting of egoistic (individual or health) and altruistic motives(environmentaloranimalwelfare)as indicatedbyMichaelidouandHassan(2008)
For example, consumers like you may expect that organic fruits and vegetables should contain less agrochemical residues than conventionally grown crops. However, the significance of this difference is a bit questionable, as levels of contamination in both types of foods are generally well below the existing acceptable limits. Regarding other food safety issues about organic foods, such as pathogenic microorganisms, a small amount of information is available. Thus, additionalresearchisneeded;butsofarthere is little evidence to suggest that organic foods are any “safer” than non-organic (Williamson,2007).
Do you think there are nutritional differences between organic and non-organic foods? There seems to be a perception that organic foods are more nutritious and healthier, but there is limited data to support this view. Since all foods show natural variation in nutrient levels and depend on other factors including soil, climate, crop variety, degree of ripeness, freshness or the way animals are fed, it is difficult to carry a well-controlled study comparing both food alternatives. Even processed foods show differences because of their ingredients composition, processing treatments, storage conditions and packaging (Williamson, 2007).
Valid comparison studies should deal with plants cultivated in similar soils and climate conditions, sampled at the same time
de Alimentos 2 – 2 (2008): 1 – 3
and analyzed using the same validated method. Though, moderately evidence exists for lower levels of vitamin C in conventionallyproduced potatoesandstudies analyzing leafy vegetables have showed higher levels of vitamin C and lower nitrate levels in organically produced vegetables. It has also been found lower protein content, but higher quality protein in some organically produced legumes and cereal crops like wheat, rye and corn. But, this is not valid to all nutrients or crops and more research is required to corroborate these findings(Williamson,2007).
With regard to animal-derived foods, a study demonstrated significantly higher levels of alpha-tocopherol in 7 out of 10 samples oforganic milk;beta-carotenelevels were also observed higher and differences were thought to be mainly due to the animal’s diets, as species differences or genetic variations between animals of the same species. Despite other many findings regardingorganicmilk,reportsofdifferences in important nutrients like calcium, zinc or vitaminB12 lack(Williamson,2007).
Moreover, organic farming represents a sustainable method of agriculture. Nevertheless, with respect to safety and nutrient composition, it is premature to conclude that either food system is superior to the other or to recommend organic over non-organic foods (Winter and Davis, 2006). It’s clear that qualitative differences can exist, but in terms of maintaining good health,inagreementwithWilliamson(2007), it’s more important to follow a balanced and healthy diet, regardless of whether the foods areorganicor not. It’s yourchoice as awellinformedconsumer.
References
L. Valerio – Junco / Temas Selectos de Ingeniería de Alimentos 2 – 2 (2008): 1 – 3
Michaelidou, N. and Hassan, L. 2008. The role of health consciousness, food safety concern and ethical identity on attitudes and intentions towards organic food. International Journal of Consumer Studies. 32: 163-170.
Williamson, C. S. 2007. Is organic food better for your health? British Nutrition Foundation NutritionBulletin. 32: 104-108.
Winter, C. and Davis, S. 2006. Organic Foods. Journal of Food Science. 71: 117-124

Temas Selectos de Ingeniería de Alimentos 2 – 2 (2008): 4 – 13
Temas Selectos de Ingeniería de Alimentos
Aplicación de sustancias antimicrobianas a películas y recubrimientos comestibles
R.
Avila – Sosa *, A. López – Malo
DepartamentodeIngenieríaQuímicayAlimentos,UniversidaddelasAméricas–Puebla.
SanAndrésCholula,Pue.,México.
Resumen
Las películas y recubrimientos comestibles se definen como matrices continuas que pueden ser formadas por proteínas, polisacáridos y lípidos. Las películas y recubrimientos comestibles proveen la posibilidad de mejorar la calidad de los alimentos mediante la limitación de migración de humedad, grasas, oxígeno y compuestos responsables del sabor, color y aroma. Las películas y recubrimientos comestibles tienen la viabilidad para incorporar agentes antimicrobianos para proveer estabilidad microbiológica a los alimentos, ya que sirven como acarreadores de un amplio número de aditivos que pueden extender la vida en anaquel de un producto y reducir el riesgo de crecimiento de patógenos en la superficie de los alimentos. Esta revisión bibliográfica tiene como propósito describir y discutir las bases científicas de la formación de películas y recubrimientos comestibles, así como evaluar las aplicaciones que se han desarrollado en estos últimos años con la adición de diferentes sustancias antimicrobianas a las mismas.
Palabras clave: Películas comestibles, recubrimientos comestibles, antimicrobianos
Abstract
The edible films and coatings are defined as continues matrix that can be formed by proteins, polysaccharides and lipids. The aim of this review is to describe and discuss the scientific basis in the formation of edible films and coatings, and to evaluate the applications that have developed in the latter years with the addition of different antimicrobial substances. The edible coatings provide the possibility of improving the quality of heterogeneous foods by controlling the moisture, fat, flavour and color components migration, within the food. Also they have the potential to support the quality of a food after the package is opened, protecting it from the change of moisture, the exchange of oxygen and the loss of flavor. The edible films have the viability to incorporate antimicrobial agents and provide microbiological stability to the food, since they can be used as carriers of a wide number of additives which can extend the product shelf life and reduce the growth risk of pathogenic bacteria on food surface.
Key words:Ediblefilms,ediblecoatings,antimicrobial
* Programa de Doctorado en Ciencia de Alimentos
Tel.: +52 222 229 2126, fax: +52 222 229 2727
Direccion electrónica: raulavilasosa@hotmail.com
R.
Avila-Sosa
etal. / Temas Selectos de Ingeniería de Alimentos 2 – 2 (2008): 4 – 13
Introducción
El interés del consumidor por adquirir más alimentos que sean seguros, nutritivos, yque beneficienalasalud,en combinaciónconlas preocupaciones por el medio ambiente, han dirigido los esfuerzos de la investigación de las películas comestibles como una alternativa para cubrir estas necesidades. Existen fuentes disponibles, abundantes y renovables para ser usadas como agentes formadores de películas comestibles que pueden potencialmente reducir la necesidad de películas hechas con materiales sintéticos (Baldwin,1999;Guilbert et al., 2002).
Las películas comestibles formadas como recubrimientos o preformadas entre los componentes de un alimento, amplían las posibilidades de mejorar la calidad de los alimentos heterogéneos mediante el control de la migración de humedad, grasas, aromas, sabores y colores entre los componentes de un alimento o hacia el exterior del mismo, teniendo el potencial de mantener la calidad de un alimento después de abierto el empaque(Krochta,1997).
En tiempos recientes se han incrementado las aplicaciones de películas comestibles ofreciendo ventajas como biocompatibilidad, apariencia estética, propiedades de barrera y de funcionalidad, como la incorporación de agentes antioxidantes, antimicrobianos, entre otros aditivos funcionales (Cha y Chinnan, 2004;MarshyBugusu,2007).
Tomando en cuenta que en algunos alimentos el crecimiento microbiano se desarrolla en las superficies y que dicho crecimiento es la causa principal de su deterioro, la elaboración de las películas comestiblesconantimicrobianosseconvierte en un área de investigación prometedora. Lo anteriorsedebeaquelaaplicacióndirectade antimicrobianos en alimentos mediante aspersión, en polvo u otros métodos tiene
beneficios limitados, debido a que las sustancias activas son neutralizadas al contacto o se difunden rápidamente de la superficie al interior del producto (Cagri et al., 2004). La adición de antimicrobianos a películas comestibles muestra ventajas como el uso de menores concentraciones de antimicrobianos y una velocidad de difusión menor.
De aquí que el propósito de esta revisión sea describir y discutir las bases científicas delaformacióndepelículasyrecubrimientos comestibles y evaluar las aplicaciones que se han desarrollado con la adición de diferentes sustanciasantimicrobianasalasmismas.
Revisiónbibliográfica
Aspectos generales de las películas comestibles
Las películas y recubrimientos comestibles se definen como matrices continuas que pueden ser formadas por proteínas, polisacáridos y/o lípidos (Banker, 1966). En el Siglo XII los chinos formaban películas con cera para proteger productos cítricos de lapérdidadeagua.Elprimertipodepelícula desarrollado comercialmente fue la Yuba, formada a partir de leche de soya durante el Siglo XV en Japón, con fines de conservación. En la Inglaterra del Siglo XVI algunos productos se protegían con lardo de cerdo y desde 1930 en Estados Unidos se empezó a utilizar comercialmente la cera para naranjas y manzanas (Cagri et al., 2004).
Las películas y recubrimientos comestibles no pretenden sustituir a los empaques sintéticos diseñados para alimentos con tiempo de almacenamiento prolongado.Suutilidadrecaeenlacapacidad de actuar como un accesorio que mejora la
R. Avila-Sosa etal. / Temas Selectos de Ingeniería de Alimentos 2 – 2 (2008): 4 – 13
Tabla I. Principales materias primas utilizadas en películas comestibles
CaseinaGluten de trigoCelulosa
ColágenoProteína de suero de lecheQuitosano
Zeina de maízProteína de soyaAlmidón
GelatinaAlginatos
Tomado de Cagri et.al. ( 2004)
calidad de un alimento, extendiendo su vida de anaquel y la posibilidad de aumentar la eficiencia de los empaques de alimentos, mediante la incorporación de diversas sustancias que enriquecen sus propiedades funcionales (Kester y Fennema, 1986). El término “recubrimiento” se utiliza cuando una capa fina de un cierto material es aplicada en la superficie de una fruta o vegetal, independientemente del recubrimiento natural que las conserva (Srinivasa y Tharanathan, 2007). La diferencia entre una película y un recubrimiento comestible radica en el método de elaboración y formación. Los recubrimientos se forman directamente sobre la superficie de un alimento, mientras que la película se elabora de forma separada y en algunas ocasiones tiene una función de películadesoporte.
Las películas y recubrimientos comestibles están formados por tres componentes principales: polímero, solvente y plastificante. Se considera al polímero como el componente mayoritario de una película comestible. Las películas y recubrimientos comestibles se preparan a partir de polímeros como hidrocoloides o lípidos y se hacen películas compuestas cuando éstos se mezclan. En las películas y recubrimientos elaborados a partir de hidrocoloides se utiliza una gran gama de proteínas y polisacáridos como almidón, alginatos, derivados de celulosa, quitosano y derivados del agar (Tabla I). Cuando se utilizan lípidos, son de uso común las ceras, acilgliceroles, y ácidos grasos libres. Las
películas y recubrimientos compuestos son una mezcla de hidrocoloides y lípidos, junto con otros ingredientes que pueden variar en sus proporciones; la concentración de cada componente determina las propiedades mecánicas y de barrera de las películas y recubrimientos (Donhowe y Fennema, 1994; ChayChinnan,2004).
En cuanto al solvente, es necesario el uso de un compuesto que sea adecuado e inocuo paraalimentos.Generalmenteselimitaaluso de agua con una gran variedad de valores de pH para poder solubilizar al polímero; en rarasocasionesseutilizansolucionesacuosas deetanol(Banker,1966;Guilbert,1996).
El plastificante, a pesar de que se encuentra en menor proporción en la formulación de películas y recubrimientos comestibles, es un componente muy importante para poder formarlas. El uso de plastificantes tiene como objetivo principal emulsificar fases que no son miscibles, además de impartir características particulares a la película como flexibilidad y cierta resistencia. Los plastificantes suavizan la rigidez de la estructura de la película, incrementando la movilidad de las cadenas poliméricas y reduciendo las fuerzas intermoleculares, con esto se mejoran las propiedades mecánicas como la elongación. Es importante que el plastificante sea miscible en el polímero, generalmente se utilizan compuestos con bajo peso molecular yaltopuntodefusión.Elsorbitol,elglicerol, el manitol, la sacarosa y el polietilenglicol son los plastificantes de grado alimenticio
R. Avila-Sosa etal. / Temas Selectos de Ingeniería de Alimentos 2 – 2 (2008): 4 – 13
más utilizados; se puede utilizar al agua como plastificante, pero afecta de manera importante el contenido de humedad del recubrimiento. En las películas fabricadas con mezclas de lípidos e hidrocoloides, los plastificantes reducen el brillo de la película interfiriendo con los enlaces inter e intra moleculares por puentes de hidrógeno que se forman entre la fase lipídica y el hidrocoloide, lo cual produce un decremento en la fuerza de tensión y la temperatura de transición vítrea (Banker, 1966; Donhowe y Fennema, 1994; Guilbert, 1996; Cagri et al., 2004;SrinivasayTharanathan,2007).
Formación de películas y recubrimientos comestiblesysuspropiedadesfuncionales
La formación de la película generalmente involucra diferentes tipos de enlaces (iónico, covalente, puentes de hidrógeno, interacciones electrostáticas, fuerzas de Van der Walls) entre las cadenas que conforman al polímero, formando una red semirígida queatrapaeinmovilizaalsolvente.Dostipos de fuerzas intervienen a nivel molecular. La primera es la fuerza de cohesión que actúa entre las moléculas del polímero, y la segunda es la fuerza de adhesión que se ejerce entre la película y el soporte en donde se está formando. Sólo los polímeros de alto peso molecular tienen suficiente fuerza de cohesión y capacidad de coalescencia, para producir estructuras de películas apropiadas para diferentes solventes. El grado de
cohesiónafectalaspropiedadesdelapelícula como son la densidad, compactabilidad, porosidad, permeabilidad, flexibilidad y opacidad (Donhowohe y Fennema, 1994; Guilbert,1996;García et al.,2000).
Lacohesión yadhesiónestánrelacionadas con la estructura, composición química, peso molecular, regularidad de las cadenas estructurales, ramificaciones, polaridad y distribución de grupos polares de la cadena polimérica. La cohesión y rigidez de las películas se ven favorecidas por un orden superior de las cadenas. Los grupos polares disminuyen la difusión molecular pero promueven la formación de cadenas laterales ordenadas. La desnaturalización y algunos aditivos que promueven enlaces cruzados se utilizan para tener un orden molecular. La funcionalidad del polímero también está relacionada con las características del solvente. La solvatación del polímero y la extensión de la cadena polimérica pueden producirpelículasmáseficientes.Elgradode cohesión dependerá de la estructura polimérica, el solvente utilizado, la temperatura y la presencia del plastificante (Banker, 1966; Guilbert, 1996; Srinivasa y Tharanathan,2007).
Existen diferentes técnicas para darle la forma final a las películas y recubrimientos comestibles, las cuales incluyen: la eliminación del solvente, la gelación térmica y la solidificación. La primera se utiliza para
Retardan la migración de humedad
Retardan el transporte de gases (O2 y CO2)
Retardan la migración de grasas y aceites
Retardan el transporte de solutos
Mejoran las propiedades mecánicas de los alimentos
Imparten integridad adicional a la estructura de los alimentos
Retienen compuestos volátiles de aroma
Contienen aditivos alimentarios
Tomado de Kester y Fennema, (1986)
R. Avila-Sosa etal. / Temas Selectos de Ingeniería de Alimentos 2 – 2 (2008): 4 – 13
producir películas de hidrocoloides, se forma una estructura homogénea estabilizada por interacciones químicas y físicas intermoleculares. En la segunda, se aplica un tratamientotérmicoquepermitelaformación de un gel, el cual es estable y formará junto con el plastificante una estructura rígida. Estos dos métodos se aplican tanto para formar películas de soporte como recubrimientos en alimentos. En lo que respecta a la solidificación, las macromoléculas son disueltas en un solvente junto con el plastificante; al homogenizarse, la mezcla se vierte en un molde formando una capa fina la cual, al secarse, se libera de la superficie obteniéndose una película (Cagri et al.,2004).
Las características funcionales importantes deunapelículadependerán dela aplicación particular al producto alimenticio
yde su modo primario de deterioro. Algunas de estas características aparecen en la Tabla II.
Las películas que se forman de polisacáridos son selectivamente permeables al CO2 y O2, por lo tanto, retardan la respiración y envejecimiento de muchas frutas y vegetales mediante la limitación del oxígeno. Generalmente son películas hidrofílicas que permiten el paso de vapor, previniendo la condensación de agua, que es una fuente potencial de crecimiento de microorganismos (Cha y Chinnan, 2004). Muchas investigaciones se han enfocado a mejorar las propiedades físicas mediante la disminución de la capacidad hidrofílica, añadiendo materiales hidrofóbicos que mejoran las propiedades de absorción de agua del ambiente (Rhim et al., 2006). El mezclado de polímeros es un método

Fig. 1. Representación esquemática de la conservación de alimentos con y sin películas comestibles adicionadas con diversos tipos de aditivos (Rooney, 2002).
R. Avila-Sosa etal. / Temas Selectos de Ingeniería de Alimentos 2 – 2 (2008): 4 – 13
efectivo para conferir a las películas característicasdiferentesynuevas.
La Figura 1 da una representación esquemática de la conservación de alimentos medianteelusodepelículascomestibles,que pueden tener actividad, evitando el deterioro en un alimento provocado por la respiración, deshidratación, ganancia de humedad, desarrollo superficial de microorganismos u oxidación(Guilbert et al.,2002).
Antimicrobianos utilizados en películas comestibles
Las películas comestibles tienen la capacidad de incorporar agentes antimicrobianos para proveer estabilidad microbiológicaalosalimentos; yaquesirven como acarreadoras de un amplio número de compuestos, los cuales incluyen enzimas, agentes quelantes, bacteriocinas, benzoatos, propionatos, parabenos, sorbatos, agentes curantes, yantimicrobianos de origen natural como los aceites esenciales (Tabla III). Estos compuestos tienen la capacidad de extender la vida de anaquel de un producto y reducir el riesgo de crecimiento de patógenos en la superficie de los alimentos (Rooney, 2002; Cagri et al., 2004; Min y Krochta, 2005; Lin yZhao,2007;OzdemiryFloros,2008).
Se pueden elegir agentes inhibitorios específicamente para un tipo de contaminante de origen microbiano que esté presente en el alimento. Se puede también, conociendo la velocidad de difusión del antimicrobiano en el producto, controlar la
incorporación de otros agentes a la película como agentes antioxidantes, colorantes y saborizantes, para mejorar sus características funcionales.
Cuando se elaboran películas comestibles que contienen sustancias antimicrobianas, se esperaquetenganlacapacidaddemigrarhac ia la superficie del alimento o permanecer retenidas en la película. Ambos fenómenos determinan la efectividad antimicrobiana de una película y se presentan en compuestos antimicrobianos tanto sintéticos como naturales. La migración dependerá de las interacciones electrostáticas entre el antimicrobiano y las cadenas del polímero, los fenómenos de ósmosis iónica, los posibles cambios estructurales inducidos por la presencia del agente antimicrobiano y las condicionesambientalesalasqueseexponen las películas y recubrimientos elaborados (ChayChinnan,2004;Sebti et al.,2007).
La difusión de los antimicrobianos en una película comestible está influenciada por el tipo de polímero, plastificante y proceso de elaboración; las característicasdel alimento a recubrir, como pH y actividad de agua; las propiedades hidrofílicas de la película; y las condiciones de temperatura y tiempo de almacenamiento (Lin yZhao, 2007; Ozdemir yFloros,2008).
Los diferentes agentes antimicrobianos que son incorporados a películas o recubrimientos comestibles, por sus diversas características químicas, forman parte de la estructura de la película, mediante la
III. Agentes antimicrobianos utilizados en películas antimicrobianas
BenzoatosNaClPediocina
SorbatosAcido lácticoLisosima
ParabenosAcido acéticoLactoferrina
PropionatosNitritosAceites esenciales
Acidos grasosNisina
Cagri et.al. (2004)
R. Avila-Sosa etal. / Temas Selectos de Ingeniería de Alimentos 2 – 2 (2008): 4 – 13
interacción con elpolímero yelplastificante. Este fenómeno impide que el compuesto antimicrobiano migre (Cha y Chinnan, 2004; MinyKrochta,2005).
Los primeros esfuerzos por generar películas comestibles antimicrobianas se enfocaron al uso de polímeros como el quitosano, que además de formar parte de la estructura de la película comestible también, en ciertas concentraciones, tienen la capacidad de inhibir el crecimiento microbiano. La actividad antimicrobiana del quitosano se deriva de las cargas positivas que interfieren con algunos residuos de macromoléculas cargadas negativamente que se encuentran en la membrana celular, provocando agujeros en la misma, y lixiviación celular. Las películas formadas por quitosano limitan la contaminación en la superficie de los alimentos (Cooksey, 2005). Coma et al. (2002) elaboraron películas de quitosano (1% p/v), reportando la inhibición del crecimiento superficial de Listeria monocytogenes en un 80%, y determinando el mecanismo de acción a nivel de la membrana celular. Así también, Sebti et al. (2005) informaron acerca de la inhibición de Aspergillus niger en películas con bajas concentraciones de quitosano (0.1% p/v), pero presentado bajas permeabilidades al agua.
En este aspecto, para mejorar la permeabilidad al agua se han diseñado películas con mezclas de diferentes componentes, como por ejemplo quitosano y metilcelulosa, cuya aplicación exitosa se ha probado recubriendo fresas (Park et al., 2005), ya que ha evitado el crecimiento de mohos, prolongando la vida de anaquel. Estas mezclas han mejorado considerablemente no sólo el aspecto antimicrobiano, sino también las propiedades funcionales, físicas y mecánicas de los alimentos recubiertos. También se han incluido en las mezclas materiales sintéticos
como óxido de polietileno, polipiridinas y nanocompuestos de silicatos. En estas investigaciones sehaencontrado, además del efecto antimicrobiano, la formación de películas muy delgadas con mejores propiedades físicas como la opacidad y la permeabilidad al vapor de agua (Rhim et al 2006;Zivanovic et al.,2007).
Se puede considerar como una segunda etapa, la incorporación de sustancias antimicrobianas de tipo sintético a una gran variedad de películas y recubrimientos. Comúnmente se han utilizado ácidos orgánicos débiles y sus sales derivadas. Este tipo de compuestos tiene la capacidad de actuar tanto en hongos como en bacterias, provocandodañosalamembranaplasmática. El grado de disociación de estas sustancias, estáenfuncióndelpHylacomposicióndela película. Se ha observado que la mayoría de estos compuestos,cuandosonincorporadosa la matriz de la película comestible, disminuyen la migración hacia el alimento aumentandosu actividad superficial(Cuppett 1994; Cha y Chinnan, 2004). Este tipo de compuestos se han aplicado en forma de recubrimientos a una gran variedad de alimentos como frutas, verduras, pescados, carnes, productos lácteos, productos de panificación, entre otros, obteniendo reducciones considerables en la carga microbiana y en la inhibición de microorganismos patógenos que se desarrollan en la superficie de estos alimentos(Cagri et al.,2004).
Sin embargo, el avance de las técnicas analíticas ha puesto en duda la inocuidad de algunas sustancias que se consideraban seguras para el ser humano, generando el rechazo hacia ciertos aditivos químicos. Debido a esto, en los últimos años se han tratado de diseñar películas antimicrobianas que muestren efecto sin la migración de los componentes activos, o se ha buscado añadir
R. Avila-Sosa etal. / Temas Selectos de Ingeniería de Alimentos 2 – 2 (2008): 4 – 13
antimicrobianos de tipo natural (Avila-Sosa et al.,2008;OzdemiryFloros,2008).
Se han realizado diversas investigaciones en sistemas naturales de protección antimicrobiana. Entre las sustancias que se han utilizado para inhibir tanto mohos como bacterias se encuentran lactoferrina, lactoperoxidasa, nisina y lisozima. Cooksey (2005) aplicó nisina a recubrimientos de metilcelulosa sobre salchichas, reduciendo significativamente la presencia de Listeria monocytogenes. Trabajos como los de Min y Krochta (2005) permitieron demostrar que la incorporación de lactoferrina y lactoperoxidasaapelículasdesuerodeleche, inhibió el crecimiento de Penicillium commune. Min et al. (2008) reportaron una apropiada difusión de lisozima en un recubrimiento para salmón ahumado para conservarlo y retardar el crecimiento de Pseudomonas spp. en la superficie del mismo.
En cuanto al uso de aceites esenciales, recientemente se han descubierto propiedades antimicrobianas contra microorganismos patógenos. Zivanovic et al. (2005) incorporaron aceites esenciales de orégano, albaca y anís, en diferentes concentraciones, a películas de quitosano; observaron un efecto inhibitorio en Listeria monocytogenes y E. coli O157:H7. Resultados similares presentaron Rojas-Graü et al. (2007), quienes elaboraron películas de alginato-puré de manzana adicionadas con aceites esenciales de té limón, canela y orégano; yMaizura et al. (2007),mediantela aplicación de aceite de té limón a películas de almidón, en las cuales no se vieron afectadas las permeabilidades a gases y al vapordeagua.
También se han desarrollado investigaciones en las que este tipo de películas adicionadas con aceites esenciales se aplicaron como recubrimientos a
diferentes tipos de alimentos. Oussalah et al. (2004) aplicaron aceites esenciales de orégano y chile a recubrimientos de suero de leche en carne magra de res, inhibiendo a E. coli O157:H7. Estos investigadores también desarrollaron, para el mismo alimento, recubrimientos de alginato adicionados con aceites de orégano y canela. Los resultados mostraron que en el caso de la carne magra de res, la vida en anaquel se prolongó un 10% y hubo una reducción de 0.95 a 1.34 ciclos logarítmicos de Pseudomonas spp. (Oussalah et al., 2006). Recientemente se aplicó aceite de orégano a recubrimientos para embutidos (Chi et al., 2006), en los cuales se utilizaron películas de quitosano, aumentando el tiempo de almacenamiento y la inhibición microbiana. En ninguno de estos productos hubo evidencia de migración de sustancias fenólicas al alimento y en ambos casos se logró un buen nivel de aceptaciónsensorial.
Conclusiones
Laaplicacióndesustanciasantimicrobianasa películasyrecubrimientoscomestiblesofrece ampliasposibilidadesparadesarrollarnuevos sistemas de conservación de alimentos, ya que comparado con la aplicación directa de antimicrobianos a las superficies de los alimentos, las películas y recubrimientos comestibles con antimicrobianos son más efectivos. Adicionalmente las características de formación y aplicación de películas comestibles pueden mejorar las propiedades organolépticas, mecánicas, nutricionales yde protección individual de piezas pequeñas de alimentos. De aquí la importancia de continuar estudiando las propiedades y aplicaciones de las películas adicionadas con antimicrobianos,poniendoespecialinterésen el potencial de utilizar específicamente antimicrobianosnaturales.
R. Avila-Sosa etal. / Temas Selectos de Ingeniería de Alimentos 2 – 2 (2008): 4 – 13
Referencias
Avila-Sosa, R., Gastélum-Franco, M. G., CamachoDávila, A., Torres-Muñoz, J. V. y NevárezMoorillón, G. V. 2008. Extracts of Mexican oregano (Lippia berlandieri Shauer) with antioxidant and antimicrobial activity. Food BioprocessTechnology. En prensa.
Baldwin, E. A. 1999. Surface treatments and edible coatings in food preservation. En: M. S. Rahman (Ed). Handbook of Food Preservation. Marcel Dekker, N.Y. EE.UU. pp. 577-609.
Banker, G. S. 1966. Film coating theory and practice. JournalofPharmaceuticalSciences. 55(1): 81-89.
Cagri, A., Ustunol, Z. y Ryser, E. T. 2004. Antimicrobial edible films and coatings. Journalof FoodProtection. 67(4): 833-848.
Coma, V., Martial-Gros, A., Garreau, S., Copinet, A., Salin, F. y Deschamps A. 2002. Edible antimicrobial films based on chitosan matrix. JournalofFoodScience. 67(3): 1162-1169.
Cooksey, K. 2005. Effectiveness of antimicrobial food packaging materials. Food Additives and Contaminants. 22(10): 980-987.
Cuppett, S. 1994. Edible coatings as carriers of food additives, fungicides and natural antagonists. En: J. M. Krochta, E. A. Baldwin y M. O. NisperosCarriedo (Eds). Edible coatings and films to improve food quality. Lancaster: Technomic Publishing, Basilea. pp. 121-137.
Cha, D. S. y Chinnan, M. S. 2004. Biopolymer-based antimicrobial packaging: A review. Critical Reviews in Food Science and Nutrition. 44: 223237.
Chi, S., Zivanovic, S. y Penfield M. P. 2006. Application of chitosan films enriched with oregano essential oil on bologna-active compounds and sensory attributes. Food Science Technology International. 12(2): 111-117.
Donhowe, I. G. y Fennema, O. 1994. Edible films and coatings: Characteristics, formation, definitions and testing methods. En: J. M. Krochta, E. A. Baldwin y M. O. Nisperos-Carriedo (Eds). Edible coatings and films to improve food quality. Lancaster: Technomic Publishing, Basilea. pp. 124.
Garcia, M. A., Martino, M. N. y Zaritzky, N. E. 2000. Lipid addition to improve barrier properties of
edible starch-based films and coatings. Journal of FoodScience. 65(6): 941-947.
Guilbert, S. 1996. Technology and application of edible protective films. En: G. Barbosa-Cánovas, y J. S. Welti-Chanes (Eds). Food Preservation by moisture control, Fundaments and applications. Isopow Practicum II, N.Y. EE.UU. pp. 371-394
Guilbert, S., Redl, A. y Gontard, N. 2002. Mass transport within edible and biodegradable proteinbased materials: Application to the design of active biopackaging. En: J.S. Welti-Chanes, G. BarbosaCánovas, y J.M. Aguilera (Eds). Engineering and Foodforthe21stCentury. CRC Press, Boca Ratón EE.UU. pp. 567-577.
Kester, J. J. y Fennema, O. 1986. Edible films and coatings: A review. FoodTechnology. 12: 47-59.
Krochta, J. M. 1997 Edible protein films and coatings. En: S. Damodaran y A. Paraf (Eds). Food proteins and their applications. Marcel Dekker, N.Y. EE.UU. pp. 529-550.
Lin, D. y Zhao, Y. 2007. Innovations in the development and application of edible coatings for fresh and minimally processed fruits and vegetables. Comprehensive Reviews in Food ScienceandFoodSafety. 6: 60-74.
Maizura, M., Fazilah, A., Norziah, M. H. y Karim, A A. 2007. Antibacterial activity and mechanical properties of partially hydrolyzed sago starchalginate edible film containing lemongrass oil. JournalofFoodScience. 72 (6): C324-C330.
Marsh, K. y Bugusu, B. 2007. Food packaging-roles, materials, and environmental issues. Journal of FoodScience. 72(3): R39-R55.
Min S. y Krochta, J. M. 2005. Inhibition of Penicilliumcommune by edible whey protein films incorporating lactoferrin, lactoferrin hydrolysate, and lactoperoxidase systems. Journal of Food Science. 70(2): M87-M94.
Min S., Rumsey, T. M. y Krochta J. M. 2008. Diffusion of the antimicrobial lysozyme from a whey protein coating on smoked salmon. Journal ofFoodEngineering. 84: 39–47
Oussalah, M., Caillet, S., Salmiéri, S., Saucier, L. y Lacroix, M. 2004. Antimicrobial and antioxidant effects of milk protein-based film containing essential oils for the preservation of whole beef muscle. Journal of Agricultural and Food Chemistry. 52: 5598-5605.
R. Avila-Sosa etal. / Temas Selectos de Ingeniería de Alimentos 2 – 2 (2008): 4 – 13
Oussalah, M., Caillet, S., Salmiéri, S., Saucier, L. y Lacroix, M. 2006. Antimicrobial effects of alginate-based film containing essential oils for the preservation of whole beef muscle. Journal of FoodProtection. 60 (10): 2364-2369.
Ozdemir M. y Floros J. D. 2008. Optimization of edible whey protein films containing preservatives for mechanical and optical properties. Journal of FoodEngineering. 84: 116–123.
Park, S., Stan, S. D., Daeschel, M. A. y Zhao Y. 2005. Antifungal coatings on fresh strawberries (Fragaria x ananassa) to control mold growth during cold storage. Journal of Food Science. 70 (4): M202-M207.
Rhim, J. W., Hong, S. I., Park, H. M. y Perry, K. W 2006. Preparation and characterization of chitosanbased nanocomposite films with antimicrobial activity. Journal of Agricultural and Food Chemistry. 54: 5814-5822.
Rojas-Graü, M. A., Avena-Bustillos, R. J., Olsen, C., Friedman, M., Henika, P. R., Martín-Belloso, O., Pan, Z. y McHugh, T. H. 2007. Effects of plant essential oils and oil compounds on mechanical, barrier and antimicrobial properties of alginateapple puree edible films. Journal of Food Engineering. 81: 634-641.
Rooney, M. L. 2002. Active Packaging: Science and Application. En: J. S. Welti-Chanes, G. BarbosaCánovas, y J. M. Aguilera. Engineering and Food for the 21st Century. CRC Press, Boca Ratón EE.UU. pp. 539-547.
Sebti, I., Chollet, E., Degraeve, P., Noel, C. y Peyrol, E. 2007. Water sensitivity, antimicrobial and physicochemical analyses of edible films based on HPMC and/or chitosan. Journal of Agricultural andFoodChemistry. 55: 693-699.
Sebti, I., Martial-Gros, A., Carnet-Pantiez, A., Grelier, S. y Coma V. 2005. Chitosan polymer as bioactive coating and film against Aspergillus niger contamination. Journal of Food Science. 70(2): M100-M103
Srinivasa, P. C. y Tharanathan, R. N. 2007. Chitin/Chitosan-Safe, ecofriendly packaging materials with multiple potential uses. Food ReviewsInternational. 23: 53-72.
Zivanovic, S., Chi, S. y Draughon E. 2005. Antimicrobial activity of chitosan films enriched with essential oils. Journal of Food Science. 70 (1): M45-M51.
Zivanovic, S., Jiajie, L., Davidson, M. y Kit, K. 2007. Physical, mechanical, and antibacterial properties of chitosan/PEO blend films. Biomacromolecules 8: 1505-1510.

Temas Selectos de Ingeniería de Alimentos 2 – 2 (2008): 14 – 26
Descripción e importancia de algunos modelos predictivos utilizados como herramienta para la conservación de alimentos
N.A. Santiesteban – López*, A. López – Malo
DepartamentodeIngenieríaQuímicayAlimentos,UniversidaddelasAméricas–Puebla.
SanAndrésCholula,Pue.,México.
Resumen
La Microbiología Predictiva es una rama de la Microbiología de los Alimentos que estudia las respuestas microbianas frente a varios factores ambientales que se pueden controlar, dando como resultado respuestas que son cuantificadas y resumidas mediante ecuaciones matemáticas. En este trabajo se hace una revisión de la descripción e importancia de algunos modelos predictivos utilizados como herramienta para la conservación de alimentos. Debido a que la aplicación de los modelos matemáticos al crecimiento de los microorganismos permite predecir su comportamiento en las condiciones de almacenamiento, su aplicación supone una mayor precisión en la fijación de la vida comercial del producto.
Palabras clave: Microbiología Predictiva, metodologías para el recuento microbiano, modelos de crecimiento microbiano.
Abstract
Predictive microbiology is part of Food Microbiology, focused to evaluate and describe microbial responses under the effects of several environmental factors. These factors can be controlled as a result of parameters that can be quantified and analyzed using mathematical equations. In this review some predictive models are described and used as a tool for Food conservation. These mathematical models are used for describing the microbial growth and predict the behavior during storage conditions, to know the shelf life of food products.
Keywords:Predictive Microbiology Predictive, microbial counting metodologies, model microbial growth
Introducción
El diagnóstico microbiológico estábasadoen técnicas de laboratorio que requieren un tiempo asociado al crecimiento de los microorganismos, el cual tiene un impacto
* Programa de Doctorado en Ciencia de Alimentos
Tel.: +52 222 229 2126, fax: +52 222 229 2727
Direccion electrónica: asantiesteban2@hotmail.com
desfavorable en la toma de decisiones, especialmente en la industria (Preser et al., 1998). El tiempo requerido para la revitalización de las células, y su recuento a través de las Unidades Formadoras de Colonias (UFC), es de al menos 48 horas. Temas Selectos de Ingeniería de Alimentos
N. A. Santiestaban-López et al. / Temas Selectos de Ingeniería de Alimentos 2 – 2 (2008): 14 – 26
Además, para la identificación de patógenos escomúnrecurrirapruebasbioquímicasode medios selectivos, lo cual conduce a esperar días o incluso semanas para obtener resultados.Portalmotivosehandesarrollado métodos rápidos para obtener resultados en menor tiempo (Rassoly y Herold, 2008), entre los cuales están los propuestos por la MicrobiologíaPredictiva.
La Microbiología Predictiva se ha convertido en unaherramientadevanguardia mundial que permite evaluar, mediante modelos matemáticos apropiados, las respuestas de los microorganismos a los factores del medio ambiente. Esta disciplina ha sido aplicada en gran medida a bacterias patógenas o microorganismos asociados al deterioro de los alimentos. Sin embargo, la Microbiología Predictiva puede extender sus alcances a otros ámbitos como Medicina, Biología e incluso Farmacia, en los cuales se estudia el crecimiento o inactivación de microorganismos(Preser etal.,1998).
La Microbiología Predictiva puede ser utilizada para modelar el crecimiento, sobrevivencia o muerte de los microorganismos en función de los principales factores de conservación de alimentos, especialmente cuando estos factoressonutilizadosdemaneraconjuntaen los llamados métodos combinados de conservación.
Actualmente, dado que los modelos predictivos han evolucionado del laboratorio de investigación básica, al ser utilizados por la industria y las agencias reguladoras, se deben considerar como estimadores iniciales de la conducta microbiana y servir de guías para evaluar problemas potenciales (Buchanan y Klawitter, 1991; Whiting y Buchanan, 2001). Los modelos predictivos no reemplazan completamente la evaluación y comprobación del comportamiento microbiano, ni el buen juicio del
microbiólogo experimentado, sin embargo, pueden proporcionar información muy útil paralatomadedecisionesenlafabricacióny conservación de alimentos (Whiting y Buchanan,2001).
De aquí que el objetivo de esta revisión sea describir algunos modelos usados en Microbiología Predictiva, así como resaltar su importancia y aplicación como una herramienta para la conservación de alimentos.
RevisiónBibliográfica
Definición e historia de la Microbiología Predictiva
La Microbiología Predictiva es el conocimiento detallado de las respuestas microbianas a determinadas condiciones ambientales, el cual permite una evaluación objetiva del efecto de los parámetros de procesamiento y almacenamiento sobre la calidad y seguridad de los alimentos. Esta respuestaincluyelaacumulacióndeunaserie de conocimientos sobre el comportamiento de los microorganismos en los alimentos, trayendocomoconsecuencialaderivaciónde modelos matemáticos (McMeekin et al., 2002).
La Microbiología Predictiva se basa en la modelación matemática para describir el comportamiento microbiano y posteriormente predecir el crecimiento. Con el apoyo de esta técnica, problemas sobre el deterioro microbiano de los alimentos y la seguridad alimentaria, pueden resolverse mediante un análisis objetivo con base en conocimientos científicos (Preser et al., 1998).Estoes realmentenotable,envistadel aumento de las toxi-infecciones por alimentosenmuchospaíses.
Se ha reconocido que el origen de los modelos predictivos en alimentos fue un modelo desarrollado por Esty y Meyer (1922), empleado para describir el tratamiento térmico necesario para destruir 10 12 esporasde Clostridium botilinum tipoA (Whiting y Buchanan, 2001; McMeekin et al., 2002). Este modelo describió un proceso con un gran margen de seguridad y probablemente su uso continuo impidió que se reconociera, en su momento, como un modelopredictivo.
En otras referencias, se sitúa el inicio del uso de la Microbiología Predictiva en la década de 1930, cuando Scott estableció que el conocimiento de la velocidad de crecimiento de ciertos microorganismos a diferentes temperaturas era de vital importancia para los estudios sobre el deterioro de la carne fresca. Una vez obtenidos estos datos, se podía predecir la influencia relativa ejercida por varios organismos en el deterioro a cada temperatura de almacenamiento. Scott entendió claramente el uso potencial de la acumulación de datos cinéticos sobre la respuesta de los microorganismos, para predecir la vida útil y la seguridad de los alimentos(McMeekin et al.,2002).
Después de mucho tiempo de silencio de la Microbiología Predictiva en la literatura científica, en las décadas de 1960 y 1970 los modelos predictivos fueron empleados para resolver problemas de intoxicación alimentaria, en particular botulismo. (Spencer y Baines, 1964; Nixon, 1971; Roberts et al.,1981).
Sin embargo, fue hasta la década de 1980 cuando empezó el interés por la Microbiología Predictiva como resultado de un masivo brote de toxi-infecciones alimentariasyporconsiguiente,laconciencia pública de la necesidad de suministrar alimentos sanos y seguros. Dos
microorganismos patógenos transmitidos por los alimentos, uno tradicional como es el caso de Salmonella y otro tipo emergente, Listeria monocytogenes de origen psicrótrofo, favorecieron a situar a las investigaciones alimentarias como una prioridad para los gobiernos de los Estados Unidos, Reino Unido, Australia y Nueva Zelanda(McMeekin et al.,2002).
Durante los años 1980 y parte de los 1990, diversos enfoques de modelos cinéticosdecrecimientodominaronlaescena de la Microbiología Predictiva, pero en la actualidad es evidente el regreso de los modelos de probabilidad de crecimiento, lo cualsepuedeatribuiralosiguiente:
a) Reconocimiento dequelavariabilidad de las respuestas en un tiempo estimado (tiempo de generación y duración de la fase de latencia) no presenta una distribución normal,pero comúnmente es descrita por una distribución Gaussiana inversa, en donde la varianza de la respuesta es directamente proporcional al cuadrado o al cubo del promedio de la respuesta al tiempo (Ratkowsky et al., 1996).
b) En el caso de patógenos potencialmente peligrosos (Escherichia coli O157:H7), en situaciones en las que el microorganismo se tiene en una dosis infectante baja, se requiere de su conocimiento para recomendar condiciones que eviten su multiplicación, por lo que la probabilidad de encontrar este tipo de microorganismos es más importante que el conocer su velocidad de crecimiento, máxima densidad de poblacióno sutiempodegeneración.
Los modelos de predicción permiten interpolar entre los puntos de datos experimentales, ayudando a predecir respuestas para condiciones no estudiadas (Fernández et al., 1997). Así también, los
N. A. Santiestaban-López et al. / Temas Selectos de Ingeniería de Alimentos 2 – 2 (2008): 14 – 26
modelos predictivos de crecimiento permiten estimar la vida útil de los alimentos, evaluar las condiciones higiénicas con las que fue elaborado un alimento, identificar los puntos críticos de control en el proceso, guiar acerca de cómo las variables del medio afectan el comportamiento de los microorganismos patógenos o deteriorativos y determinar la seguridad microbiológica del alimento(McMeekin et al.,1997).
Parámetroscinéticos de los modelos
El crecimiento en el ámbito microbiológico se refiere al incremento en el número de células por La fase de latencia unidad de tiempo en una población microbiana (Madigan et al., 1997). En este caso, es importante tener en cuenta la presenciademicroorganismoscenocíticos,es decir, multinucleados, en los que la división nuclear no es acompañada de división celular,porlocualelcrecimientoproduceun incrementodetamañoperonodelnúmerode células.Elcrecimientooriginaunincremento en el número de células cuando los microorganismos se multiplican por fisión binariaogemación(Prescott etal.,1999).
La curva de crecimiento de un microorganismo se puede subdividir en cuatro fases distintas: fase de latencia (lag), fase exponencial (log), fase estacionaria y fase de muerte (Fig.1). Fase de latencia es el periodo en que las células se adaptan a un medio de cultivo antes de iniciar su crecimiento. Fase exponencial o logarítmica es aquélla en la que los microorganismos crecen y se dividen hasta un número máximo, todo esto en función del medio, condiciones de crecimiento y potencial genético. En este periodo hay una relación lineal entre el logaritmo del número de células y el tiempo de incubación. Debido a que cada célula se divide en momentos mínimamente diferentes, la curva de crecimientoaumentasuavemente,enlugarde realizar saltos bruscos. La fase estacionaria es aquélla en donde se presenta la disminución de la velocidad de crecimiento, como resultado de la disminución de los nutrientes disponibles o el efecto de la acumulación de productos tóxicos del metabolismo. Por último, la fase de muerte es una consecuencia de diversos factores, el más importante es el agotamiento de las reservas de energía por parte de las células

microbianas. Esta fase también tiene una relación lineal delas células viables, quevan decreciendo, conforme transcurre el tiempo (Madigan et al.,1997;Prescott et al.,1999).
En el proceso de crecimiento existen varios factores para la adaptación del microorganismo como es el caso de la composición del medio o del estado fisiológico de la cepa. Por ello, la variabilidad de las respuestas microbianas influye de diferentes maneras en la predicción cinética de los microorganismos. Dichas respuestas se ven reflejadas en los parámetros de crecimiento como: tiempo de latencia, tiempo de generación, velocidad de crecimientoymáximovalordecrecimiento.
Tiempo de latencia (λ). Durante este periodo existeunajusteen el que las células de los microorganismos sacan provecho del ambiente nuevo y empieza el periodo de crecimiento exponencial (Buchanan y Klawitter, 1991). El crecimiento y multiplicación de microorganismos patógenos o deteriorativos en los alimentos no es deseable. Por lo tanto, es importante calcular con exactitud su tiempo de latencia, lo cual la mayoría de las veces no se consigue con un nivel confiable (Mc Meekin et al., 1997). Para el caso de las cinéticas de inactivación microbiana, eltiempo de latencia se observa como un “hombro” en la curva logarítmica de inactivación (Geeraerd et al.,2000).
Tiempo de generación. El tiempo de generación es el tiempo necesario para duplicar la población microbiana. El tiempo de generación varía dependiendo del tipo de microorganismo. Un gran número de bacteriastieneuntiempodegeneraciónde13 horas; es muy difícil encontrar microorganismos que se reproduzcan en 10 minutos. Sin embargo, este parámetro es útil para indicar el estado fisiológico de una población microbiana. Con el tiempo de
generación se puede evaluar el efecto positivo o negativo de un tratamiento en particular sobre una población microbiana (Madigan et al.,1997).
Velocidad de crecimiento (µm). La velocidad de crecimiento se define como la pendiente en la fase de crecimiento exponencial y está directamente relacionada coneltiempodegeneración.Lavelocidadde crecimiento es el aumento de la masa celular por unidad de tiempo y se ve influenciada por factores ambientales (temperatura, composición del medio, entre otros), así como por algunas características genéticas del microorganismo (Madigan et al.,1997).
Máximo valor de crecimiento (A). Es la asíntota de la curva de crecimiento logarítmico (fase estacionaria), que se presentaenlaFig.1
Tiposdemodelos
Los modelos predictivos se clasifican en función de su complejidad como primarios, secundarios y terciarios. A continuación se presenta una breve descripción de estos tres tiposdemodelos.
Modelos primarios. Los modelos primarios se ocupan de la descripción de los cambios del número microbiano (crecimiento, multiplicación, inactivación), en función del tiempo. Para la cuantificación de los microorganismos se pueden incluir Unidades Formadoras de Colonias (UFC), biomasa, medidas de absorbancia, o niveles de los metabolitos producidos (Geeraerd et al., 2004). Muchos delos modelos primarios que se han desarrollado hasta ahora, son modelos que determinan la cantidad de población microbiana. En estos modelos, el desarrollo de un número total de células de una población es descrito por un sencillo conjunto de parámetros: máximo valor de
N. A. Santiestaban-López et al. / Temas Selectos de Ingeniería de Alimentos 2 – 2 (2008): 14 – 26
crecimiento (A), velocidad de crecimiento (µm) y tiempo de latencia (λ) (Swinnen et al.,2004).
La bibliografía sugiere que la suma del comportamiento de células de manera individual es igual al de la población, y esto es lo que lleva al desarrollo de enfoques más mecanísticos para la Microbiología Predictiva (Baranyi, 1997). Lo anterior conduce a las técnicas de modelación probabilística, en las que los parámetros del modeloestáncasualmentedistribuidosdentro de la población total. Esto significa que los parámetros del modelo son parte de una distribución aleatoria, lo cual puede representar la variabilidad biológica entre las células individuales. Los modelos de probabilidad se tornan más útiles cuando el tamaño del inóculo es pequeño y el tiempo de latencia individual es altamente variable dentro de esta pequeña población (Swinnen et al., 2004). Como ejemplos de modelos primarios se encuentran la ecuación de Gompertz, ecuación Baranyi y Roberts y el Modelo lineal en tres fases. La ecuación de Gompertzsepresentaacontinuación:
)) exp( exp( x m A y λ µ = (Ec.1)
Donde: A se refiere al máximo valor de crecimiento, µm, es la velocidad de crecimientoy λ, eseltiempodelatencia.
Modelos secundarios. Los modelos predictivos secundarios caracterizan los parámetros que aparecen en los modelos primarios, en función de las condiciones del medio, como la temperatura, pH, aw, etc., observándose la interacción entre dos o más factoressobreelcrecimientomicrobiano.
Antiguamente, los modelos secundarios para el tiempo lag sólo se referían al efecto quepresentabalatemperaturadeincubación; sin embargo, en la actualidad han surgido
modelos que incluyen otros factores relevantes como las condiciones de preenriquecimiento.
Otros autores han desarrollado modelos secundarios independientemente del tiempo de generación y el tiempo de latencia, como por ejemplo enfoques polinomiales (Gibson et al.,1988; BuchananyPhilips,1990; Zaika et al., 1998) y enfoques de redes neuronales artificiales de baja complejidad (Zwietering et al., 1994; Geeraerd et al., 1998; GarcíaGimeno et al.,2002).Entreotrosejemplosde los modelos secundarios están la ecuación de Arrhenius, losmodelosderaízcuadrada yel modelo de superficies respuesta (Buchanan y Klawitter,1991). Laecuación2 corresponde alaEcuacióndeArrhenius: ) exp( RT Ea = ∞µ µ (Ec.2)
Donde: µ se define como la constante de velocidad de reacción, Ea, es la energía de activación, R, la constante de los gases, T es latemperatura absoluta yµ∞,se define como factorpreexponencial.
Modelos terciarios. Los modelos terciarios tienen varias formas, empezando por combinar los dos primeros niveles de modelos (primario y secundario), basados en experimentos de laboratorio. Un ejemplo representativo de este tipo de modelos es el “Pathogen Modeling Program”, creado y puesto a disposición de la comunidad científica gratuitamente porlaUSDA; dicho modelo permite importar una serie de datos de temperatura para predecir la vida útil. Otro ejemplo es el “Seafood Spoilage Predictor” (Dalgaard et al., 2002), el cual incluye a microorganismos deteriorativos específicos para alimentos del mar. Finalmente, los modelos terciarios permiten incluso incorporar modelos predictivos en una red de evaluación de riesgos microbiológicos, comopor ejemploel SERA
N. A. Santiestaban-López et al. / Temas Selectos de Ingeniería de Alimentos 2 – 2 (2008): 14 – 26
(“Salmonella enteritidis Risk Assesment”) del USDA. Los modelos terciarios son informáticos(Geeraerd et al.,2004).
Construccióndelosmodelos predictivos
La construcción de un modelo predictivo implica las siguientes etapas: selección de cepas de microorganismos, generación de datos, aplicación de un modelo primario, secundario o terciario y validación del modelo aplicado. Las etapas iniciales de este procesosondefundamentalimportanciapara la correcta aplicación del mismo, por lo que sedescribenacontinuación:
Selección de cepas de microorganismos. Existen varios criterios que se emplean para elegir la cepa a utilizar para la construcción de un modelo. Puede elegirse una cepa única o una mezcla de diferentes cepas (cocktail). Lasmezclasdecepasestánsiendoempleadas ampliamente en los modelos predictivos, debido a que tienen una representación más realdelasituaciónquepresentaunalimento.
Antes de elegir una cepa es muy importante poner en claro la intención a la que va dirigido el modelo, por ejemplo: ¿El modelo se va a utilizar para predecir el posible crecimiento de una especie de patógeno en particular, o es un modelo de una flora de microorganismos deteriorativos deunalimentoespecífico?
El utilizar una cepa que ya haya sido estudiada en otros experimentos científicos o incluso con el propósito de crear otros modelos, proporciona la ventaja de tener conocimientos sobre esa cepa en particular. Porotro lado,laelección deunacepaaislada apartirdeun alimento parael cual sequiere generar el modelo, da la ventaja del conocimientodelproducto(Rasch,2004).
La hipótesis de que la variación entre cepas podría ser igual o menor que la
variación estadística experimental, fue evaluadapor Whiting yGolden (2002).Ellos estudiaron el crecimiento, supervivencia, inactivación y producción de toxinas de 17 cepas diferentes de E.coli, y observaron que las variaciones entre cepas fueron mayores que las incertidumbres relacionadas con el errorexperimental.
Salter et al. (1998) compararon el crecimiento de E.coli M 23 no patógena con el crecimiento de varias especies de E.coli patógena, y sólo encontraron pequeñas diferencias en las respuestas de crecimiento entre las diferentes cepas. El modelo generado resulta de gran utilidad, ya que muchos investigadores no tienen acceso a instalaciones de laboratorio adecuadas para trabajar con cepas patógenas de E.coli, y el modelo que predice el comportamiento de E.coli M23 es capazde describirel decepas patógenas de E.coli, incluyendo E.coli O157H:7.
Método de recuento de células viables. El método más utilizado para monitorizar el crecimientodeunapoblaciónbacterianaesel recuento de células viables. Sin embargo, como se ha discutido anteriormente, el análisis microbiológico convencional presenta varias limitaciones, entre las cuales el tiempo requerido para la revitalización, enriquecimientoeincubacióndelasmuestras es probablemente la más importante. Además, para la identificación de un microorganismo se requieren medios selectivos y pruebas bioquímicas, lo que puededemorarelresultadopordíasoincluso semanas.Debidoaestaslimitaciones,hasido necesario recurrir al desarrollo de métodos rápidos que permitan disponer de los resultadosenhoras(Sieuwerts et al., 2008).
Para la estimación exacta de los parámetros de una curva de crecimiento son importantes el número y la calidad de los recuentos hechos por expertos técnicos
(Bratchell et al., 1989; Poschet et al., 2004). Walker y Jones (1993) recomiendan que, como mínimo, se obtengan 10 datos por punto. Baty y Delignette –Muller (2004) compararon el ajuste de tres modelos con conjuntos con pocos datos por punto y conjuntos con muchos datos por punto, indicando que la imprecisión en los parámetros estimados está visiblemente relacionadaconlacantidaddedatos.
Para facilitar el recuento del crecimiento microbiano se están desarrollando y estandarizando métodos alternativos como citometría de flujo, turbidimetría, impedanciometría, microscopía, entre otros (Begot et al.,1996).
Al comparar con los recuentos viables, la turbidimetría y la impedanciometría son considerados métodos automáticos, los cuales permiten analizar un elevado número de experimentos, mientras que la citometría de flujo y la microscopía permiten obtener información adicional, como puede ser el estado fisiológico de las células (Rasch, 2004).
Método de citometría de flujo. La citometría de flujo permite la medición de diversas características físicas y químicas de células individuales en suspensión, proporcionando así una indicación de la heterogeneidad de una población de células eucariotas y procariotas en cuestión de minutos (Davey y Kell, 1996; AlvarezBarrientos et al.,2000;Novo et al.,2000).
Las célulasindividualesconfinadasdentro de un chorro de agua pasan rápidamente por una ventana de medición, en la cual varios parámetros de millones de células por segundo pueden ser medidos simultáneamente con alta precisión (VivesRego et al., 2000). La dispersión de la luz refleja el tamaño y la estructura celular, mientras que las mediciones defluorescencia
permiten determinar el contenido celular de cualquier constituyente que pueda ser marcado con un tintefluorescente(Walber et al., 1997). De esta manera, la citometría de flujocombinalaventajadeserunatécnicade células individuales, con el poder de medir millares de células en corto tiempo. Los datos resultantes no sólo son un promedio de mediciones de células, sino también son una distribucióndelosparámetrosmedidosenlas células.
Con la citometría de flujo, la posibilidad de medición de una distribución de datos da una estimación de la heterogeneidad de la población microbiana y, de ese modo, también la posibilidad de detectar subpoblaciones que, por ejemplo, son resistentes a un tratamiento bajo ciertas condiciones de investigación. El uso de la citometría de flujo en Microbiología Predictiva está limitado por los costos de los equipos; sin embargo, existen reportes de su uso. Tal es el caso de las investigaciones de Sorensen y Jacobsen (1997), quienes usaron citometría de flujo para enumerar las células viables de Debaryomyces hansenii en diferentes condiciones ambientales. Los datos de crecimiento fueron empleados para modelar el tiempo de latencia (λ) y la máximavelocidaddecrecimiento(µmax),en función de la temperatura, pH y concentracióndeNaCl.
Método de turbidimetría. La turbidimetría es un método empleado para estudiar el crecimiento bacteriano a través de mediciones de densidad óptica, lo que permite tener una secuencia del crecimiento microbiano en tiempo real (Dalgaard et al., 1994; Begot et al., 1996). La densidad óptica o absorbancia se ha utilizado desde hace varios años para medir la concentración, yes expresadaen masa, número o longitud media celular de suspensiones bacterianas (Meynell yMeynell,1970).
N. A. Santiestaban-López et al. / Temas Selectos de Ingeniería de Alimentos 2 – 2 (2008): 14 – 26
La absorbancia (A) se define como el logaritmo decimal del cociente entre la intensidad de la luz incidente sobre la suspensión (Io) y la luz transmitida por la suspensión (I) (Ec.3)(Stainer et al.,1989):
) ( ) log( I Io A = (Ec.3)
El fundamento de la técnica es que las partículas pequeñas difractan la luz, dentro deciertoslímites,deformaproporcional asu concentración. Las mediciones se hacen con unfotómetrooespectrofotómetro.
De acuerdo con McMeekin et al. (1997), en la turbidimetría, el crecimiento microbiano está relacionado con la turbidez del medio. Estos autores resaltaron las limitaciones del método, siendo la más importantequeunrecuentoviablesólopuede hacerse si el equipo está calibrado para relacionar la absorbancia con un número de microorganismos dado (Mc Meekin et al., 1997).Sinembargo,esposibleidentificarlos parámetros de crecimiento cuando el tamaño del inóculo está por debajo del umbral de detección. Para este caso es necesario conocer los recuentos celulares iniciales y la ecuacióndecalibración(Bréand etal.,1997).
Método TTD (tiempos de detección). Este método consiste en medir, después de un tratamiento térmico establecido, la probabilidad de no crecimiento de una poblacióndemicroorganismosensuspensión en condiciones de cultivo determinadas. Se trata de un análisis que permite evaluar el número más probable de supervivientes (método indirecto). Este método depende de la temperatura y el tiempo de tratamiento para lograr un efecto fisiológico (Rasch, 2004).
Método de microscopía. La microscopía permite estudios directos de células individuales, lo que hace posible dar un
seguimiento ala misma céluladurantelargos periodos de tiempo. La microscopía ha ido ganado interés con el desarrollo de programas computacionales como el de interferometría óptica y el análisis de imagen. Una de las ventajas de este método es quepermiteestudiarsistemassólidoscuya situación es muy parecida a la que presentan los sistemas alimentarios (Rasch, 2004). Hay pocos reportes bibliográficos del uso de la microscopía en el modelado predictivo. Sin embargo, existen comparaciones con el método TTD (tiempos de detección) para la determinación de la fase de latencia de células de Listeria monocytogenes (Martínez et al., 2005). Se ha observado que la microscopía tiene ventajas sobre la TTD, ya que es un método directo que permite la observación visual de la primera división celular, mientras que la TTD depende del tiempo para la detección, la tasa de crecimiento y la extrapolación regresiva a la célula individual. Además, cualquier tratamiento que resulte en ausencia de la división celular no será detectable a través delmétodoTTD(Wu etal.,2000).
Validacióndelosmodelos
La validación de los modelos predictivos puedehacersededosformas:
a) Validación matemática que verifica la precisióndelosmodelosgenerados.
b) Validación en el alimento (sistema real), en lacual lo quese requierees demostrar que el modelo predice con exactitud el comportamiento de los microorganismos durante el procesado, almacenamiento y distribución(Geeraerd et al.,2004).
Es importante validar un modelo para evaluar la habilidad predictiva del mismo (Geeraerd et al., 2004). La precisión de los modelos se evalúa gráficamente cuando se enfrentan los valores obtenidos en el laboratorio contra las correspondientes
predicciones del modelo. Además, los valores del coeficientedecorrelación (R2),el error cuadrado promedio y los factores de sesgo y de exactitud, se emplean como indicadores de la confianza de los modelos cuando se aplican en alimentos (Giffel y Zwietering,1999).
Sin embargo, es importante mencionar que aún cuando un modelo haya resultado adecuado para predecir los datos experimentales, la aplicación de modelos predictivos en alimentos todavía es cuestionable(Zhao et al.,2002).
Importanciadelosmodelos predictivos
Es interesante conocer cómo se emplean permanentemente los modelos predictivos en la investigación científica, industria e inclusive en la vida cotidiana. A continuación se mencionan algunas de las aplicaciones más importantes de los modelos predictivos:
• Los modelos predictivos ayudan a tomar decisiones inmediatas en el re-proceso de alimentos, por ejemplo, en eventos fuera deprocesotalescomolafaltadesalenel producto o una inadecuada refrigeración delalimento.
• Los modelos predictivos ayudan a predecir el grado crecimiento y/o sobrevivencia de algunos de los microorganismos de interés (patógenos o deteriorativos), bajo condiciones normales de almacenamiento, detectando de esta manera alguna falla en el proceso de almacenamiento y/o distribución. También ayudan a estimar las fechas de caducidad en términos de descomposición microbiana (Peleg, 2006).
• Los modelos predictivos permiten identificar los puntos críticos de control en un proceso en el que sehaimplantado
un programa de Análisis de Riesgo y ControldePuntosCríticos(ARICPC).
• Los modelos predictivos son herramientas educativas, especialmente parapersonas nopreparadasen el áreade Microbiología de Alimentos, porque a través de ellos se demuestra la importancia de mantener condiciones de almacenamiento apropiadas (Van Impe et al.,2005).
Conclusiones
ElprogresodelaMicrobiologíaPredictivaen los últimos años ha sido muy importante, de tal suerte que la Microbiología Predictiva está siendo utilizada en una gran variedad de operaciones en el ámbito de la investigación y la industria. Los modelos predictivos son ahora una herramienta normal de investigación y una ayuda valiosa para evaluar y diseñar procesos de conservación de alimentos. Sin embargo, no es todavía posible depender solamente de los modelos paradeterminarlaseguridaddelosalimentos y su procesamiento. Las pruebas de laboratorio siguen siendo necesarias para determinar inequívocamente el crecimiento, supervivencia o muerte de los microorganismos inicialmente presentes en unalimento.
Referencias
Álvarez – Barrientos, A., Arroyo, J., Cantón, R., Nombela, C. y Sánchez-Pérez, M. 2000. Applications of flow cytometry to clinical microbiology. Clinical Microbiology Review. 13: 167-195.
Baranyi, J. 1997. Simple is good as long as it enough FoodMicrobiology.14:189–192.
Baty, F. y Delignette-Muller, M. L. 2004. Estimating the bacterial lag time: which model, which precision?. International Journal of Food Microbiology. 91:261-277.
Begot, C., Desnier, I., Daudin, J. D., Labadie, J. C. y Lebert, A. 1996. Recommendations for calculating growth parameters by optical density measurements. Journal of Microbiological Methods. 25:225-232.
Bratchell, N., Gibson, A. M., Truman, M., Kelly, T. M., y Roberts, T. A. 1989. Predicting microbial growth: the consequences of quantity of data. International JournalofFoodMicrobiology. 8:47–58.
Bréand, S., Fardel, G., Flandrois, J. P., Rosso, L. y Tomassone, R. 1997. A model describing the relationship between lag time and mild temperature increase duration. International Journal of Food Microbiology. 38: 157-167.
Buchanan, R. L. y Klawitter, L. A. 1991. Effect of temperature history on the growth of Listeria monocytogenes Scott at refrigeration temperatures. International Journal of Food Microbiology 12:235-246.
Buchanan, R. I. y Phillips, J. G. 1990. Response surface model for predicting the effects of temperature, pH, sodium chloride content, sodium nitrite concentration and atmosphere on the growth of Listeria monocytogenes Journal of Food Protection. 53:370–376.
Dalgaard, P., Buch, P. y Silberg, S. 2002. Seafood spoilage predictor – Development and distribution of a product specific application software. International Journal of Food Microbiology. 73:34 –349.
Dalgaard, P., Ross, T. K. y Mc Meekin, T. A. 1994. Estimation of bacterial growth from turbidimetric and viable count data. International Journal of FoodMicrobiology. 25:391–404.
Davey, H. y Kell, D. 1996. Flow cytometry and cell sorting of heterogeneous microbial populations: the importance of single-cell analysis. Clinical MicrobiologyReview. 60: 641-696.
Esty, J. y Meyer, K. F. 1922. The resistence on the spore of B.Botulinum and allied anaerobes XI. JournalsofInfectiosDiseases. 31:650-663.
Fernández, P. S., George, S. M., Sills, C. C. y Peck, M. W. 1997. Predictive model of the effect of CO2, pH, temperature and NaCl on the growth Listeria monocytogenes International Journal of Food Microbiology. 37:37–55.
García-Gimeno, R. M., Hervás-Martínez, C. y Silóniz, M. I. 2002. Improving artificial neural networks with a pruning methodology and genetic algorithms
for their application in microbial growth prediction in food. International Journal of Food Microbiology. 72:19-30.
Geeraerd, A. H., Herremans, C. H. y Van Impe, J. F. 2000. Structural model requirements to describe microbial inactivation during a mild heat treatment InternationalJournalofMicrobiology. 59:185–209.
Geeraerd, A. H., Herremans, C. H., Cenens, C. y Van Impe, J. F. 1998. Application of artificial neural networks as a non-linear modular modeling technique to describe bacterial growth in chilled food products. International Journal of Food Microbiology. 44:49–68.
Geeraerd, A. H., Valdramidis, V. P., Devlieghere, F., Bernaerts, H., Debevere, J. y Van Impe, J. F. 2004. Development of a novel approach for secondary modelling in predictive microbiology: incorporation of microbiological knowledge in black box polynomial modelling. International Journal of FoodMicrobiology. 91:229–244.
Gibson, A. M., Bratchell, N. y Roberts, A. 1988. Predicting microbial growth: growth responses of salmonella in laboratory medium as affected by pH, sodium chloride and storage temperature. International Journal ofFoodMicrobiology. 6:155–178.
Giffel, M. C. y Zwietering, M. H. 1999. Validation of predictive models describing the growth of Listeria monocytogenes. International Journal of Food Microbiology. 46:135-149.
Madigan, M. T., Martinko, J. M. y Parker, J. 1997. Brock Biology of Microorganisms. Prentice Hall International, Inc.177 p.
McMeekin, T. A., Olley, J., Ratkowsky, D. A. y Ross, T. 2002. Predictive microbiology: towards the interface and beyond. International Journal of Food Microbiology. 73:395–407.
McMeekin, T. A., Brown, J., Krist, K., Ratkowsky, D y Ross T. 1997. Quantitative Microbiology: a basis for food safety. Emerging Infectious Diseases. 3(4):541-544.
Martínez, A. M., Ruiz, P., Martínez, A. y Ocio, M. J. 2005. Predictive microbiology and role in food safety systems. En G. Barbosa-Cánovas, M. S. Tapia y P. M. Cano (Eds.). Novel Food Processing Technologies. Boca Ratón, Florida. CRC Press. 799 p.
Meynell, G. G. y Meynell, E. I. 1970. Density optical. En: G. G. Meynell y E. I. Meynell,. Theory and
N. A. Santiestaban-López et al. / Temas Selectos de Ingeniería de Alimentos 2 – 2 (2008): 14 – 26
Practice in Experimental Bacteriology. Vol. I. Cambridge University Press, Nueva Jersey. pp.1-19.
Nixon, P. A. 1971. Temperature integration as a means of assessing storage conditions. Report on Quality in Fish Products. Seminar N° 3. Fishing Industry Board, Wellington, Nueva Zelanda. 34-44.
Novo, D., Perlmutter, N., Hunt, R. y Shapiro H. 2000. Multiparameter flow cytometry analysis of antibiotic effects on membrane potential, membrane permeability, and bacterial counts of Staphylococcus aureus and Micrococcus luteus. AntimicrobialAgents Chemother. 44:827-834.
Peleg, M. 2006. Advanced Quantitative Microbiology for Food and Biosystems Models for Predicting GrowthandInactivation. Taylor and Francis Group, LCC. CRC. Boca Raton FL. 1340 p.
Poschet, F., Bernaerts, K., Geeraerd, A. H., Scheerlink, N., Nicolaï, J. F. y Van Impe, J. F. 2004. Sensitivity analysis of microbial growth parameter distribution with respect of data quality and quantity by using Monte Carlo analysis. Mathematics and Computers inSimulation 65:231–243.
Prescott, L. M., Harley, J. P. y Klein, D. A. 1999. Microbiología. Cuarta edición. McGraw-Hill. Interamericana. 500 p.
Preser, K. A., Ross, T. y Ratkowsky, D.A. 1998. Modelling the growth limits (growth/no growth interface) of Escherichia coli as a function of temperature, pH, lactic acid concentration and water activity. Applied and Environmental Microbiology 64:1773-1779.
Rasch, M. 2004. Experimental design and data collection. En. R.C. Mc Kellar y W. Lu. Modelling Microbial Responses in Food. CRC Series in Contemporary Food Science. CRC Press. pp. 520599.
Rassoly, A. y Herold, K. E. 2008. Food microbial pathogen detection and analysis using DNA microarray technologies. Foodborne Pathogen Disease. 5(4):531-50
Ratkowsky, D. A., Ross, T., Macario, N., Dommett, T W. y Kamperman, L. 1996. Choosing probability distributions for modeling generation time variability. Journal of Applied Bacteriology. 80:13–137.
Roberts, T. A., Gibson, A. M. y Robinson, A. 1981. Prediction of toxin production by Clostridium botulinum in pasteurised pork slurry. Journal of FoodTechnology. 16:337–355.
Salter, M. A., Ross, T. y McMeekin, T. A. 1998. Applicability of a model for non-pathogenic Escherichia coli for predicting the growth for pathogenic Escherichia coli Journal of Applied Microbiology. 85:357–364.
Scott, M.G. 1930. The generation time, lag time and minimum temperature growth of coliform organism on meat. JournalofHygiene. 94:289-300.
Sieuwerts, S., Bok., F. A., Mols, E. y Van H. A. 2008. Simple and fase method for determining colony forming units. Letter Applicated Microbiology. 47(4):275-278.
Sorensen, B. B. y Jakobsen M. 1997. Viability staining and for citometric detection of Listeria monocytogenes. Journal of Microbiological Methods. 28:35-43.
Spencer, R. y Baines, C. R. 1964. The effect of temperature on the spoilage of wet fish: I. Storage at constant temperature between -1°C and 25°C. Food TechnologyChampaign. 18:769–772.
Stainer, R. Y., Ingraham, J. L., Wheelis, M. L. y Painter, P. R. 1989. Microbiología. Segunda edición. Reverté. 1020 p.
Swinnen, I. A. M., Bernaerts, K., Dens, E. J. J., Geeraerd, A. H. y Van Impe, J. F. 2004. Predictive modelling of the microbial lag phase: a review. International Jouirnal of Food Microbiology. 94:137–159.
Van Impe, J. F., Poschet, F., Geeraerd, A. H. y Vereecken, K. 2005. Towards a novel class of predictive microbial growth models. International JournalFoodMicrobiology. 100:97-105.
Vives- Rego, J., Lebaron, P. y Nebe-von Caron, G. 2000. Current and future applications of flow cytometry in aquatic microbiology. Microbiology Review. 24:429-448
Walber, M., Gaustad, P. y Steen, H. B. 1997. Rapid assessment of ceftamizidime, ciprofloxacin, and gentamicine susceptibility in exponentially-growing E.coli cells by means of flow cytometry. Cytometry. 27:169-78
Walker, S. J. y Jones, J. E. 1993. Protocols for data generation for predictive modelling. Journal of IndustrialMicrobiology. 12:273-276.
Whiting, R. C. y Buchanan, R. L. 2001. Predictrive microbiology and risk assessment. En M. P. Doyle, L. R. Beuchat y T.J. Montville. Food Microbiology Fundamentals and Frontiers. American Society for
N. A. Santiestaban-López et al. / Temas Selectos de Ingeniería de Alimentos 2 – 2 (2008): 14 – 26
Microbiology Press. Washington, D.C. pp. 22182240.
Whiting, R. C. y Golden, M. H. 2002. Variation among Escherichia coli O157:H7 strains relative to their growth, survival, thermal inactivation, and toxin production in broth. International Journal of Food Microbiology. 75:127–133.
Wu, Y., Griffiths, M. W. y McKellar, R. C. 2000. A comparison of the bioscreen method and microscopy for determination of lag times of individual cells of Listeria monocytogenes.Letterin AppliedMicrobiology. 30:468.
Zaika, L. L., Phillips, J. G., Fanelli, J. S. y Scullen, O. J. 1998. Revised model for aerobic growth of
Shigella flexneri to extend validity of predictions at temperatures between 10 and 19. International JournalofFoodMicrobiology. 4:9–19.
Zhao, L., Montville, T. J. y Schanffer, D. W. 2002. Time-to-detection, percent-growth-positive y maximum growth rate models for Clostridium botulinum 56A at multiple temperatures. International Journal of Food Microbiology. 77:187-197.
Zwietering, M. H., Wit, J. C., Cuppers, H. G. A. M. y Van’t Reit, K. 1994. Modeling of bacterial growth with shifts in temperature. Applied and EnvironmentalMicrobiology. 60:204–213.

Temas Selectos de Ingeniería de Alimentos 2 – 2 (2008): 27 – 40
Dinámica de Sistemas: una herramienta para la microbiología predictiva
G. G. Gastélum – Reynoso*, E. Palou – García y A. López – Malo
DepartamentodeIngenieríaQuímicayAlimentos,UniversidaddelasAméricas–Puebla. SanAndrésCholula,Pue.,México.
Resumen
La Microbiología Predictiva, es la aplicación de modelos matemáticos que describen el comportamiento microbiano con base en datos experimentales. Tiene como objetivo informar acerca del desarrollo de microorganismos patógenos y deteriorativos. Debido al complejo comportamiento microbiano y bioquímico de los alimentos, la Microbiología Predictiva presenta ciertas limitaciones. El enfoque de la Dinámica de Sistemas es una alternativa y una herramienta útil para simular y predecir el comportamiento de microorganismos en alimentos con la ayuda de interfaces y estructuras gráficas que junto con ecuaciones algebraicas sencillas, analizan el comportamiento (dinámica) y la estructura (relaciones entre variables o factores) del problema mejorando los modelos cuantitativos. El objetivo de este artículo es presentar una breve descripción de la Microbiología Predictiva, sus ventajas y limitaciones, así como proponer el enfoque de la Dinámica de Sistemas como una alternativa para modelar y predecir el comportamiento de los microorganismos en los alimentos.
Palabras clave: Microbiología Predictiva, Microbiología de Alimentos, Dinámica de Sistemas.
Abstract
Predictive Microbiology is the application of mathematical models to describe microbial behavior based on experimental data in order to prevent both food spoilage and food-borne illness. Because of both, complexity of microbial behavior and food systems, Predictive Microbiology presents some limitations. System Dynamics could be an alternative and useful tool to model and predict microbial behavior in foods providing a graphical interface and structures related with a series of equations, to clarify and improve quantitative model descriptions. The aim of this paper is to present a brief review of Predictive Microbiology, its advantages and limitations as well as to suggest System Dynamics as an alternative approach to model and predict food microbial behavior in foods.
Key words: Predictive Microbiology, Food Microbiology, System Dynamics
Introducción
Una de las principales preocupaciones de la industria de alimentos es la inocuidad.
* Programa de Doctorado en Ciencia de Alimentos
Tel.: +52 222 229 2126, fax: +52 222 229 2727
Direccion electrónica: ggastel@hotmail.com
El concepto actual de inocuidad alimentaria se ha visto influenciado por la demanda de los consumidores al exigir alimentos más frescos y más saludables (Alzamora et al., 2000). Como respuesta a esta necesidad, la industriadealimentoshadesarrolladonuevas tecnologías; sin embargo, los niveles de los Temas Selectos de Ingeniería de Alimentos
G. G. Gastélum-Reynoso etal. / Temas Selectos de Ingeniería de Alimentos 2 – 2 (2008): 27 – 40
factores de conservación aplicados a los alimentos son menos drásticos; por lo tanto, existe mayor riesgo de crecimiento de microorganismos patógenos y deteriorativos (Martínez etal.,2005).
La capacidad de supervivencia o muerte de un microorganismo depende de la composición del alimento y la combinación delosdiversosfactoresdeconservación(pH, actividad de agua, temperatura, etc.). Estos factores actúan como obstáculos para el crecimientomicrobiano.Unodelosobjetivos que persigue la industria es determinar las condiciones óptimas de procesamiento para obtener alimentos inocuos, previniendo o disminuyendoelriesgodelcrecimientoy/ola producción de toxinas de microorganismos patógenos(Tapia etal.,2000).
Con estefin, existen algunas herramientas para evaluar la inocuidad alimentaria: pruebas de almacenamiento, pruebas de reto microbiano yMicrobiologíaPredictiva(MP).
La MP es la aplicación de modelos matemáticos que describen el comportamiento microbiano basado en datos experimentales y tiene como objetivo informar acerca del desarrollo de microorganismos patógenos y deteriorativos (Tapia et al.,2000;BettsyEveris,2005).
Debido a la complejidad del comportamiento microbiano ybioquímico de los alimentos, la MP presenta ciertas limitaciones. Una de las más importantes es que las herramientas para la modelación microbiana en general, no se aplican bajo un enfoque global y no consideran variaciones en la condiciones del sistema (Lebert y Lebert,2006).Enlamayoríadeloscasos,los modelos matemáticos son simplificaciones de procesos en donde no se incluyen todas lasvariablesofactores(BuchananyWhiting, 1997).
Una alternativa para simular y predecir modelos en microbiología de alimentos es el enfoque de la Dinámica de Sistemas (DS). Estaesunametodologíaqueestudiasistemas de retroalimentación complejos (como el comportamiento microbiano en los alimentos) usando diagramas “causales” yde “flujos y niveles” junto con ecuaciones algebraicas simples, analizando el comportamiento -dinámica- y la estructurarelaciones entre variables o factores- del problema(RichardsonyPugh,1981).
Por más de 50 años, la DS se ha utilizado para estudiar sistemas económicos, de negocios y sociales. Los problemas en estos sistemas comparten estructuras similares (control de inventarios, densidad de población, etc.) que se asemejan a las que se encuentran en los problemas biológicos (resistencia a los antibióticos, farmacocinética, etc.). Así, la generalización de los modelos (pensamiento genérico) se convierte en una de las fortalezas para la modelación y simulación de la DS (Richardson y Pugh, 1981; Lebert y Lebert, 2006).
El propósito de este artículo es presentar una breve revisión sobre Microbiología Predictiva, sus ventajas y limitaciones; así como sugerir la metodología de la Dinámica de Sistemas como un enfoque alternativo para modelar y predecir el comportamiento de los microorganismos en sistemas alimenticios.
Revisiónbibliográfica
MicrobiologíaPredictiva
La Microbiología Predictiva es la aplicación de modelos matemáticos que describen y predicen el crecimiento, supervivencia e inactivación microbiana así
como sus procesos bioquímicos en condiciones específicas. Generalmente, los microorganismos se cultivan bajo condiciones o factores controlados como pH, actividad de agua (aw), temperatura, concentraciones de antimicrobianos, etc. Los resultadosdelcomportamientomicrobianose ajustan a ecuaciones matemáticas. Estos modelos se usan para predecir las respuestas del microorganismo bajo nuevas condiciones (o sus combinaciones) permitiendo la interpolación dentro delos rangos estudiados (Tapia et al., 2000; Betts y Everis, 2005; LebertyLebert,2006).
Los modelos de Microbiología Predictiva se clasifican en tres niveles. Los modelos primarios que describen los cambios de una población con respecto al tiempo (p.e. unidades formadoras de colonias (UFC), producción de toxinas) y además dan información acerca del microorganismo (duración de la fase lag). Los modelos secundarios los cuales describen cambios en los parámetros obtenidos en el modelo primario (UFC/ml) cuando cambian los factores ambientales (pH, aw, temperatura). Finalmente, los modelos terciarios que son interfaces que convierten los modelos primariosysecundariosensoftwaresencillos en donde se pueden variar los factores ambientales y microorganismos, obteniendo predicciones de los parámetros microbianos (Buchanan y Whiting, 1997; Betts y Everis, 2005).
Los modelos matemáticos son de gran ayuda para entender y predecir el comportamiento de los microorganismos bajo ciertas condiciones. Sin embargo, no siempre las predicciones se ajustan a los experimentos reales, por lo tanto, es necesario validar los modelos. El proceso de validación se lleva a cabo considerando el conocimiento microbiológico del sistema y con la ayuda de herramientas estadísticas
(Buchanan y Whiting, 1997; Mcleroy et al., 2000;Alzamora etal.,2005).
Una vez que los modelos han sido validados ylos usuarios están conscientes de las limitaciones de los mismos, éstos se pueden utilizar como herramientas para obtener información y tomar decisiones acerca del control de calidad, desarrollo de productos, en valoración de riesgos y enfermedades, entre otros (Buchanan y Whiting,1997;Tapia etal.,2000).
Aunque los modelos de Microbiología Predictiva son ampliamente utilizados, presentanciertaslimitaciones:
– Los modelos matemáticos son simplificaciones deprocesos bioquímicos complejosyenalgunoscasosnotodaslas variables o factores que afectan al sistema están incluidos (Buchanan y Whiting, 1997; Alzamora et al., 2005). Por ejemplo, el modelo de Baranyi no toma en cuenta la inhibición del crecimiento microbiano debido a la acumulación de toxinas o limitación de sustratos, los cuales afectan la fase estacionaria de la curva de crecimiento (Lebert y Lebert, 2006). Debe existir un balance en la complejidad de los modelos; ya que en los modelos muy simples, los datos son difíciles de ajustar y los muy complejos, se vuelven inconsistentes(Alzamora etal.,2005).
– Generalmente, los modelos no están obtenidos para las condiciones en las que los microorganismos se presentan en los alimentos puesto que la mayoría de los datos provienen de experimentos realizados en medios de cultivo. Tal es el caso de los microorganismos patógenos, los cuales son más resistentes en los alimentos que en los medios de cultivos (Alzamora et al.,2005).
La mayoría de los modelos describen cambios en el comportamiento
–microbiano para poblaciones homogéneas, sin embargo, en los sistemas de alimentos existe una mezcla de microorganismos que debido a sus interacciones se comportan de una maneradiferente(LebertyLebert,2006).
Algunos modelos, como el de la Raíz Cuadrada de Ratwosky, se ajustan a los comportamientos lineales, sin embargo, cuando se involucran dos o más factores es necesario hacer una revisión de los parámetros del modelo. Los modelos de Superficie de Respuesta (Gamma o de Rosso) describen el crecimiento microbianoparamásdeunfactor,peroes necesario suponer que los parámetros biológicos son independientes y sólo funcionan dentro de los rangos para los que el experimento fue diseñado, por lo cual la extrapolación no es posible (LebertyLebert,2006).
– Por otro lado, la exactitud del modelo dependedelacalidaddelosdatos ydela estandarización del método estadístico y experimental (Buchanan y Whiting, 1997; Alzamora et al., 2005; Marks, 2008).
–
Finalmente, la inexactitud de las predicciones se debe a que los modelos predicen el comportamiento microbiano desde un punto de vista aislado. Para poder tener un panorama más completo sobre la seguridad microbiológica de los alimentos, es necesario integrar el comportamiento microbiano dinámico (modelos de MP), las condiciones fluctuantes dentro del sistema (termodinámica de los alimentos) y los modelos que describen el procesamiento de alimentos (transferencia de calor y masa) (Van Impe et al., 2005; Lebert y Lebert, 2006; Marks, 2008). Existen dos modelos que describen el comportamiento de los microorganismos desde un punto de vista global: El modelo de Van Impe (Van Impe et al.,
2005) y el Modelo Integrado propuesto por(LebertyLebert,2006).
A pesar de los esfuerzos por predecir el comportamiento microbiano desde una perspectivaglobal,lassolucionessonpocasy complejas; ya que es necesario hacer suposiciones y validar cada parte del modelo por separado antes de ser usadas como modelointegrado(LebertyLebert,2006).
Por las razones arriba mencionadas, es importante seguir explorando e investigando otras posibilidades para integrar y validar todas las partes involucradas en la inocuidad alimentaria, por lo tanto, el enfoque de Dinámica de Sistemas podría ser una respuestaadichainquietud.
DinámicadeSistemas
El enfoque de la Dinámica de Sistemas se desarrolló a finales de los años 50 por Jay Forrester. En un principio, el método se llamó Dinámica Industrial y estaba enfocada al área de administración. Actualmente, la Dinámica de Sistemas puede aplicarse a diferentes contextos, incluyendo la modelación en las áreas de la salud y biológicas, ambientales, educación, entre otras (Richardson y Pugh, 1981; Gallaher, 1996).
La Dinámica de Sistemas es una metodología que se ocupa de estudiar “sistemas dinámicos de retroalimentación” (Richardson y Pugh, 1981). Un sistema dinámico (problema dinámico) puede ser cualquier situación que involucre cambios en el tiempo, en donde la retroalimentación está dada por las interacciones entre los componentes del sistema. La retroalimentación es un proceso en el cual, parte de la información que sale del sistema regresa al mismo, modificando su comportamientoatravésdeltiempo.
G. G. Gastélum-Reynoso etal. / Temas Selectos de Ingeniería de Alimentos 2 – 2 (2008): 27 – 40
Durante el proceso de modelación con la Dinámica de Sistemas, se analizan la dinámica del problema, definida por los cambios en el tiempo -expresados en gráficas- y la estructura del problema, representada matemáticamente por sistemas de ecuaciones diferenciales y gráficamente por diagramas “causales” y de “flujos y niveles”.
Dinámica o comportamiento del problema. “La estructura de retroalimentación de un sistema genera su comportamiento o dinámica” (Sterman, 2000). Para analizar la estructura de un sistema, es preciso descomponerlo en sus partes y ver cómo influyen unas sobre otras. Estas interacciones pueden ser positivas o negativas y reflejan el tipo de retroalimentación que está recibiendo el sistema (Aracil, 1995). Los diagramas “causales”, describen dichas interacciones comolomuestranlasFigs.1y2.
El comportamiento del sistema (formas básicas de comportamiento) va de la mano con los procesos simples de retroalimentación que lo generan. Existen tresformasbásicasdecomportamiento:
Crecimiento exponencial: Es un comportamiento que surge debido a la retroalimentación positiva y está asociado con crecimiento, aceleración o desestabilización del sistema. Ver Fig. 3
(Aracil,1995;Luna-Reyes,2008).
Estabilización o balance: La retroalimentación negativatiendeabalancear lasituación mediantelaresistenciaal cambio o estabilización del comportamiento de acuerdo a un objetivo determinado. Si por alguna acción externa el sistema es desestabilizado, se comparan el estado actual del sistemacon el estado deseado ysetoman acciones correctivas tal como lo muestra la Fig. 4 (Aracil, 1995; Sterman, 2000; LunaReyes,2008).
Oscilatorio: El comportamiento oscilatorio también es causado por retroalimentación negativa, sin embargo el efecto de los componentes sobre el sistema no es inmediato, es decir presenta retrasos en el tiempo (Fig.5). Los retrasos ocasionan que las acciones correctivas continúen aún cuando el sistema ha llegado a su estado de equilibrio y éste en consecuencia, responde con una nueva acción pero en sentido contrario(Aracil,1995;Sterman,2000).
Muchosdelossistemasenlavidarealson el resultado de una o más interacciones no lineales de las tres formas básicas de comportamiento (Sterman, 2000). Una de las más comunes es la del crecimiento sigmoidal. Este tipo de comportamiento involucra un ciclo de retroalimentación positiva junto con un ciclo de retroalimentación negativa (Fig.6). La forma

G. G. Gastélum-Reynoso etal. / Temas Selectos de Ingeniería de Alimentos 2 – 2 (2008): 27 – 40

Fig. 2. Diagrama “causal” de un ciclo de retroalimentación negativa (Aracil, 1995)

Fig. 3. Estructura de retroalimentación positiva (a). Comportamiento del sistema en forma de crecimiento exponencial (b) (Aracil, 1995)

Fig. 4. Estructura de retroalimentación negativa (a). Comportamiento de balance o estabilización del sistema (b) (Aracil, 1995)

Fig. 5. Estructura de retroalimentación negativa con retrasos en el tiempo. Comportamiento oscilatorio (Aracil, 1995)

Fig. 6. Diagrama “causal” formado por un ciclo de retroalimentación positiva yun ciclo de retroalimentación negativa (Aracil, 1995)

Fig. 7. Comportamiento sigmoidal. T1 ciclo de retroalimentación positiva. T2 ciclo de retroalimentación negativa o de balance (Aracil, 1995)
de la curva es de una S alargada como se observa en la Fig. 7. Es típico observar un crecimiento exponencial al principio que disminuye gradualmente hastaque el sistema alcanza un estado de equilibrio. El crecimiento exponencial es debido a que los ciclos positivos predominan hasta que los límites de crecimiento se alcanzan, entonces los ciclos negativos empiezan a dominar el comportamiento del sistema. El punto de inflexión determina el cambio en estos dos ciclos. Generalmente, el crecimiento en forma de Sse da cuando los ciclos negativos no presentan retrasos significativos en el tiempo yen donde las interacciones entre los ciclos positivos y negativos no son lineales (Sterman,2000).
Estructura del problema: El proceso de modelación en Dinámica deSistemas analiza la dinámica o comportamiento del problema y es representada por diagramas “causales” los cuales son muyútiles para tener una idea
general del comportamiento del sistema y ponen de manifiesto las interdependencias y retroalimentaciones de un sistema; sin embargo, presentan ciertas limitaciones. Es por eso que la estructura del sistema conviene describirla por medio de diagramas de “flujos y niveles” los cuales están asociados a ecuaciones diferenciales. Estos, además de describir los procesos de retroalimentación, proveen información acerca de las acumulaciones y flujos del sistema.
Como se describe en la Fig. 8, las acumulaciones en el sistema (niveles de las variables) se representan por medio de rectángulos, simulando contenedores. El nivel de la variable (acumulación) cambia debidoalosflujosdeentradaodesalida.Los flujos de las variables, describen las actividades del sistema, para nombrarlas se utilizan verbos yse representan gráficamente con flechas (tuberías) que entran o salen de
los niveles de las variables del sistema. Las válvulas controlan los flujos. Las nubes indican los límites del sistema. Los círculos representan constantes o valores que derivan de otras variables fuera del sistema (Richardson y Pugh, 1981; Gallaher, 1996; Luna-Reyes,2008).
Desarrollo de un modelo de Dinámica de Sistemas: El enfoque de Dinámica de Sistemas se basa en los siguientes principios (Richardson y Pugh, 1981; Sterman, 2000; Shelley et al.,2001):
1. Definicióndelproblema:Enestaetapase consideran varios aspectos: la selección del problema, la selección de las variables claves, los modos de referencia y el horizonte del tiempo. Como primer paso se define cuál es el problema, por quées unproblema ycuáleselpropósito del modelo. Después se establece qué variables son relevantes y deben ser incluidas en el modelo. Los modos de referencia son patrones de comportamiento a través del tiempo, que explican por medio de gráficas y otros datos, cómo surgió el problema y cómo se comportará en el futuro. El horizonte del tiempo determina qué tan hacia atrás y hacia delante se debe considerar el problema. Por un lado, el pasado ayuda a entender cómo nace el problema y por otro el otro, el ir lo suficientemente lejos en el futuro permite observar el
fenómeno causa-efecto, el cual en los sistemas dinámicos no es inmediato. Tanto los modos de referencia como el horizonte de tiempo, ayudan a escoger la información (variables, flujos, límites, etc.) necesaria para definir el problema dinámicamente.
2. Formulación de la hipótesis dinámica: Es la descripción gráfica o verbal del problema (sistema) tomando en cuenta el comportamiento de la estructura y sus procesosderetroalimentaciónendógenaa través del tiempo. Los diagramas de subsistemas, las tablas de límites del modelo, los diagramas “causales”, los diagramas de “flujos y niveles” entre otros, son algunas herramientas que ayudanadescribirlahipótesisinicial,sus variables claves, modos de referencia, etc.
3. Formulacióndelmodelo:Cuandosetiene definido un modelo, el siguiente paso es probarlo, ya sea mediante experimentos enunsistemarealoenelmodelomismo, es decir, se debe formalizar el modelo conecuaciones,parámetrosycondiciones iniciales. Al mismo tiempo, es una forma de encontrar inconsistencias dentro del modeloyprobarlahipótesisinicial.
4. Pruebas de Validación del modelo: Se llevan a cabo para probar si el modelo es confiable,esdecir,si las prediccionesdel modelo son consistentes con el comportamiento real del sistema; si se ajusta a la realidad (Richardson y Pugh,
G. G. Gastélum-Reynoso etal. / Temas Selectos de Ingeniería de Alimentos 2 – 2 (2008): 27 – 40
1981).Debenvalidarsetantolaestructura comoelcomportamientodelsistema.
5. Reglas del modelo: Después de que el modelo se ha probado, se puede reajustar, utilizando las reglas y fórmulas del mismo con el fin de mejorar el comportamientodelsistemareal.
La Dinámica de Sistemas como herramienta enMicrobiologíaPredictiva
En el área de microbiología existen sistemas complejos, como el crecimiento, supervivencia y muerte de poblaciones microbianas, las cuales pueden encontrarse en medios de cultivo, sistemas modelo o los alimentos mismos. Por ejemplo, algunos microbiólogos describen a los alimentos como ecosistemas complejos que están formados por un “ambiente” representado por los componentes del alimento (pH,
actividad de agua, nutrientes, solutos, etc.) y por los microorganismos los cuales pueden crecer en el alimento (Montville, 1997). La habilidad del microorganismo para crecer, sobrevivir o morir depende de las tasas de crecimiento ymuerte,las cualesdependende factores como actividad de agua, pH, temperatura, concentración de antimicrobiano, las características del microorganismo, etc. Las interacciones entre estos factores pueden representarse a través de los ciclos de retroalimentación positiva o negativa.
El siguiente es un ejemplo de un modelo de inactivación térmica para bacterias. En este caso el modelo predice el número de bacterias, muertes, nacimientos y la viabilidad celular para dos condiciones diferentesdetemperatura.


G. G. Gastélum-Reynoso etal. / Temas Selectos de Ingeniería de Alimentos 2 – 2 (2008): 27 – 40
Como primer paso para construir el modelo dinámico, se debe definir la dinámica del problema siguiendo los pasos 1 y 2 para el desarrollo de un modelo dinámico. En este caso, la definición del problema está expresada como la inactivación del crecimiento bacteriano por medio de la aplicación de temperatura (25°C y70°C).Despuésseseleccionanlasvariables claves,losmodosdereferenciayelhorizonte del tiempo. Las variables claves son la acumulación de bacterias y la viabilidad celular. La Fig. 9. muestra el horizonte de tiempo expresado como el comportamiento delasbacteriasatravésdel tiempo,endonde se puede observar una curva de tipo sigmoidal. El modo de referencia, está representado en la curva de crecimiento por la fase de muerte bacteriana y en este ejemplo, está dado por el cambio en el comportamiento de las bacterias en el tiempo, durante el tratamiento térmico (Fig. 10).Unavezqueseaplicalatemperaturapor un lapso de 10 min., se espera que el crecimiento bacteriano disminuya hasta cero (efecto bactericida) y no se reestablezca con elpasodeltiempo.
Otra parte importante de la dinámica del problema es identificar las partes de problema y determinar qué tipo de interacciones o retroalimentación existen
entre ellas (ciclos positivos y negativos). El comportamiento bacteriano representado por la Fig. 9. es de tipo sigmoidal, en la cual están involucrados un ciclo de retroalimentación positiva y un ciclo de retroalimentaciónnegativa(VerFig.11).
Una vez que se han desarrollado los diagramas “causales” y se ha definido el comportamiento del problema, se debe dar formalidad al modelo definiendo la estructura del problema (pasos 2 y 3 del desarrollo de un modelo de DS) utilizando el diagrama de “flujos y niveles”. En la Fig. 12 semuestra el modelo de inactivación térmica bacteriana representado con un diagrama de “flujos y niveles” realizado con el software Stella® research (versión 7.0.1., altura sofwareinc.Hanover,NH.)
En este ejemplo, existen varios ciclos de retroalimentación positiva y negativa. Para efectos del presente artículo, sólo se mencionarán los dos más significativos (Fig.13):
Ciclo No. 1. El número de bacterias (acumulación1)dependedelasbacterias que nacen y de las que mueren. Este comportamiento se describe con dos ciclos de retroalimentación uno positivo y otro negativo, los cuales interactúan entre sí. A

Fig. 11. Diagrama “causal” de inactivación térmica para bacterias formado por un ciclo de retroalimentación positiva yun ciclo de retroalimentación negativa.
vitalidad celular promedio
energía necesaria para la reproducción
Efecto de la disponibilidad de energía en la reproducción
tasa de reproduccion efectiva
energía disponible de reproducción
Energía disponible
Vitalidad deseada
Fracción de energía para regeneración
energía disponible de regeneración
Tasa máxima de muerte
Tasa máxima de reproducción
bacterias
Efectividad del uso de energía 1 2
naciendo
vitalidad celular promedio
viabilidad celular
reforzando
vitalidad de las nuevas células
regenerando
Tasa de muerte efectiva
muriendo
Efecto de la viabilidad celular en la tasa de muerte
deteriorando por muerte
deteriorando por tratamiento
viabilidad mínima
Temperatura efectiva
Tiempo de ajuste de temperatura
Duración
Efecto de la temperatura en el deterioro de la vitalidad
Temperatura ambiente
Temperatura deseada
Fig. 12. Modelo de Dinámica de Sistemas para inactivación térmica de bacterias. La estructura del sistema está representada por un diagrama de “flujos yniveles”
mayor número de nacimientos, mayor acumulacióndebacterias.Estees un ciclode retroalimentaciónpositivayaquecuandouna de las condiciones aumenta, la otra también aumenta. Sin embargo, cuando el sistema se satura es decir, hay sobre población y acumulación de sustancias tóxicas, las bacteriasempiezanamorir,presentándoseun ciclo de balance o de retroalimentación negativa,conlocualalaumentarlasmuertes, disminuye el número de bacterias (Fig. 13). Los flujos que afectan la acumulación de bacterias son naciendo y muriendo. La Tabla 1 muestra las ecuaciones que definen a las acumulacionesylosflujos.
Ciclo No. 2. En este ciclo, el número de bacterias depende de la viabilidad celular (acumulación 2); de esta forma, cuando disminuye la viabilidad celular disminuye la acumulación de bacterias por lo tanto, la
Intensidad
retroalimentación es positiva (ciclo de refuerzo).
La viabilidad celular se ve afectada por la temperatura del tratamiento (temperatura efectiva). Al aumentar la temperatura, disminuye la viabilidad celular, la cual aumenta la tasa de muerte efectiva produciendo más muertes que llevan a un mayor deterioramiento de viabilidad celular (ver Fig. 13). Los flujos que afectan la viabilidad celular se definen en la Tabla 1 y son reforzando la viabilidad, deteriorando la viabilidad por muerte natural, deteriorando la viabilidad por tratamiento térmico y regenerandolaviabilidadcelular.
La aplicación del modelo: Un ejemplo muy sencillo demuestra que el modelo desarrolladoconlametodologíadeDinámica de Sistemas, reproduce el comportamiento
naciendo reforzando
regenerando
bacterias
Tasa de muerte efectiva
muriendo
viabilidad celular promedio
viabilidad celular
deteriorando por muerte
deteriorando por tratamiento
Temperatura Efectiva
Efecto de la temperatura en la viabilidad
Fig. 13. Ciclos de la acumulación de bacterias (1) yde viabilidad celular (2).
esperado de una bacteria mesófila (temperatura óptima de crecimiento entre 25 y 40°C). La bacteria fue sometida a dos condiciones de temperatura diferentes: la primerasellevaacaboa25°Cylasegundaa 70°C, ambas temperaturas se mantuvieron durante 10 min. La Figura 14 muestra que a 25°C el número de bacterias y la viabilidad celular permanecieron altas y ambas corresponden con los valores de los
nacimientos los cuales superan a las muertes alfinaldeltratamiento(10min.).Despuésdel tratamiento las bacterias se siguen reproduciendo puesto que la temperatura aplicada está dentro del rango de la temperaturaóptimadecrecimiento.
Cuando se aplica el tratamiento térmico a 70°C se observa la inhibición bacteriana (Fig.15). Durante el primer minuto, los
Tabla I Ecuaciones del modelo de inactivación térmica de bacterias a bacterias(t) = bacterias(t - dt) + (naciendo - muriendo) * dt
INFLOWS: naciendo = tasa_de__reproduccion__efectiva*bacterias
OUTFLOWS: muriendo = Tasa_de_muerte_efectiva*bacterias
vitalidad_celular(t) = vitalidad_celular(t - dt) + (reforzando + regenerando_ - deteriorando_por_muerte - deteriorando_por_tratamiento) * INFLOWS: reforzando = naciendo*vitalidad_de_las_nuevas_células regenerando_ = Efectividad_del_uso_de_energía*energía_disponible_de_regeneración
OUTFLOWS:
deteriorando_por_muerte = muriendo*vitalidad_celular_promedio deteriorando_por_tratamiento = vitalidad_celular*Efecto_de_la_temperatura__en_el_deterioro_de_la_vitalidad
Duración = 10
Tasa_de_muerte_efectiva = Efecto_de_la_vitalidad_celular_en_la_tasa_de_muerte*Tasa_máxima_de_muerte
Temperatura_ambiente = 25
Temperatura_efectiva = SMTH1(Temperatura_deseada,Tiempo_de__ajuste_de_temperatura,Temperatura_ambiente) a software: Stella 7.0.1
14. Tratamiento térmico a 25°C. (1) Número de bacterias, (2) muertes, (3) nacimientos, (4)viabilidad celular
Fig. 15. Tratamiento térmico a 70°C. (1) Número de bacterias, (2) muertes, (3) nacimientos, (4)viabilidad celular
nacimientos disminuyen al igual que la viabilidad celular y el número de bacterias. Después de los 10 min. del tratamiento las bacterias son incapaces de reproducirse. Estos resultados hablan de que por arriba de la temperatura óptima de crecimiento existe inhibición del crecimiento o muerte bacteriana.
En este sentido, la Dinámica de Sistemas es una herramienta potencial para simular y modelar el comportamiento microbiano bajo un enfoque integral utilizando interfaces gráficas vinculadas auna seriede ecuaciones las cuales describen cuantitativamente el modelo(Gallaher,1996).
Conclusiones
Los alimentos son sistemas cuyo comportamiento e interacciones con microorganismos y/o con procesos, pueden ser representados mediante modelos matemáticos. La Microbiología Predictiva ha desarrollado varios modelos que describen y predicen el comportamiento microbiano dentro de estos sistemas. Desafortunadamente, algunos de estos modelos presentan limitaciones para modelar o predecir el comportamiento de todas las variables o del sistema como un todo. La
G. G. Gastélum-Reynoso etal. / Temas Selectos de Ingeniería de Alimentos 2 – 2 (2008): 27 – 40
metodología de la Dinámica de Sistemas podría ser una alternativa para simular y predecir el comportamiento de los microorganismos en alimentos ya que describe al sistema con ecuaciones algebraicas simples y de manera gráfica; usando herramientas como los diagramas “causales”yde“flujosyniveles”.
of research on public information technology, Hershey, PA. pp. 476-492.
Marks, B. P. 2008. Status of microbial modeling in food process models. Comprenhensive Reviews in FoodScienceandFoodSafety. 7(1): 137-143.
Martínez, A., Rodrigo, M., Rodrigo, D., Ruiz, P., Martínez, A. y Ocio, M. J. 2005. Predictive microbiology and role in food safety systems. En: G. Barbosa-Cánovas, M. S. Tapia y P. M. Cano (Eds.). Novel food processing technologies. Boca Ratón, Florida. pp. 579-590.
Referencias
Alzamora, S. M., Guerrero, S., Viollaz, P. y WeltiChanes, J. 2005. Experimental protocols for modeling the response of microbial populations exposed to emerging technologies: Some points of concern. En: G. Barbosa-Cánovas, M. S. Tapia y P. M. Cano (Eds.). Novel food processing technologies. Boca Ratón, Fl. pp. 591-627.
Alzamora, S. M., Tapia, M. S. y López-Malo, A. 2000. Overview. En: S. M. Alzamora, M. S. Tapia y A. López-Malo (Eds.). Minimally processed fruits and vegetables. Fundamental aspects and applications. Gaithersburg, Maryland. pp. 1-9.
Aracil, J. 1995. Dinámica de Sistemas. Madrid, España. pp. 8-49.
Betts, G. y Everis, L. 2005. Modeling systems and impact on food mircrobiology. En: G. BarbosaCánovas, M. S. Tapia y P. M. Cano (Eds.). Novel foodprocessingtechnologies. Boca Ratón, Florida. pp. 555-578.
Buchanan, R. L. y Whiting, R. C. 1997. Predictive modeling. En: M. P. Doyle, L. R. Beuchat y T. J. Montville (Eds.). Food microbiology fundamentals and frontiers. Washington, D.C. pp. 728-739.
Gallaher, E. J. 1996. Biological system dynamics: From personal discovery to universal application. Simulation. 66(4): 243-257.
Lebert, I. y Lebert, A. 2006. Quantitative prediction of microbial behaviour during food processing using an integrated modelling approach: a Review. International Journal of Refrigeration. 29: 968984.
Luna-Reyes, L. F. 2008. System Dynamics to understand public information technology. En: G. D. Garson y M. Khosrow-Pour (Eds.). Handbook
Mcleroy, D. M., Jaykus, L. y Foegeding, P. M. 2000 Validation and analysis of modeled predictions of growth of Bacillus cereus spores in boiled rice. JournalofFoodProtection. 63(2): 268-272.
Montville, T. J. 1997. Principles which influence microbial growth,survival,and death in foods. En: M. P. Doyle, L. R. Beuchat y T. J. Montville (Eds.). Food microbiology. Fundamentals and frontiers. Washington, D.C. pp. 13-29.
Richardson, G. P. y Pugh, A. L. 1981. Introduction to system dynamics modeling with DYNAMO. Portland, Oregon.
Shelley, M. L., Nixon, W. B. y Bleckman, C. A. 2001. The challenge of pursuing system dynamics approach in analyzing complex natural systems: Example of solid waste landfills. Paper presented at the 19th International Conference of the System DynamicsSociety.Atlanta,Georgia.USA.
Sterman, J. D. 2000. Business dynamics. Systems thinking and modeling for a complex world. Boston.
Tapia, M. S., Martínez, A. y Díaz, R. V. 2000. Tools for safety control: HACCP, risk assessment, predictive microbiology, and challenge tests. . En: S. M. Alzamora, M. S. Tapia y A. López-Malo (Eds.). Minimally processed fruits and vegetables. Fundamental aspects and applications Gaithersburg, Maryland. pp. 79-97.
Van Impe, J. F., Poschet, F., Geeraerd, A. H. y Vereecken, K. M. 2005. Towards a novel class of predictive microbial growth models. Int. J. Food Microbiol. 100: 97-105.

Temas Selectos de Ingeniería de Alimentos 2 – 2 (2008): 41 – 51
Mecanismos de acción antimicrobiana de timol y carvacrol sobre microorganismos de interés en alimentos
R. M. García-García *, E. Palou-García
DepartamentodeIngenieríaQuímicayAlimentos,UniversidaddelasAméricas–Puebla.
SanAndrésCholula,Pue.,México.
Resumen
Existe actualmente una gran variedad de agentes antimicrobianos que se utilizan para la conservación de alimentos; sin embargo, la demanda de los consumidores por adquirir productos alimenticios con ingredientes lo más naturales posibles, ha llevado a la investigación de sustancias naturales que posean actividad antimicrobiana contra microorganismos de interés en alimentos. Entre estas sustancias se encuentran el carvacrol y el timol, los cuales provienen de especias como el orégano y el tomillo, contando con un gran poder antimicrobiano. Para conocer su funcionamiento es importante conocer sus mecanismos de acción dentro de la célula microbiana, con el objetivo de ser utilizados de manera segura y confiable en la elaboración de alimentos. En este artículo se hace una revisión de los mecanismos de acción de carvacrol y timol en diferentes microorganismos de importancia en alimentos, permitiendo conocer sus alcances y limitaciones.
Palabras clave: agentes antimicrobianos, carvacrol, timol, mecanismos de acción.
Abstract
There is a great variety of natural and synthetic antimicrobial agents which are used for food preservation; nevertheless the demand of the consumers to acquire nutritional products with ingredients as natural as possible has taken to the investigation of natural substances that have antimicrobial activity against microorganisms of interest in foods. Among these substances are carvacrol and timol, which come from spices like oregano and thyme and have great antimicrobial power. In order to be able to know their operation it is important to know their mechanisms of action within the microorganism’s cell with the objective to be used in a safe and reliable way in foods. This article presents a review of the mechanisms of action of carvacrol and tymol against different microorganisms of importance in foods as well as their limits of both as microbian agents.
Keywords: antimicrobial agents, carvacrol, thymol, mechanisms of action.
Introducción
La inocuidad de los alimentos se incrementa y garantiza con el uso de compuestos llamados antimicrobianos (Davidson, 1997), ya que estas sustancias se añaden a los alimentos para prevenir el crecimiento de microorganismos patógenos y deteriorativos; sin embargo, la demanda de los Temas Selectos de Ingeniería de Alimentos
* Programa de Doctorado en Ciencia de Alimentos
Tel.: +52 222 229 2126, fax: +52 222 229 2727
Direccion electrónica: grebecag@yahoo.com.mx
M.
consumidores por adquirir compuestos más naturales y sin tantos conservadores químicos ha hecho que aumente la investigación y el uso de agentes antimicrobianos naturales. Dentro de éstos, los más estudiados son los que se encuentran presentes en hierbas y especias, a partir de las cuales se pueden extraer aceites esenciales que poseen actividad antimicrobiana(Ultee et al., 1998).
Entre las sustancias activas presentes en los aceites esenciales de hierbas y especias, se encuentran diversos compuestos fenólicos como es el caso del carvacrol y el timol, que poseen actividad antifúngica y antibacteriana. Estos compuestos han sido probados en diferentes microorganismos de importancia en alimentos como por ejemplo: Fusarium spp., Aspergillusspp., Rhizobiumleguminosarum, Escherichiacoli, Pseudomonasaeruginosa, Salmonella thiphymurium, Staphylococcusaureus, Bacillus subtilis, Vibrio vulnificus, y Bacilluscereus, entre otros (Ultee et al., 1998).
En específico, los estudios demuestran que carvacrol y timol tienen varios sitios de acción dentro de las células y dependiendo de las concentraciones utilizadas pueden causar la inhibición o inactivación de los microorganismos (Eklund, 1989). Los blancos o puntos de ataque de estos agentes antimicrobianos dentro de las células incluyen la pared y membrana celular, enzimas metabólicas, síntesis de proteínas y sistemagenético(DavidsonyBranen,1993).
En este trabajo se realizó una investigación bibliográfica sobre el mecanismo de acción de los agentes antimicrobianos timol y carvacrol de manera individual, así como de sus mezclas sobre microorganismos de interés en alimentos, para conocer de manera específica sus efectos,ventajasylimitaciones.
(2008): 41 – 51
Revisiónbibliográfica
Agentes antimicrobianos
Los agentes antimicrobianos son compuestos químicos presentes o añadidos en los alimentos que retardan el crecimiento microbiano o causan la muerte de los microorganismos (López-Malo et al., 2000). Muchos de los agentes antimicrobianos producidos actualmente en forma sintética se encuentran también en forma natural como componentes de ciertos alimentos. Estos compuestos químicos con acción antimicrobiana pueden clasificarse como aditivos tradicionales con acción directa o indirecta. Entre los aditivos antimicrobianos con acción directa aprobados para ser utilizados en alimentos se incluyen nitratos y nitritos,sorbatos,benzoatosasícomoésteres, fenoles, ácidos orgánicos y sus derivados. Los agentes antimicrobianos con acción indirecta son sustancias químicas añadidas con otros objetivos diferentes a la acción antimicrobiana, como por ejemplo fosfatos y antioxidantes fenólicos (Davidsony Branen, 1993).
Algunos antimicrobianos sintetizados químicamente reconocidos como GRAS (GenerallyRecognized as Safe) por la FDA (Foodand Drug Administration)son: ácido propiónico y propionatos, ácido sórbico y sorbatos, ácido benzoico y benzoatos, parabenos, sulfitos, óxido de etileno y propileno, diacetato de sodio, nisina y nitrito desodio,entreotros(Jay,2002).
Entre los antimicrobianos naturales más estudiados se encuentran los presentes en plantas, hierbas y especias, los cuales son utilizados en alimentos tratando de sustituir los antimicrobianos sintéticos, debido a la tendencia de los consumidores por consumir
productoslomásnaturalesposibles(Holleyy Patel,2005).
2 – 2 (2008): 41 – 51
muerte(curvadesupervivencia),enelcualel número de células viables en el medio de


Se reconoce que los compuestos activos de plantas, hierbas y especias son compuestos fenólicos. De acuerdo con Holley y Patel (2005), estos compuestos son probablemente los componentes antimicrobianos mayoritarios presentes en los aceites esenciales de las especias. Bauer et al. (2001) señalaron que el mayor componente puede constituir el 85% del aceite esencial, mientras que otros componentes pueden estar presentes sólo en trazas. Los componentes de algunos aceites esenciales con propiedad antimicrobiana son presentadosenlaTabla1.
La rapidez del efecto bactericida o la duración del efecto bacteriostático de los agentes antimicrobianos puede ser determinada por el análisis de tiempo de
cultivodespués de haber adicionado el aceite esencial es graficado contra el tiempo (Burt, 2004). Así mismo, el daño ocasionado a la pared celular y la pérdida del contenido celular puede ser estudiado por microscopia electrónica(Lambert et al.,2001).
Mecanismos generales de acción de los agentesantimicrobianos naturales
Los aceites y extractos de plantas, principalmente de clavo, orégano, tomillo y algunos otros, presentan actividad inhibitoria contra ciertos microorganismos de importancia en alimentos (Holley y Patel, 2005). Considerando el gran número de diferentes grupos de compuestos químicos presentes en los aceites esenciales, es importante decir que su actividad antimicrobiana no se atribuye a un
M. García-García etal. / Temas Selectos de
mecanismo específico; sin embargo, existen algunossitiosdeacciónenlacélulaendónde pueden ocurrir los siguientes efectos: daño a la membrana citoplasmática, degradación de la pared celular, daño a las proteínas, filtración del contenido celular, coagulación del citoplasma y disminución de la fuerza motriz(SkandamisyNychas, 2001).
Una característica importante de los componentes de los aceites esenciales es su hidrofobicidad, la cual permite la separación de los lípidos de la membrana celular y la mitocondria, desordenando la estructura y haciéndola más permeable, lo que permite la filtración de iones y otros contenidos celulares (Oosterhaven et al., 1995). Burt et al. (2007), señalaron que al exponer las células a concentraciones subletales de agentes antimicrobianos naturales (como carvacrol y timol), hay cambios en la concentración de los ácidos grasos de la membrana celular, presentándose un aumentodelosácidosgrasosinsaturados.
La estructura química de los componentes individuales de los aceites esenciales afecta su modo preciso de acción y su actividad antimicrobiana. La importancia de la presencia de los grupos hidroxilo en los compuestos fenólicos ha sido confirmada (Dorman y Deans, 2000).Hay estudios que demuestran los efectos antimicrobianos que ejercen los compuestos aromáticos sobre la membrana citoplasmática, alterando su estructura y por consiguiente su función. Por ejemplo, Enomoto et al (1991) en estudios con E. coli observaron unadisminución en el potencialdemembranaalexponerlascélulas microbianas a algunos compuestos aromáticos como eugenol ycarvacrol. Walsh et al. (2003), reportaron al realizar estudios contimol,eugenol ytriclocarbón (TCC),que los dos primeros agentes antimicrobianos presentaban efecto bactericida contra microorganismos Gram negativos y positivos, provocando daño en la membrana
de Alimentos 2 – 2 (2008): 41 – 51
celular y salida de los componentes intracelulares, sin embargo, TCC no provocó efectosletalesenlascélulas.
Generalmente, el flujo de iones potasio es una muestra temprana del daño a la membranacitoplasmática yesseguidoporel flujo de los demás constituyentes citoplasmáticos (Ultee et al., 2002). La pérdida de la permeabilidad de la membrana es identificada como causa de la muerte celular ydepende de la hidrofobicidad de los solutos que cruzan la membrana y de la composición de la misma. El coeficiente de partición de los aceites esenciales en las membranas celulares es un determinante crucial para su efectividad, por lo que se esperan variaciones cuantitativas en la actividad de los agentes antimicrobianos contra diferentes bacterias (Lambert et al., 2001).Algunasinvestigacionesseñalanquela pérdida de la funcionalidad de la membrana es sólo una parte de la explicación de la actividad antimicrobiana que presentan dichosagentes(Burt,2004).
Los componentes delos aceites esenciales tambiénparecenactuarsobrelasproteínasde lascélulasqueseencuentranembebidasenla membrana citoplasmática. Las enzimas ATPasas que se encuentran localizadas en dicha membrana pueden ser alcanzadas por las moléculas lipídicas, viéndose afectada la regulación de energía y la síntesis de componentes estructurales (Elgayyar et al., 2001).
Los componentes de los aceites esenciales, básicamente timol, carvacrol y eugenol, los cuales son compuestos fenólicos, poseen fuertes propiedades antimicrobianas contra diversos microorganismos de interés en alimentos (Lambert et al., 2001) y es razonable pensar que su mecanismo de acción es similar al de otros compuestos fenólicos, provocando desorden en la membrana citoplasmática,
rompimiento de la fuerza motriz del protón, flujo de electrones y coagulación del contenidocelular(Davidson,1997).Además, a diferencia de muchos antibióticos, los constituyentes hidrofóbicos de los aceites esenciales son capaces de entrar en el periplasma de las bacteria Gram negativas a través de las proteínas de la membrana externa(Lambert etal.,2001).
Conner yBeuchat (1984)señalaron quela actividad antimicrobiana de los aceites esenciales en levaduras se debe al daño ocasionado a algunos sistemas enzimáticos involucrados con la producción de energía y síntesis de componentes estructurales. Algunos compuestos fenólicos cruzan la membranacitoplasmáticaeinteraccionancon proteínas y enzimas de membrana, causando un flujo opuesto de protones afectando la actividadcelular.
Carvacrol
Carvacrol (o 2-metil-5-(1-metiletil) fenol) está presente en los aceites esenciales de orégano (entre 60-70%) y tomillo (en un 45%) (Ultee et al., 2002).Su estructura química está representada por un grupo fenólico (Fig. 1), con un alto poder hidrofóbico. De todos los agentes antimicrobianos naturales, carvacrol es uno de los que más atención ha recibido en su mecanismo de acción; es capaz de desintegrar la membrana externa de las bacterias Gram negativas, permitiendo la salida de lipopolisacáridos e incrementando la permeabilidad de la membrana citoplasmática (Lambert et al., 2001), provocando con ello la salida del ATP, inhibición de la actividad de las ATPasas y disminución de la fuerza motriz del protón (Burt etal.,2007).
De acuerdo con Ultee et al. (2000), en general se pueden distinguir tres fases físicas de las membranas celulares: una bicapa en
fase gel (cadena de lípidos ordenada), una bicapa en fase líquida-cristalina (cadena de lípidos desordenada) y una estructura hexagonal. Para una funcionalidad biológica

Fig. 1. Estructura química de carvacrol (Lopéz –Malo, 2000)
óptima, la membrana debe mantenerse en estado fluido líquido cristalino y la temperatura de transición (Tm) de la fase gel a la líquida-cristalina constituye la principal influencia sobre la flexibilidad y estabilidad de la membrana. Por lo que la actividad antimicrobiana del carvacrol probablemente tiene efectos sobre dichas propiedades. Es importante mencionar que cuando la concentración de carvacrol aumenta, mayor cantidad de este componente es acumulado en la membrana y por consiguiente el daño en la membrana es mayor (Ultee et al., 2000).
Estudios con B. cereus han demostrado que el carvacrol interactúa con la membrana celular disolviéndose en la bicapafosfolipídica, alineándose entre las cadenas de ácidos grasos. Esta distorsión de laestructurafísicapuede causarla expansión y desestabilización de la membrana, incrementando la fluidez de la misma, provocando un aumento en la permeabilidad (Ultee et al.,2002).
R. M. García-García etal. / Temas Selectos de
Las mediciones del potencial de membrana de las células de B. cereus en la fase exponencial de crecimiento, revelan una fuerte disminución en el momento de adicionar el carvacrol, lo que indica una debilitación de la fuerza motriz del protón. Además, los niveles intracelulares de iones potasio disminuyen mientras que los niveles extracelulares aumentan proporcionalmente (Ultee et al., 2000). Esta manera de actuar, lleva a pensar que el carvacrol forma canales através dela membrana por laseparación de las cadenas de ácidos grasos de los fosfolípidos, permitiendo que los iones dejen elcitoplasma(Ultee etal., 2002).
Por otra parte, también es importante conocerelefectodecarvacrolsobrelatoxina generada por B. cereus. Los estudios realizados porUlteeySmid(2001)señalaron que la lisis celular provocada por carvacrol se lleva a cabo en la fase estacionaria. Sin embargo, la producción de la enterotoxina iniciaenlafaseexponencialobteniéndoselos niveles máximos en la fase estacionaria; por lo que la lisis celular afecta los niveles finales de toxina, ya que son liberadas las proteasas yéstas degradan las proteínas dela enterotoxina. Durante la exposición de las células de B. cereus al carvacrol, la energía para la óptima secreción de la toxina no es suficiente, resultando en una acumulación de la misma en el interior de la célula y consecuentemente, la toxina intracelular inhibe su propia síntesis. No obstante, es posiblequeladisminuciónenlavelocidadde crecimiento de la célula inhiba directamente la síntesis de la toxina. La producción de toxina requiere energía metabólica y con la presencia de carvacrol, las células usan su limitada energía para mantenerse viables y no para la producción de toxina (Ultee y Smid,2001).
Estos mismos efectos fueron encontrados por Tassou yNychas (1994) sobre células de Staphylococcus aureus. Sin embargo, estos
de Alimentos 2 – 2 (2008): 41 – 51
autores señalaron que este mecanismo no es válido para todos los microorganismos, ya que el daño ocasionado depende del agente antimicrobiano y del tipo de célula microbiana.
Lambert et al. (2001) mencionaron que carvacrol daña la membrana celular de S. aureus y P. aeruginosa, provocando la disipación de dos componentes de la fuerza motriz del protón: el gradiente de pH y el potencial eléctrico; pudiendo ser mayor el daño a la membrana en presencia de nutrientes, síntesis de ácidos nucleicos y actividad de las enzimas ATPasas, entre otros. Así mismo, Conner et al. (1984) señalaron que carvacrol disminuye la actividad respiratoria de Saccharomyces cerevisiae.
Burt et al.(2007)señalaronquecélulasde E. coli crecenenpresenciadecarvacrolauna concentración 1 mM sin síntesis de flagelos, provocando que el microorganismo crezca sin movilidad; al verse estresada, E. coli utiliza su energía en otras funciones vitales en vez de sintetizar flagelos. Sin embargo, a una concentración 5 mM cesa inmediatamente la movilidad y ocurre la muertecelular.
Timol
El timol (o isopropilmetacresol, o 2isopropil-5-metilfenol) ha sido reportado por varios autores (Falcone et al., 2005; 2007; Lambertet al., 2001), como uno de los agentes antimicrobianos más activo de los constituyentes de los aceites esenciales. Se encuentra presente en el aceite esencial del tomillo(arribadel50%),enelaceiteesencial deloréganoyenotrasfuentesnaturalescomo los aceites naturales de mandarina y tangerina (Falcone et al., 2005).Su estructura química es similar a la del carvacrol cambiando únicamente la posición del grupo hidroxilo(Fig.2).
R. M. García-García
etal. / Temas Selectos de Ingeniería de Alimentos 2 – 2 (2008): 41 – 51
En particular el aceite esencial de tomillo es consideradoGRAS, por lo queel timol no es considerado nocivo para la salud (Falcone et al., 2005).

El mecanismo de acción de timol es semejante al de carvacrol, ya que su estructura química es similar. El timol es capaz de desintegrar la membrana externa de las bacterias Gram negativas, permitiendo la salida de lipopolisacáridos e incrementando la permeabilidad de la membrana citoplasmática(Helander etal., 1998).
Juven et al. (1994) estudiaron el mecanismo de acción de timol contra S. thiphymurium y S. aureus, concluyendo que este agente antimicrobiano une las proteínas hidrofóbicas de la membrana mediante puentes de hidrógeno, cambiando las característicasdepermeabilidaddelamisma. Así también, señalaron que el efecto inhibitorio de timol es mayor a un pH de 5.5 que a 6.5, ya que a bajos valores de pH la molécula del agente antimicrobiano no está disociada, logrando unir mejor las partes hidrofóbicas de las proteínas y, por lo tanto, facilitandoladisolucióndelafaselipídicade lamembrana.
Lambert y Pearson (2000) señalaron que el timol cambia la permeabilidad de la
membrana de las células microbianas, dejando que se filtren los constituyentes químicos que son esenciales para el metabolismo, tales como iones, ATP, ácidos nucleicos y aminoácidos. Estos efectos causan un incremento de la fase lag, provocando una disminución en la carga celulartotal.
Es razonable suponer que las células microbianas formadoras de esporas pueden llegar a ser más resistentes al timol. Sin embargo, Chaibi et al.(1997) confirmaron sobre células de B. cereus y Clostridium botulinum que el timol puede inhibir algunos de los diferentes procesos involucrados en la transición de espora a célula, como la germinación, crecimiento y multiplicación celular. De igual manera, observaron que se requieren concentraciones más altas de timol para suprimir la multiplicación celular que para inhibir la germinación, probablemente por la naturaleza hidrofóbica de las esporas. Así mismo, Falcone et al. (2005) demostraron ensus estudios quelasbacterias ácido lácticas son más resistentes al timol quelasbacteriasformadorasdeesporas.
En los estudios realizados por Falcone et al. (2005) sobre B. cereus, se observa que a concentracionesentre50y250ppmdetimol, elnúmerodemicroorganismosalcanzadosen la fase estacionaria disminuye de manera lineal con el incremento en la concentración del agente antimicrobiano. Así mismo, cuando la concentración es igual o mayor a 500 ppm, no se observa crecimiento, concluyendo que a altas concentraciones de timolelefectoescompletamenteinhibitorio.
Los estudios reportados por Falcone et al. (2005) señalaron que en presencia de timol algunos microorganismos deteriorativos como Lactobacillus curvatus, Lactobacillus plantarum, Pichiasubpelliculosa, Candida lusitaniae y S. cerevisiae, cambian la permeabilidad de su membrana celular
R.
M. García-García
etal. / Temas Selectos de Ingeniería de Alimentos 2 – 2 (2008): 41 – 51
permitiendo la salida de constituyentes químicos esenciales para su metabolismo, provocando un incremento de la fase lag y una disminución en la concentración microbiana de la fase estacionaria. Estos autores realizaron estudios de resistencia con diferentes cepas de Bacillus y Lactobacillus, observando que L. curvatus y L. plantarum presentan mayor resistencia al timol que las cepas de Bacillus. Similarmente, señalan que la susceptibilidad al efecto inhibitorio del timol es mayor en B. subtilis seguido de B. cereus y por último B. licheniformis. En lo concerniente a levaduras, observaron que Candida lusitaniae y Saccharomyces cerevisiae son menos sensibles a la acción deltimolque Pichiasubpelliculosa.
Es importante señalar que la acción antimicrobiana y la sensibilidad al timol es dependiente de ciertos factores como el tipo de microorganismo, pH del medio, y temperatura de incubación (Falcone et al., 2005).
Mezclas de antimicrobianosnaturales
Existen varias razones que llevan a la combinacióndeagentesantimicrobianospara lainhibicióndemicroorganismos.Entreellas se encuentran (Eliopoulos y Mollering, 1991):
1. La probabilidad de que algunas colonias se vuelvan resistentes a algunos agentes antimicrobianos.
2. Algunos agentes sólo se pueden utilizar hasta ciertas concentraciones límites debido a regulaciones existentes, ya que puedencausartoxicidadsiseutilizanpor arribadedichasconcentraciones.
3. La presencia de sinergismo entre agentes.
Las mezclas de antimicrobianos en la industria alimentaria se utilizan con frecuencia; sin embargo, la forma en que
éstos interaccionan para proveer el efecto en contra de los microorganismos no ha quedado claramente dilucidada. Cuando dos antimicrobianos se usan en combinación pueden ocurrir alguna de las siguientes situaciones(Barry,1976):
• Efecto aditivo. En el cual el efecto combinado es igual a la suma de los efectos observados con los dos agentes probados separadamente o es igual al efecto del agente más activo en la mezcla. Los efectos aditivos ocurren cuandolaactividadantimicrobianadeun compuesto no mejora ni se reduce en presenciadeotroagente.
• Efecto sinérgico. En el cual el efecto observado en combinación es mayor a la suma de los efectos observados con los dos agentes de manera independiente. Hay una mayor actividad antimicrobiana.
• Efectoantagónico.Estoocurrecuandola actividad antimicrobiana de un compuestosereduceconlapresenciadel segundoagente.
La evaluación de la combinación de agentes antimicrobianos es necesaria debido aqueunmicroorganismopuedeserresistente a la inhibición y/o eliminación por dosis convencionales de un solo antimicrobiano, pero al ser expuesto a una combinación de agentes se puede vencer su resistencia (EliopoulosyMollering,1991).
Burt y Reinders (2003) propusieron que los aceites esenciales (de orégano, tomillo y clavo, entre otros) ejercen su efecto antimicrobiano sobre los fosfolípidos en la capa externa de la membrana celular de las bacterias, provocando la formación de poros y afectando la permeabilidad de la membrana. Hay algunos mecanismos aceptadossobrelainteracciónantimicrobiana que producen sinergismo; entre ellos se
M. García-García
encuentran: la inhibición de una vía bioquímica, la inhibición de enzimas protectoras, la combinación de agentes activos de la célula y el uso de agentes activos de la célula para aumentar la acción de otros agentes antimicrobianos (Eliopoulos yMollering,1991).
Lambert et al. (2001) reportaron que la mezcla antimicrobiana de carvacrol y timol desintegra la membrana externa de E. coli y S. typhimurium a concentraciones cercanas a las mínimas inhibitorias; así mismo, señalaron que esta misma combinación de agentes antimicrobianos presenta un efecto aditivosobrelainhibiciónde P.aeruginosa y S. aureus permitiendo la fuga de iones fosfato y potasio, provocando problemas en la permeabilidad de la membrana de dichos microorganismos. Por lo que concluyen que carvacrol y timol son permeabilizadores de membrana.
A pesar de que no hay suficiente información sobre el efecto combinado de agentes antimicrobianos naturales en alimentos, Santiesteban-López et al. (2007) señalaronqueunamezclasinérgicaen contra de Listeria innocua incluye 50 ó 100ppmde carvacrol, timol o eugenol con 100 ó 200 ppmdesorbatodepotasio,dependiendodela actividad de agua y del pH del medio. De la misma manera, León (2002) demostró en estudios realizados sobre S. aureus y E. coli, que en medios de cultivo sólidos existen mezclas ternarias sinérgicas de sorbato de potasio,carvacrolytimol.Asímismo,García (2005) al evaluar mezclas ternarias de carvacrol, timol y sorbato de potasio en medios líquidos, reportó de forma general 28 combinaciones sinérgicas, 15 aditivas y 9 antagónicas para inhibir el crecimiento de S. aureus, L. innocua, S. thyphimurium y E. coli, siendo estos dos últimos microorganismos más sensibles a la acción de las mezclas de agentes antimicrobianos quelosprimeros
de
2 – 2 (2008): 41 – 51
Trabajos realizados por Basílico y Basílico (1999), señalaron que la producción de ocratoxina A producida por Aspergillus ochraceus es inhibida con 1000 mg/L de aceite esencial de orégano, que equivale a unamezclade50mg/Ldetimoly250mg/Ll de carvacrol. Así mismo, señalan que Aspergillus niger es inhibido por una mezcla decarvacrolytimola200mg/L.
A pesar de que existen varios estudios sobre mezclas de antimicrobianos, hay poca información sobre el mecanismo de acción de la combinación de agentes en diferentes microorganismos, por lo que es necesario seguir investigando los mecanismos de acción de las mezclas antimicrobianas, para poder utilizar esta alternativa de conservadoresenlaindustriadealimentos.
Conclusiones
El carvacrol y el timol, los cuales están presentes de manera natural en algunas especies como el orégano y el tomillo, presentan actividad antimicrobiana en ciertos microorganismos de interés en alimentos. Básicamente, su mecanismo de acción consiste en cambiar la permeabilidad de la membrana citoplasmática provocando la salida del material intracelular y por consiguiente provocando la muerte de los microorganismos. Estos agentes antimicrobianos son efectivos para inhibir un gran número de microorganismos de interés en alimentos; sin embargo, es necesario seguir profundizando en el conocimiento de su mecanismo de acción para poder utilizarlos de manera segura como conservadores naturales. De igual manera, el uso de las mezclas de agentes antimicrobianos se ve limitada al existir pocos estudios que expliquen sus mecanismos de acción sobre los microorganismos patógenos y deteriorativos.
R. M. García-García etal. / Temas Selectos de Ingeniería de Alimentos 2 – 2 (2008): 41 – 51
Por lo tanto, se recomiendaprofundizar en el mecanismo de acción de las mezclas decarvacrol ytimol, así como desus mezclas con otros agentes antimicrobianos, para entender de manera clara el efecto sinérgico, aditivo o antagónico. A medida que se conozcan los mecanismos de acción de los agentes antimicrobianos y sus mezclas, podrán ser utilizados de mejor manera en la industria de alimentos, logrando cumplir con las exigencias de los consumidores que requieren alimentos más saludables con la menorcantidaddeconservadoresquímicos.
Referencias
Barry, A. L. 1976. The Antimicrobial Susceptibility Test: Principles and Practices. Lea & Febiger.Filadelfia. 335 p.
Basílico, M. Z. y Basílico, J. C. 1999.Inhibitory effects of some spice essential oils on AspergillusochraceusNRRL 3174 growth and ochratoxinA production. Letters in Applied Microbiology. 24(4):238-241.
Bauer, K., Garbe, D. y Surburg, H. 2001. Commonfraganceandflavormaterials: preparation, propiertiesand uses.Wiley-VCH. Weinheim. 293 p.
Burt, S. A. 2004. Essential oils: their antibacterial properties and potential applications in foods-a review. International Journal of Food Microbiology.94:223-253.
Burt, S. A. y Reinders, R. D. 2003. Antibacterial activity of selected plant essential oils against Escherichia coli O157:H7. Letters in Applied Microbiology.36:162-167.
Burt, S. A., Van der Zee, R., Koets, Ad. P., De Graaff, A. M., Van Knapen, F., Gaastra, W., Haagsman, H. y Veldhuizen, J. A. 2007.Carvacrol induces heat shock protein 60 and inhibits synthesis of flagellin in Escherichiacoli O157:H7. Appliedand EnvironmentalMicrobiology.73(14):4484-4490.
Conner, D. E. y Beuchat, L. R. 1984.Effects of essential oils from plants on growth of food spoilage yeast.Journal of Food Science.49:429434.
Conner, D. E.,Beuchat, L. R., Worthington, R. E. y Hitchcock, H. L. 1984.Effects of essential oils and oleoresins of plants on ethanol production, respiration and sporulation of yeast.International JournalofFoodMicrobiology.1:63-74.
Chaibi, A., Ababouch, L. H., Belasri, K., Boucetta, S. y Busta, F. F. 1997. Inhibition of germination and vegetative growth of Bacillus cereus T and Clostridium botulinum 62A spores by essential oils. FoodMicrobioliology.14:161-174.
Davidson, P. M. 1997. Chemical preservatives and natural antimicrobial compounds. En: M. P. Doyle, L. R. Beuchat y T. J. Montville (Eds). Food Microbiology-Fundamentals and Frontiers. ASM Press. Washington D.C. pp. 520-556.
Davidson, P. M. y Branen, A. L. 1993.Antimicrobials in Foods. Marcel Dekker, Inc., New York. pp. 95136.
Dorman, H. J. D. y Deans, S. G. 2000. Antimicrobial agents from plants: antibacterial activity of plant volatile oils. Journal of Applied Microbiology.88:308-316.
Eklund, T. 1989. Organic acids and esters. En: G.W. Gould (Ed). Mechanisms of Action of Food Preservation Procedures. Elsevier Applied Science.Londres. pp. 161 - 200.
Elgayyar, M., Draughon, F. A., Golden, D. A. y Mount, J. R. 2001. Antimicrobial activity of essential oils from plants against selected pathogenic and saprophytic microorganisms. JournalofFoodProtection. 64(4):1019-1024.
Eliopoulos, G. M. y Moellering, R. C. 1991. Antimicrobial combinations. En: V. Lorian (Ed). Antibiotics in Laboratory Medicine TerceraEdición. Williams & Wilkins. Baltimore. pp. 406-432
Enomoto, S., Kashiwayanagi, M. y Kurihara, K. 1991.Liposomes having high sensitivity to odorants. Biochimicaetbiophysycaacta. 1062(11):7-12.
Falcone, P., Mastromatteo, M., Del Nobile, M., Corbo, M. y Sinigaglia M. 2007. Evaluating in vitro antimicrobial activity of thymol toward hygieneindicating and pathogenic bacteria. Journal of FoodProtection. 70(2):425-431.
Falcone, P., Speranza B., Del Nobile, M. A., Corbo, M. R. y Sinigaglia M. 2005. A study on the antimicrobial activity of thymol intended as a
R. M. García-García etal. / Temas Selectos de Ingeniería de Alimentos 2 – 2 (2008): 41 – 51
natural preservative. Journal of Food Protection 68(8):1664-1670.
García, R. M. 2005. Agentesbactericidas / bacteriostáticos a partir de sorbato de potasio, carvacrol y timol. Tesis de Maestría. Universidad de las Américas Puebla. México.
Helander, I. M., Alakomi, H-L., Latva-Kala, K., Mattila-Sandholm, T., Pol, I. Smid, E. J., Gorris, L. G. M. y Wright, A. V. 1998.Characterization of the action of selected essential oil components on Gram-negative bacteria.Journalof Agriculturaland FoodChemistry.46:3590-3595.
Holley. R. y Patel D. 2005. Improvement in shelf-life and safety of perishable foods by plant essentials oils and smoke antimicrobials. Food Microbiology.22:273-292.
Jay, J. 2002. MicrobiologíaModerna de los Alimentos.CuartaEdición. Editorial Acribia, S.A. Zaragoza,España. 239 p.
Juven, B. J., Kanner, J., Schved, F. yWeissolowics, H. 1994. Factors that interact with the antibacterial action of thyme essential oils and its active constituents. Journal of Applied Bacteriology.76:626-631.
Lambert, R. J. W. y Pearson, J. 2000. Susceptibility testing: accurate and reproducible minimum inhibitory concentration (MIC) and non-inhibitory concentration (NIC) values. Journal of Applied Microbiology.88:784-790.
Lambert, R. J. W., Skandamis, P. N., Coote, P. J. y Nychas, G.J.E. 2001.A study of the minimum inhibitory concentration and mode of action of oregano essential oil, thymol and carvacrol. JournalofAppliedMicrobiology.91:453-462.
León, R. 2002. Espectro de acción de mezclas ternarias de agentes antimicrobianos. Tesis de Maestría. Universidad de las Américas Puebla. México.
López-Malo, A. 2000.La preservación multiobjetivo de alimentos: Efectos de factores tradicionales y emergentes en la respuesta de Aspergillus flavus. Tesis de Doctorado. Universidad de Buenos Aires. Argentina.
López-Malo, A., Alzamora, S. M. y Guerrero, S. 2000. Natural antimicrobials from plants. En:S. M. Alzamora, M. S. Tapia, y A. López-Malo (Eds).Minimally Processed Fruits and Vegetables. Fundamental Aspects and Applications. Aspen Publishers, Inc. New York. pp 201-215.
Oosterhaven, K., Poolman, B. y Smid, E. J. 1995. Scarvone as a natural potato sprout inhibiting, fungistatic and bacteristatic compound.Industrial CropsandProducts. 4:23-31.
Santiesteban-López, A., Palou, E. y López-Malo A. 2007. Susceptibility of food-borne bacteria to binary combinations of antimicrobials at selected aw and pH. Journal of Applied Microbiology. 102(2):486-497.
Skandamis, P. N. y Nychas, G. J-E. 2001. Effect of oregano essential oil on microbiological and physico-chemical attributes of minced meat stored in air and modified atmospheres. Journal of AppliedMicrobiology.91:1011-1022.
Tassou, C. C. y Nychas, G. J. E. 1994. Inhibition of Staphylococcus aureus by olive phenolics in broth and in a model food system. Journal of Food Proection.59:412-415.
Ultee, A. y Smid, E.J. 2001.Influence of carvacrol on growth and toxin production by Bacillus cereus.International Journal of Food Microbiology.64:373-378.
Ultee, A., Bennink, M.H.J. y Moezelaar, R. 2002. The phenolic hydroxyl group of carvacrol is essential for action against the food-borne pathogen Bacillus cereus Applied and Environmental Microbiology. 68(4):1561-1568.
Ultee, A., Gorris, L. G. M. y Smid, E. J. 1998.Bactericidal activity of carvacrol towards the food-borne pathogen Bacillus cereusJournal of AppliedMicrobiology. 85(2):211-218.
Ultee, A., Kets, E.P.K., Alberda, M., Hoekstra F.A. y Smid, E.J. 2000.Adaptation of the food-borne pathogen Bacillus cereus to carvacrol.Archives of Microbiology.174:233.238.
Walsh, S. E., Maillard, J. Y., Russell, A. D., Catrenich, C. E., Charbonneaus, D. L. y Bartolo R. G. 2003. Activity and mechanisms of action of selected biocidal agents on Gram positive and negative bacteria. Journal of Applied Microbiology.94:240-247.

Temas Selectos de Ingeniería de Alimentos 2 – 2 (2008): 52 – 68
Temas Selectos de Ingeniería de Alimentos
Tecnología de obstáculos como método de inhibición del crecimiento de mohos en alimentos
A. I. Gómez – Sánchez
DepartamentodeIngenieríaQuímicayAlimentos,UniversidaddelasAméricas–Puebla.
SanAndrésCholula,Pue.,México.
Resumen
Esta revisión bibliográfica presenta algunos factores y las interacciones entre éstos que afectan el crecimiento de los mohos contaminantes de alimentos, con la finalidad de aplicarlos de forma óptima en la conservación de los mismos, mediante la tecnología de obstáculos o métodos combinados. Se reportan los principales mohos contaminantes en los alimentos frutas y verduras, cereales y productos de panadería, entre otros. Asimismo, se presentan los fundamentos y conceptos de la tecnología de obstáculos, comentando los diferentes mecanismos de estrés que afectan la supervivencia de los microorganismos, y se enfatiza el efecto conservador de los factores actividad de agua, pH y antimicrobianos, tanto sintéticos como naturales, sobre los principales mohos contaminantes de alimentos. Finalmente, se comentan algunas investigaciones en la aplicación de la tecnología de obstáculos a la inhibición del crecimiento de mohos en sistemas alimenticios.
Palabras clave: Moho, métodos combinados, tecnología de obstáculos, estrés, actividad de agua, pH, antimicrobianos.
Abstract
This review shows some factors and their interactions that affect the food spoilage mold growth, in order to apply them in a practical way for the food preservation, by means of hurdle or combined methods technology.The main spoilage molds in fruits and vegetables, cereals and bakery products, among others are shown as well as the fundamentals and concepts of hurdle technology, mentioning the different stress mechanisms that affect the survival of microorganisms. Also it is emphazised the preservative effect on the main spoilage food molds of the factors water activity, pH and synthetic or natural antimicrobials. Finally, some current scientific researchs on food systems are reported.
Keywords: Mold, combined methods, hurdle technology, stress, water activity, pH, antimicrobials.
Introducción
Los mohos y las levaduras son los principales organismos causantes de daño en
*Programa de Doctorado en Ciencia de Alimentos
Tel.: +52 222 229 2126, fax: +52 222 229 2727
Direccion electrónica: aida.gomez@udlap.mx
alimentos de baja actividad de agua y pH, debido a que son extremadamente tolerantes aestosdosfactores(Gould,2000a).
Para la prevención de este tipo de contaminación, es recomendable la aplicacióndelatecnologíadeobstáculosode
métodos combinados (Chirife y Faveto, 1992; Leistner, 1992a, 2000a). Dicha tecnología usa varios factores de preservación, los cuales en forma separada no proporcionan el mismo efecto quecuando se combinan, ya que pueden actuar en forma sinérgica para inhibir o retardar el crecimiento microbiano. Los factores de conservación más importantes son: temperatura (alta o baja), actividad de agua (aw), pH, potencial redox, antimicrobianos, composición gaseosa y flora competitiva (Leistner, 1992a). Entre las combinaciones más usadas seencuentran los tratamientos en los cuales en forma simultánea se aplica un antimicrobiano ácido y se disminuye el pH para incrementar su efectividad (Gould, 1996). Asimismo, el uso combinado de antimicrobianos naturales y sintéticos, reducción de pH y aw, ha sido estudiado sobre el crecimiento de mohos (López-Malo et al.,2000,2002,2005, 2007;Guynot et al., 2005a).
La tecnología de obstáculos ha sido aplicada ampliamente a nivel mundial en la conservación de alimentos de humedad intermedia (IMF) y de alta humedad (HMPF), con el consecuente desarrollo de productos mínimamente procesados a base de carne, pescado, frutas y vegetales, cereales, lácteos y productos de panadería (Leistner, 1985, 1987, 1992a, 1992b, 1994, 1995, 1999, 2000b). Asimismo, estudios acerca de la prevención del crecimiento de mohos en productos de panadería han destacado la interacción de factores tales como aw, temperatura, pH (Abellana et al., 1999, 2001) y la adición de conservadores (Guynot et al.,2002;Marín etal.,2002a,b).
Actualmente, se puede afirmar que esta tecnología responde a las demandas de los consumidores respecto a la existencia de alimentos procesados de calidad sanitaria, sensorialynutricional.
El objetivo de esta revisión es presentar algunos factores que afectan o favorecen la inhibición del crecimiento de los mohos en los alimentos, así como el efecto que tienen las interacciones de estos factores sobre su crecimiento, en referencia a la conservación de los alimentos mediante la tecnología de obstáculos o métodos combinados. Asimismo, a manera de ejemplos se presentan algunas de las investigaciones recientesrealizadasensistemasalimenticios.
Revisiónbibliográfica
Mohos de interés enalimentos
Los mohos son un grupo diverso de organismos ytienen un impacto significativo en la producción, contaminación y seguridad delosalimentos(Burnett,1976;Alexopoulos y Mims, 1985). Algunos mohos producen metabolitos secundarios, los cuales son diversos compuestos de bajo peso molecular, y muchos de ellos son secretados al medio ambiente. Cuando estos metabolitos son tóxicos a los humanos y animales domésticos,yestánasociadosalosalimentos omateriasprimasusadas parasuproducción, se les denomina micotoxinas (Chelkowski, 1991;SharmaySalunkhe,1991).
En cuanto a la contaminación de alimentos por mohos, Hocking y Christian (1995) señalan que la microflora dominante en los alimentos depende principalmente de su actividad de agua y del pH. Así, se tiene que los mohos y las levaduras se pueden encontrar en alimentos de alta actividad de agua (aw > 0.95) ypH ácido (frutas, jugos de frutas, yoghurt), alimentos con valores de aw menores a 0.90 (mermeladas, conservas de frutas, frutas deshidratadas, alimentos de humedad intermedia, entre otros), y alimentos de actividad de agua reducida
A. I. Gómez - Sánchez / Temas Selectos de Ingeniería de Alimentos 2 – 2 (2008): 52 – 68
Tabla I. Tipos de contaminación por mohos en frutas y hortalizasa
Grupo de alimentosTipo de dañoMoho responsableAlimento FrutasAlternaria
Podrido amargo
Podrido café
Alternaria sp. Frutas cítricas
Colletotrichum musae Plátanos
Monilinia fructicola Duraznos
Podrido de la coronilla Colletotrichum musae Plátanos
Fusarium roseum
Verticillium theobromae
Ceratocystis paradoxa
Podrido gris
Botrytis cinerea Uvas
Podrido negro de piña Ceratocystis paradoxa Piñas
Podrido agrio
Geotrichum candidum Frutas cítricas
Jitomates
Podrido Cryptosporiopsis malicorticus Manzanas,peras
Phylctaena vagabunda
Podrido verde Penicillium digitatum Frutas cítricas
Podrido azul
Penicillium sp. Naranjas
Podrido por Cladosporium Cladosporium herbarum Duraznos, cerezas
HortalizasPodrido negro
Enmohecimiento
Aspergillus sp. Cebollas
Alternaria sp. Zanahorias, coliflor
Bremia, Phytophthora spp. Lechuga, espinacas
Podrido por FusariumFusarium sp Espárragos
Podrido gris
Botrytis sp Calabaza
Podrido por RhizopusRhizopus sp Ejotes
Podrido negro
Aspergillus niger Cebollas, papas
Ceraocystis fimriata
Manchado Colletotrichum sp Cebollas
Podrido de tubérculos Fusarium sp Papas
Podrido suave acuoso Sclerotinia sp Apio
Marchitez Pythium sp Ejotes
Plaga
Podrido rosa
aAdaptado de Jay (1992)
Phomopsis sp Berenjena
Trichothecium sp Duraznos
(0.65-0.80) tales como cereales, nueces y especias, en los cuales los mohos son la principalfloracontaminante.
Snowdon (1990) señala que algunos mohos son capaces de invadir las frutas y hortalizas y causar grandes pérdidas, descartando la posibilidad de la contaminación por bacterias, dados los valores de pH ácido de estos alimentos, los cuales oscilan desde 2.0 para limones, hasta 4.5-5.0 para higos. La Tabla I presenta ejemplos de algunos tipos de contaminación
en frutas y hortalizas, y los mohos asociados (Moss,2000).
Lacontaminaciónpormohosenproductos de panificación es un problema de significancia económica. Doores (2005) señala que, a pesar de que las esporas de los mohos son destruídas en el horneado, ocurre la contaminación posterior al proceso por medio de la atmósfera circundante, las superficies de enfriamiento y los materiales de empaque. Así, Beuchat (1983) indica que los mohos asociados con esta contaminación
I. Gómez - Sánchez / Temas Selectos de Ingeniería de Alimentos 2 – 2 (2008): 52 – 68
incluyen a las especies de Aspergillus, Penicillium, Mucor y Rhizopus; yNortholt et al. (1995) afirman que los de mayor importancia son Penicillium commune, Penicillium crustosum, Penicillium brevicompactum, Penicillium crysogenum, Penicilliumroqueforti, Aspergillusversicolor y Aspergillus sydowii, y que en pasteles de baja actividad de agua, los mohos Eurotium sp., Aspergillus sp. y Wallemia sebi son los másencontrados.
En cuanto a productos lácteos, cabe mencionar que en quesos, los mohos P.roqueforti y P.commune sonlasprincipales especies responsables del daño (causado a través de los empaques), y en mantequillas de bajo contenido de sal, Penicillium y Cladosporium (Hocking, 1994). Por otra parte, las carnes curadas son dañadas por especiesdelosmohos Penicillium, Eurotium, Aspergillus y Cladosporium (Hadlok et al., 1976).
Respecto a alimentos elaborados con altas concentraciones de azúcar, tales como mermeladas, jaleas, concentrados de frutas, dulces y frutas deshidratadas, los mohos xerófilos encontrados son Xeromyces bisporus y especies de Chrysosporium y Eremascus (HockingyChristian,1995).
En relación a la toxicidad en alimentos,
existentres géneros demohosproductoresde micotoxinas especialmente importantes: Aspergillus, Penicillium y Fusarium. En la Tabla II se presentan las principales micotoxinas encontradas en alimentos, y los mohosquelasproducen.
En términos de toxicidad aguda, las micotoxinas encontradas comúnmente en los alimentos son cerca de un millón de veces menos tóxicas que las toxinas del botulismo, y son significativamente menos tóxicas que muchas toxinas producidas por algas. Sin embargo, en términos de toxicidad crónica a largo plazo, su control es de especial interés, ya que varios de estos metabolitos son carcinógenos, y afectan los sistemas inmunológicos de muchas especies animales, incluyendo al hombre (Moreau, 1979; Smith y Moss, 1985; Krogh, 1987; Betina, 1989; Chelkowski, 1991; Smith y Henderson, 1991;Moss,1996).
Principales factores que afectan el crecimientode mohos en alimentos
Actividad de agua. El requerimiento de la mayoría o la totalidad de los mohos para llevar a cabo la germinación de esporas, así como su crecimiento, es la humedad. El contenido de humedad de los sustratos se encuentra mejor expresado como actividad de agua (aw). En general, de los
Tabla II. Principales micotoxinas encontradas en alimentos y mohos que las producena
MicotoxinaPrincipales alimentosEspecies de mohos productoras
AflatoxinasMaíz,cacahuates, nueces, higos,
Aspergillus flavus, A.parasiticus cereales, especias, frutas deshidratadas
Ácido ciclopiazónicoQueso, maíz, cacahuates
CitrininaCereales (cebada, trigo, arroz, centeno, avena)
Deoxi-nivalenolCereales
FumonisinaMaíz
OcratoxinaMaíz, cereales, café en grano
Aspergillus flavus, Penicillium aurantiogriseum
P.viridicatum, P.citrinum, A.ochraceus
Fusarium graminearum, F.culmorum
Fusarium moniliforme
Penicillium verrucosum, Aspergillus ochraceus
PatulinaFrutas infestadas (manzanas, ciruelas), Penicillium expansum
jugo de manzana
EsterigmatocistinaCereales, café, frijoles, queso
ZearalenonaMaíz, cebada, trigo
aAdaptado de Sharma y Salunkhe (1991); Moss (2000)
Aspergillus versicolor
Fusarium graminearum
A. I. Gómez - Sánchez / Temas Selectos de Ingeniería de Alimentos 2 – 2 (2008): 52 – 68
microorganismos asociados con los alimentos,losmohossonlosmástolerantesa una actividad de agua reducida (Leistner y Rödel,1976).EnlaTablaIIIsepresentanlos valoresdeaw mínimosparaelcrecimientode algunosmohos.
Tabla III. Actividades de agua mínimas para el crecimiento de algunos mohosa
Especieaw mínima
Rhizopus nigricans 0.94
Fusarium graminearum 0.89
Fusarium poae 0.89
Fusarium sporotrichioides 0.88
Alternaria alternata 0.88
Fusarium moniliforme 0.87
Cladosporium herbarum 0.85
Penicillium expansum 0.83
Penicillium aurantiogriseum 0.82
Penicillium verrucosum 0.81
Aspergillus flavus 0.81
Aspergillus versicolor 0.78
Aspergillus ochraceus 0.76
Eurotium chevalieri 0.71
Wallemia sebi 0.69
Xeromyces (Monascus) bisporus 0.61 aAdaptado de Moss (2000)
Para la mayoría de los microorganismos, la reducción de aw del medio ambiente que los rodea causa la disminución de la velocidad de crecimiento, la velocidad de respiración, la actividad enzimática, la esporulación ylaproduccióndetoxinas.Esto también incrementa la permeabilidad de la membrana celular y afecta la composición intracelular(Christian,2000).
La habilidad de los mohos para tolerar niveles de aw reducidos varía grandemente, detalformaquelasespeciesde Aspergillus y Penicillium son capaces de crecer en medios con aw ligeramente inferior a 1.0, mientras que las especies xerofílicas Xeromyces bisporus y Eurotium echinolatum crecenpor debajodeaw de0.60(Beuchat,1983).
pH. El pH de los alimentos influye en su susceptibilidad al crecimiento microbiano, y la acidificación, ya sea por adición de ácidos o por fermentación, es usada en la preservación de muchos tipos de alimentos (LundyEcklund,2000).
Cuando el pH es adverso a los microorganismos, éste afecta a al menos dos aspectos de la célula microbiana: el funcionamiento de sus enzimas, y el transporte de nutrientes al interior de la célula(Jay et al.,2005).
La mayoría de los mohos pueden tolerar un amplio intervalo de valores de pH, como seobservaenlaTablaIV.
Antimicrobianos. Los antimicrobianos sintéticos más comúnmente usados para la inhibición del crecimiento de mohos son ácidos débiles tales como ácido propiónico, ácido benzoico yácido sórbico (Earle y Putt, 1984; Chirife y Favetto, 1992; Legan, 1993; Suhr y Nielsen, 2004; Guynot et al., 2005a). La Tabla V muestra algunos antimicrobianos GRASusadosenalimentosparalainhibición demohos.
El valor de pH ácido del alimento puede provocar la ionización del antimicrobiano y un cambio en su actividad. Por ejemplo, los ácidos orgánicos funcionan en bajas concentraciones únicamente en alimentos de alta acidez (generalmente con pH menor a 4.5 ó 4.6). Esto es debido a que la forma antimicrobiana más efectiva es la del compuesto no disociado, la cual se presenta en forma mayoritaria únicamente a un pH inferior al valor del pka del ácido. Todos los ácidos orgánicos regulados y aprobados usados como antimicrobianos tienen valores de pka menores que 5.0, lo cual significa que su máxima actividad se presentará en alimentos de alta acidez (Jay et al., 2005; DavidsonyBranen,2005).
Tabla IV. Rangos aproximados de pH para el crecimiento de mohos de importancia en alimentosa MohopH mínimopH óptimopH máximoReferencia
En general1.5 -3.54.5 - 6.88.0 - 11.0Banwart, 1989
Aspergillus flavus, A.parasiticus, 2.05.0 - 8.0> 11.0ICMSF, 1996; Pitt y Hocking, 1997; A.niger Wheeler et al. , 1991
Fusarium equiseti < 3.35.0 - 8.0> 10.4Pitt yHocking, 1997; Wheeler et al., 1991
Penicillium verrucosum < 2.16.0 - 7.0> 10.0Pitt yHocking, 1997; Wheeler et al., 1991 aAdaptado de Lunn yEklund (2000)
Los antimicrobianos naturales tales como hierbas, plantas y especias (o sus componentes) tienen propiedades fungicidas, además de actuar como ingredientes tradicionales y saborizantes en los alimentos (López-Malo et al., 2000, 2002, 2007; Gowda etal.,2004;Guynot et al.,2004).
Buchanan y Shepherd (1981) determinaron que 100 ppm de timol inhiben el crecimiento de Aspergillus parasiticus durante7díasa28°C.Asimismo,Mahmoud (1994) reportó que el aldehído cinámico en concentraciones menores a la concentración mínima inhibitoria (CMI) retarda el crecimiento de Aspergillus flavus durante 8 díasa28°C.
López-Malo et al. (1995)demostraronque la concentración de vainillina y el tipo de agar afectan significativamente el crecimientoradialdeespeciesde Aspergillus, y que además existen diferencias en las respuestas de acuerdo al tipo de moho. Similarmente, Paster et al. (1990) encontraron que los aceites esenciales de orégano y clavo tuvieron actividad fungicida en tres especies de Aspergillus, encontrando también diferencias de respuesta por el tipo demoho.
Actualmente, los consumidores demandan productos alimenticios más naturales y saludables, por lo que la investigación en estos compuestos cada vez cobra mayor importancia(Buchanan,1993;LópezMalo et
Tabla V. Algunos conservadores químicos GRAS para la inhibición de mohosa ConservadoresToleranciaAlimentos máxima
Ácido propiónico y propionatos0.32%Pan, pasteles, algunos quesos
Ácido sórbico y sorbatos0.2%Quesos duros, jarabes, aderezos de ensaladas, jaleas, pasteles
Ácido benzoico y benzoatos0.1%Margarina, pepinillos encurtidos, sidra, sodas, salsa catsup, aderezos de ensaladas
Parabenos0.1%Productos de panificación, sodas, pepinillos, aderezos de ensaladas
Etileno y óxidos de propileno700 ppmFumigante para especias y nueces
Diacetato de sodio0.32%Pan
aAdaptado de Jay et al. (2005)
A. I. Gómez - Sánchez / Temas Selectos de Ingeniería de Alimentos 2 – 2 (2008): 52 – 68
Tabla VI. Componentes con actividad antimicrobiana encontrados en plantas, hierbas yespeciasa
Planta, hierba o especiaPrincipal (es) componentes(s)Otro(s) componente(s)
Pimienta de Jamaica (Pimenta dioica ) eugenolmetil éter cineol
Albahaca (Ocimum basilicum ) d-linalool, metil chavicol,eugenol, cineol, geraniol
Pimienta negra (Pipper nigrum ) monoterpenos, sesquiterpenos, compuestos oxigenados
Laurel (Laurus nobilis ) cineoll-linalool, eugenol, geraniol
Semilla de alcaravea (Carum carvi ) carvonolimoneno
Semilla de apio (Apium graveolens ) d-limoneno
Canela (Cinnamomum zeylanicum ) aldehído cinámicol-linalool, p-cimeno,eugenol
Clavo (Syzygium aromaticum ) eugenolcariofileno
Cilantro (Coriandum sativum ) d-linalol d-α−pineno, β−pineno
Comino (Cuminum cyminum ) cuminaldehídop-cimeno
Hinojo (Foeniculum vulgare ) anetol
Ajo (Allium sativum ) dialil-disulfuro,dialil-trisulfurodietil sulfuro,alicina
Té limón (Cymbopogon citratus ) citralgeraniol
Mejorana (Origanum majorana ) linalool, cineol, eugenol, terpinineolmetil chavicol
Mostaza (Brassica hirta,B.juncea, B.nigra) alil-isotiocianato
Cebolla (Allium cepa ) d-n-propil disulfuro, metil-n-propil disulfuro
Orégano (Origanum vulgare ) timol, carvacrol α−pineno, p-cimeno
Perejil (Petroselinum crispum ) α−pineno, fenol-éter-apiol
Romero (Rosmarinus officinalis ) borneol, cineol canfor, α−pineno, bornil acetato,, terpinol
Salvia (Salvia officinalis ) tujon,cineol,borneoltimol, eugenol
Estragón (Artemisia dracunculus ) metil chavicolanetol
Tomillo (Thymus vulgaris ) timolcarvacrol, l-linalool geraniol, p-cimeno
Vainilla (Vanilla planifolio, V.pompona, vainillinavainillica, ácidos p-hidroxibenzoico y V.tahilensis ) p-cumárico aLópez-Malo et al . (2000)
al., 2005). La Tabla VI presenta una recopilación de los principales antimicrobianosnaturalesestudiados.
Se ha demostrado que las concentraciones de aceites esenciales o extractos de plantas requeridas para causar efectos antimicrobianos son considerablemente mayores cuando se aplican a alimentos que a sistemas modelo (Shelef et al., 1984; Kabara y Eklund, 1991; Juven et al., 1994). Así, cuando los antimicrobianos se aplican en estas concentraciones a los productos alimenticios, se pueden modificar las características sensoriales de los mismos, ocasionando que no sean aceptables para su consumo. Por lo tanto, se sugiere el uso de
antimicrobianos naturales en combinación con otros factores ambientales, de modo que no únicamente se potencien sus propiedades antimicrobianas, sino también se desarrollen productos deconsumo con bajo contenido de antimicrobianos naturales y sintéticos (López-Malo etal., 2005).
Tecnologíadeobstáculos
Los factores usados en la conservación de alimentos se denominan “obstáculos” (Leistner y Gorris, 1995). Los más importantes y más usados son: temperatura (alta o baja), actividad de agua (aw), pH, potencial redox (Eh), antimicrobianos, composición gaseosa y flora competitiva, de
los cuales se ha demostrado que sus interacciones son significativas en la estabilidad microbiana y la seguridad de los alimentos (Leistner, 1992a, 1995, 2000a). Aparte de los obstáculos ya indicados, o tradicionales,cabemencionaralgunos,como: empacado en atmósferas modificadas, cubiertas comestibles, entre otros (Leistner, 1994; Leistner y Gorris, 1994; BoghSorensen, 1994; Leistner, 1999, 2000a; OhlssonyBengtsson,2002).
Por otra parte, ciertos obstáculos de tipo físico y no térmicos están siendo estudiados debido a su potencial en la estabilización microbiológica de productos frescos y su leve efecto en la degradación de las propiedades nutricionales y sensoriales; algunos de ellos son: alta presión, campos magnéticos oscilantes, pulsaciones en campos eléctricos, ypulsos ligeros (BarbosaCánovas et al., 1998). Otro obstáculo de interés son los “conservadores naturales”, talescomohierbasyespeciasysusextractos.
Generalidades. La “tecnología de obstáculos”, también denominada de “métodos combinados”, consiste en combinar de forma inteligente los obstáculos o factores que aseguran la estabilidad y seguridad microbiológica de los alimentos, conservando asimismo sus propiedades sensoriales y nutritivas, y proporcionando beneficios económicos (Leistner, 1995a,b, 2000a).
El “efecto obstáculo”, del cual se desarrolla el concepto de “tecnología de obstáculos”, señala que los microorganismos presentes inicialmente en un alimento no deben de sobrepasar los obstáculos establecidos, de otra forma el alimento se dañará o causará alguna enfermedad. La Fig.1 muestra algunos ejemplos de este efecto (Leistner, 1992,1995).
El ejemplo No.1 muestra el caso ideal, en el cual se aplican a un alimento seis obstáculos con la misma altura, o intensidad: alta temperatura en su procesamiento (valor F), baja temperatura para su almacenamiento (valort),actividad de agua(aw), acidez(pH), potencial redox (Eh) del producto y conservadores (pres.). En este caso, los microorganismos no pueden superar todos los obstáculos y se obtiene un alimento estable y seguro, pero esta situación rara vez ocurre.


Fig.1 Ejemplosdelefectoobstáculo. Significadodelossímbolos:F, calentamiento;t,enfriamiento;aw, actividaddeagua;pH,acidificación; Eh,potencialredox;pres., conservadores;K-F,floracompetitiva;
En productos fermentados, tales como embutidos, jamones y quesos madurados, se requiere de una secuencia de obstáculos para obtener productos estables y seguros. Ello es
A. I. Gómez - Sánchez / Temas Selectos de Ingeniería de Alimentos 2 – 2 (2008): 52 – 68
Tabla VII. Algunos factores de estrés y sus respuestas homeostáticas en alimentos conservados por tecnología de obstáculosa
Factor de estrésRespuesta homeostática
Reducción de pHExpulsión del ion hidrógeno a través de la membrana celular; mantenimiento del pH citoplasmático.
Presencia de ácidos orgánicos débilesExpulsión del ion hidrógeno adicional. (sórbico, benzoico, etc.)
Actividad de agua reducidaOsmorregulación; acumulación de solutos compatibles; evasión de pérdida de agua; mantenimiento de la turgencia en membranas.
aAdaptado de Gould (2000)
mostrado en el ejemplo No.7, donde los microorganismos patógenos y deteriorativos son inhibidos, y las bacterias ácido-lácticas sonseleccionadas(Leistner,1987,1992b).
En alimentos en los cuales la carga microbiana inicial es baja, tales como aquéllos procesados en forma aséptica, o el caso de escaldado de frutas, en donde la carga microbiana inicial es reducida mediante el pre-tratamiento de escaldado con vapor, se requiere de pocos obstáculos para lograr la estabilidad del producto, como se muestra en el ejemplo No. 3. Contrario a esto, en el caso de alimentos manejados en malas condiciones higiénicas que presentan elevada carga microbiana inicial, los obstáculos usuales no pueden preservar al alimento,(ejemploNo.4).
A través de los años, el entendimiento del “efecto obstáculo” y las aplicaciones de la tecnología de obstáculos han sido ampliados. En países industrializados, el enfoque de la tecnología de obstáculos es hacia los alimentos mínimamente procesados, en los cualeselcalentamientoolafermentaciónson leves, entre otras características (Shewfelt, 1987); asimismo, se busca desarrollar productos más saludables con bajo contenido de grasa o sal (Leistner, 1997), o alimentos que requieran menos empaques. Por otra parte, en Latinoamérica se trabaja
especialmente en productos de frutas de alta humedad, aunque también en carnes y pescados; en China y Taiwan se tiene especial interés en productos a base de carne y en la adaptación de alimentos fusión; y en laIndiaenproductoslácteos,cereales,frutas, aves y pescados (Leistner y Gould, 2005). Adicionalmente, existe una tendencia generalizada a desarrollar productos diferentes a los de humedad intermedia, debido a que ellos son demasiado salados o dulces, y su textura y apariencia son menos atractivas que las de los alimentos de alta humedad(Leistner,2000b).
Principales mecanismos de respuesta de los microorganismos a la tecnología de obstáculos. Las respuestas de los microorganismos a los ambientes hostiles o de estrés determinan si ellos sobreviven o mueren. De acuerdo a ello, a continuación se comentan algunos tipos de respuestas, o mecanismos sugeridos: homeostasis, agotamiento metabólico y protección medianteproteínas(Leistner,1995,2000a).
La homeostasis, entendida como la tendencia de un organismo a uniformar y estabilizarsuestadointerno,esunarespuesta determinante en lapreservación de alimentos por obstáculos. Al ser ésta trastornada, los microorganismos no se multiplican, sino que quedanenlafaselagomueren(Gould,1988,
1995, 2000b). En la Tabla VII se presentan las reacciones homeostáticas a algunos factoresdeestrésaplicadosenalimentos.
El agotamiento metabólico de los microorganismossefavoreceporlosfactores temperatura de almacenamiento elevada, presencia de antimicrobianos y daño subletal, ya que los microorganismos al hacer uso de toda su energía para restablecer su homeostasis consecuentemente mueren. Esto asimismo puede provocar una “autoesterilización”, debido a que aquéllos organismos que no pueden crecer, morirán. (Leistner,1995,2000a,b).
Algunas bacterias producen proteínas protectoras bajocondicionesdeestrés,loque ocasiona que éstas adquieran mayor resistencia, o incluso se tornen más tóxicas. La síntesis de estas proteínas es inducida por inanición, así como por los factores calor, pH,aw,etanolycompuestosoxidativos,entre otros,yafectaporlotantolaconservaciónde alimentosporobstáculos(Leistner,2000a).
Algunas aplicaciones asistemasalimenticios
La tecnología de preservación de alimentos por medio de obstáculos, o de factores combinados, ha sido extensivamente estudiada y aplicada a mohos. A continuación se mencionan, a manera de ejemplos, algunos estudios sobre el uso de la tecnología de los obstáculos mostrando el efecto de las interacciones de los factores aw, pH y antimicrobianos sintéticos y naturales, sobre la inhibición del crecimiento de mohos en sistemas modelo y alimenticios. Se comentan algunas investigaciones recientes en el uso de antimicrobianos naturales como una alternativa a los antimicrobianos sintéticos, en frutas mínimamente procesadas, productos de panificación y cereales,particularmentemaíz.
Uso de antimicrobianos naturales y sintéticos en sistemas modelo. El uso de agentes antimicrobianos enalimentos hasido discutidodesdehacevariasdécadas(Parish y Carroll, 1988). La demanda incrementada en la reducción de aditivos en alimentos (incluyendo compuestos antimicrobianos), así como de alimentos más “naturales”, ha provocado la investigación en compuestos antimicrobianos alternativos o sus combinaciones(López-Malo et al.,2000).
Guynot et al. (2005b) al investigar en sistemas modelo la actividad fungicida de 20 aceites esenciales en mohos contaminantes de productos de panadería tales como Eurotium spp., Aspergillus spp.y Penicillium spp., a diferentes condiciones de aw (0.800.90) y pH (5.0-7.5), concluyeron que la actividadfungicidadependedelosnivelesde aw ypH,presentándoseunamayorinhibición amayoraw,demodo contrarioaloesperado. Asimismo,indicanquelainteracciónentrela concentración del aceite esencial y el pH depende principalmente de cada aceite esencial, siendo los aceites esenciales con mayor efectividad fungicida: canela, clavo, tomillo,romeroylaurel,mostrandoestostres últimos mayor efectividad a pH de 5.0, mientras que únicamente el aceite de canela es efectivo a pH neutro. Lo anterior sugiere laposibilidaddelusodeaceitesesencialesde plantas como una alternativa a los compuestos químicos para preservar productosdepanadería.
Asimismo, López-Malo y Argaiz (1999) evaluaron el efecto de citral (0, 500, 1500 y 2000 ppm) y el pH (3.5, 4.5, 5.5, 6.5) sobre el crecimiento de A.flavus, A.parasiticus, P.digitatum y P.italicum en agar PDA ajustado a aw de 0.97, y hallaron que la velocidaddecrecimiento radialdelos mohos aumentó al disminuir la concentración de citral y aumentar el pH; en cambio, al disminuir el pH y aumentar la concentración decitral,eltiempoparalagerminacióndelos
A. I. Gómez - Sánchez / Temas Selectos de Ingeniería de Alimentos 2 – 2 (2008): 52 – 68
mohos se incrementó. Adicionalmente, indican que la concentración inhibitoria del citral depende del pH y es diferente entre mohos.
Aunque la actividad fungicida de la mayoría de los aceites esenciales muestra dependencia con el pH, no se puede establecer una relación entre la actividad antimicrobiana y la acidez del medio. Se requiere mayor conocimiento acerca del mecanismo inhibitorio de los aceites esenciales en relación tanto a la aw como al pH(López-Malo et al., 2000).
Por otra parte, López-Malo et al. (2005), al estudiar los efectos combinados entre actividad de agua, (0.99 ó 0.95), pH (3.5 ó 4.5), agente antimicrobiano (sorbato de potasio, benzoato de sodio, bisulfito de sodio, carvacrol, citral, eugenol, timol y vainillina) a concentraciones de 0, 100, 200 hasta 1800 ppm sobre el crecimiento de A.flavus en un sistema modelo, indican que los antimicrobianos naturales son menos dependientes del pH que los conservadores químicos.Asimismo, Aflavus muestramayor sensibilidad al timol, eugenol, carvacrol, sorbato de potasio, bisulfito de sodio y benzoato de sodio a pH de 3.5, que a la vainillinaoalcitral.
Adicionalmente, López-Malo et al.(2007) señalan que mezclas binarias de extracto de canela y benzoato de sodio presentan sinergismo a pH de 4.5 sobre el crecimiento de A. flavus en un sistema modelo a base de agar papa-dextrosa ajustado a aw de 0.98, y proponen su uso como agentes fungicidas alternativosalosconvencionalesysintéticos. Se sugiere que el aceite de canela sea añadido como antimicrobiano a productos de panadería, ya que la canela es un ingrediente usual,yescompatibleconsusabor.
Igualmente, Azzouz y Bullerman (1982) reportaron efectos aditivos y sinérgicos en
mezclas de0.1% de clavo con 0.1%-0.3% de sorbato de potasio sobre el tiempo de germinación de mohos. Por otro lado, Matamoros-León et al. (1999) al evaluar los efectos individuales y combinados de concentraciones de vainillina y sorbato de potasio en el crecimiento de P.digitatum, P.glabrum y P.italicum en agar PDA ajustado a aw de 0.98 y pH de 3.5, reportan que las concentraciones requeridas para la inhibición del crecimiento son mayores para vainillinaqueparasorbato depotasio, siendo además diferentes de acuerdo al tipo de moho. Adicionalmente, señalan que mezclas de vainillina y sorbato de potasio muestran efectosinérgico.
Frutas mínimamente procesadas. El desarrollo de productos a base de frutas usando la tecnología de obstáculos ha conducido a la creación de alimentos denominados “frutas mínimamente procesadas”, cuyas características principales sonlaestabilidadatemperaturaambiente,ya valoresdeaw mayoresa0.93(Leistner,1999, 2000b; Leistner y Gould, 2002 Leistner y Gould,2005).
Se han desarrollado productos a base de rebanadasdedurazno,piña,mango,papayay chicozapote, así como purés de mango, plátano, ciruela, maracuyá, y también higos enteros, fresas y pomarrosa (Alzamora et al., 1993,1995).Suelaboraciónestábasadaenla combinación de un tratamiento térmico leve deescaldado,ligerareduccióndelaaw (0.980.93 por adición de glucosa o sacarosa), disminución del pH (4.1-3.0 mediante la adición de ácido cítrico o fosfórico), y la adición de antimicrobianos (1000 ppm de sorbato de potasio o benzoato de sodio, más 150 ppm de sulfito de sodio o bisulfito de sodio)aljarabedelosproductos.
Alzamora et al. (1989) reportan que al analizar productos de rebanadas de piña elaborados por métodos combinados (aw de
A. I. Gómez - Sánchez / Temas Selectos de Ingeniería de Alimentos 2 – 2 (2008): 52 – 68
0.97 ajustada con glucosa, 1000 ppm de sorbato de potasio, 150 ppm de bisulfito de sodio y pH de 3.1) y almacenados a 27°C durante 4 meses, no hubo crecimiento de mohos, levaduras, bacterías mesofílicas y bacterias anaerobias. Asimismo, López-Malo et al. (1994) indican que en papaya conservada (aw de 0.98 ajustada con sacarosa, 1000 ppm de sorbato de potasio, 150 ppmde bisulfito desodio ypHde3.5) y almacenada a 25°C durante 5 meses , los niveles de mohos, levaduras y bacterias mesofílicas aerobias fueron menores a 10 UFC/g.
En otros estudios, Cerruti y Alzamora (1996),Cerruti et al. (1997)yCastañón et al (1999) indican que en purés de fresa y plátano elaborados por métodos combinados (aw de 0.97y pH de 3.4) y almacenados a 15°C, 25°C ó 35°C durante 60 días, la adición de 3000 ppm de vainillina o de 1000 ppm de sorbato de potasio inhibe por completoel crecimientodemohos, levaduras ybacteriasmesofílicas.
Productos de panificación. Hoy en día, los consumidores no están a favor del uso de aditivos o conservadores, y es necesaria la reducción de las cantidades usadas tradicionalmente en la industria de la panificación(Membre et al.,2001).
Suhr y Nielsen (2004) al estudiar la inhibición de los mohos P.roqueforti, P.brevicompactum, P.corylophilum, P.commune, Eurotium repens, Eurotium rubrum, y Eurotium fibuliger por ácidos débiles en pan de centeno, a valores de aw entre 0.94 y 0.97 y pH de 4.4 a 4.8, reportan que el propionato es menos efectivo que el sorbato y el benzoato, y señalan que los niveles de actividad de agua y pH son de vitalimportanciaparacontrolarlaeficaciade los conservadores en productos depanadería. Guynot et al. (2005a,b), al trabajar con mohos Eurotium spp., Aspergillus spp. y
Penicillium corylophilum, reportan que a pH de4.5,laconcentracióndesorbatodepotasio puede ser de bajos niveles (entre 0 y 0.3%) únicamente a bajos valores de aw, mientras que a pH de 5.5, se observa crecimiento fúngico aún con sorbato de potasio al 0.3%. Aún así, es recomendable el uso de este conservadorenproductosdepanaderíadepH ácido y con vida de anaquel corta (aproximadamente una semana). Asimismo, recomiendan que en productos de pH 5.5 o mayor, se combine la adición de sorbato de potasio con niveles bajos de actividad de agua,como0.80.
Maíz. En el maíz, los géneros de mohos contaminantes más importantes son Fusaria y Aspergilli, el primero durante la precosecha, y el segundo en el almacenamiento (Martínez y Resnik, 1995). En países desarrollados, la temperatura y la actividad de agua son los principales factores usados para prevenir la contaminación, pero los sistemas de almacenamiento con temperatura controlada no son económicamente factibles en países en desarrollo (Resnik, 1993). Una alternativapara la preservación delos granos durante su almacenamiento es la aplicación de los conceptos de la tecnología de obstáculos.
Samapundo et al. (2007), al estudiar los efectos combinados de aw (0.92 -0.97) y concentraciones de bicarbonato de sodio (1 a 4%)ybicarbonatodeamonio(0.2a1.0%)en el crecimiento y producción de micotoxinas en maíz por especies de Fusarium y Aspergillus, concluyen y sugieren que el uso de bicarbonato de amonio puede ser una solución fácil de aplicar, de bajo costo, segura y altamente efectiva para el tratamiento y protección del maíz durante el almacenamiento a gran escala para países en vías de desarrollo; asimismo, sugieren que una concentración máxima de 1% de bicarbonato de amonio es aceptable para el consumohumano.
I. Gómez - Sánchez / Temas Selectos de Ingeniería de Alimentos 2 – 2 (2008): 52 – 68
Conclusiones
Las investigaciones científicas realizadas hasta ahora han demostrado que el daño de alimentos por contaminación con mohos se puede prevenir y controlar mediante la aplicación de la tecnología de métodos combinados, utilizando para ello los factores actividad de agua, pH, antimicrobianos naturalesysintéticos,entreotros.
Asimismo, la investigación en el uso de antimicrobianos naturales ya sea como sustitutos de los sintéticos o actuando en mezclas combinadas contra los mohos, es una importante alternativa en beneficio de la calidaddelproductoydelconsumidor.
Por lo anterior, los alimentos desarrollados, elaborados y preservados por métodos combinados cumplen con las demandas y expectativas actuales de los consumidores, respecto a la existencia de alimentos con características naturales, saludablesylibresdeaditivos.
Referencias
Abellana, M., Magrí, X., Sanchis, V. y Ramos, A. J. 1999. Water activity and temperature effects on growth of Eurotium amstelodami, E.chevalieri and E.herbariorum on a sponge cake analogue. International Journal of Food Microbiology 52:97-103.
Abellana, M., Sanchis, V. y Ramos, A. J. 2001. Effect of water activity and temperature on growth of three Penicillium species and Aspergillusflavus on a sponge cake analogue. International Journal of FoodMicrobiology. 71:151-157.
Alexopoulos, C. J. y Mims, C. W. 1985. Introducción alaMicología. Omega. Barcelona. 638p.
Alzamora, S. M., Gerschenson, L. N., Cerruti, P. y Rojas, A. M. 1989. Shelf-stable pineapples for long-term non refrigerated storage. LebensmittelWissenschaftund-Technologie. 22:233-236.
Alzamora, S. M., Tapia, M. S., Argaiz, A. y Welti, J. 1993. Application of combined methods technology in minimally processed fruits. Food ResearchInternational. 26: 125-130.
Alzamora, S. M., Cerruti, P., Guerrero, S. y LópezMalo, A. 1995. Minimally processed fruits by combined methods. En: G. V. Barbosa-Cánovas y J. Welti-Chanes (Eds). Food Preservation by Moisture Control: Fundamentals and Applications. Technomic Publishing Co. Lancaster. pp. 463-492.
Azzouz, M. A. y Bullerman, L. B. 1982. Comparative antimycotic effects of selected herbs, spices, plant components and commercial antifungal agents. JournalofFoodProtection. 45:1298-1301.
Banwart, G. J. 1989. Basic Food Microbiology. 2a. edición. Van Nostrand Reinhold, Nueva York. 773p.
Barbosa-Cánovas, G. V., Pothakamury, U. R., Palou, E. y Swanson, B. G. 1998. Nonthermal Preservation of Foods. Marcel Dekker. Nueva York. 276p.
Beuchat, L. R. 1983. Influence of water activity on growth metabolic activities and survival of yeasts and molds. Journal of Food Protection. 46:135141.
Betina, V. 1989. Mycotoxins, Chemical, Biological and Environmental Aspects. Elsevier. Amsterdan. 493p.
Bogh-Sorensen, L. 1994. Description of hurdles. En: L. Leistner y L. G. M. Gorris (Eds). Food Preservation by Combined Processes. European Comission. DG XII, EUR 15776 EN, ISBN 90900-7303-5. pp. 7-24.
Buchanan, R. L. y Shepherd, A. J. 1981. Inhibition of Aspergillus parasiticus by thymol. Journal of FoodScience. 46:976-977.
Buchanan, L. 1993. Predictive food microbiology. TrendsinFoodScienceandTechnology. 4:6-11.
Burnett, J.H. 1976. Fundamentals of Mycology. Crane Russak and Co., Inc. EE.UU. 673p.
Castañón, X., Argaiz, A. y López-Malo, A. 1999. Effect of storage temperature on the microbial and color stability of banana purées prepared with the addition of vanillin or potassium sorbate. Food ScienceTechnologyInternational. 5:53-60.
Cerruti, P. y Alzamora, S. M. 1996. Inhibitory effects of vanillin on some food spoilage yeasts in
A. I. Gómez - Sánchez / Temas Selectos de Ingeniería de Alimentos 2 – 2 (2008): 52 – 68
laboratory media and fruit purées. International JournalofFoodMicrobiology. 29:379-386.
Cerruti, P., Alzamora, S. M. y Vidales, S. M. 1997. Vanillin as an antimicrobial for producing shelfstable strawberry purée. Journal of Food Science 62:608-610.
Corlett, D. A. y Brown, M. H. 1980. pH y acidez. En: J. H. Silliker, R. P. Elliot, A. C. Baird-Parker, F. L. Bryan, J. H. B. Christian, D. S. Clark, J. C. Olson, y T. A. Roberts. Ecología Microbiana de los Alimentos. Acribia. España. pp. 97-114.
Chelkowski, J. 1991. Cereal Grain, Mycotoxins, Fungy and Quality in Drying and Storage. Elsevier. Amsterdan. 632p.
Chirife, J. y Favetto, J. 1992. Some physico-chemical basis of food preservation by combined methods. AppliedTechnology. 25:389-396.
Christian, J. H. B. 2000. Drying and reduction of water activity. En: B. M. Lund, T. C. Baird-Parker y G. W. Gould (Eds). The Microbiological Safety andQuality ofFood. Vol.1. Aspen Publishers, Inc. EE.UU. pp. 146-174.
Davidson, P. M. y Branen, A. L. 2005. Food antimicrobials-An introduction. En: P. M. Davidson, J. N. Sofos y A. L. Branen (Eds). Antimicrobials in food. Tercera edición. CRC Press Taylor & Francis Group. Nueva York. pp. 110.
Doores, S. 2005. Organic acids. En: P. M. Davidson, J. N. Sofos yA. L. Branen (Eds). Antimicrobialsin Food. Tercera edición. CRC Press Taylor & Francis Group. EE.UU. pp. 91-142.
Earle, M. D. y Putt, G. J. 1984. Microbial spoilage and use of sorbate in bakery products. Food Technology. 19:25-36.
Gould, G. W. 1988. Interference with homeostasisfood. En: R. Whittenbury, G. W. Gould, J. G. Banks y R. G. Board (Eds). Homeostatic Mechanisms in Micro-organisms. Bath University Press. Bath. pp. 220-228.
Gould, G. W. 1995. Homeostatic mechanisms during food preservation by combined methods. En: G.V. Barbosa-Cánovas y J. Welti-Chanes (Eds.). Food Preservation by Moisture Control:Fundamentals and Applications. Technomic Publishing Co. Lancaster. pp. 397-410.
Gould, G. W. 1996. Methods for preservation and extension of shelf life. International Journal of FoodMicrobiology. 33:51-64.
Gould, G. W. 2000a. Strategies for food preservation. En: B. T. Lund, C. Baird –Parker y G. H. Gould (Eds). The Microbiological Safety and Quality of Food. Vol.1 .Aspen Publishers, Inc. EE.UU. pp. 19-35.
Gould, G. W. 2000b. Induced tolerance of microorganisms to stress factors. En: S. M. Alzamora, M. S. Tapia y A. López-Malo (Eds). Minimally Processed Fruits and Vegetables. Fundamental Aspects and Applications. Springer. India. pp. 29-42.
Gowda, N. K. S., Malathi, V. y Suganthi, R. U. 2004 Effect of some chemical and herbal compounds on growth of Aspergillus parasiticus and aflatoxin production. Animal Feed Science & Technology 116 (3/4):281-291.
Guynot, M. E., Ramos, A. J., Sala, D., Sanchis, V. y Marín, S. 2002. Combined effects of weak acid preservatives, pH and water activity on growth of Eurotium species on a sponge cake. International JournalofFoodMicrobiology. 76:39-46.
Guynot, M. E., Ramos, A. J., Sanchis, V. y Marín, S. 2005a. Study of benzoate, propionate, and sorbate salts as mould spoilage inhibitors on intermediate moisture bakery products of low pH (4.5–5.5). International Journal of Food Microbiology 101(2):161-168.
Guynot, M. E., Marín, S., Setó, L., Sanchis, V. y Ramos, A. J. 2005b. Screening for antifungal activity of some essential oils against common spoilage fungi of bakery products. FoodScience & TechnologyInternational. 11(1):25-32.
Hadlok , R., Samson, R. A., Stolk, A. C. y Schipper, M. A. A. 1976. Mold contamination in meat products. Fleischwirtschaft. 56:374-376.
Hocking, A. D. 1994. Fungal spoilage of high fat foods. FoodAustralia. 46:30-33.
Hocking, A. D. y Christian, H. B. 1995. Microbial ecology interactions in the processing of foods. En: G.V. Barbosa-Cánovas y J. Welti-Chanes (Eds). Food Preservation by Moisture Control.Fundamentals and Applications-ISOPOW Practicum II. Technomic Publishing Company, Inc. EE.UU. pp. 553-574.
International Commission on Microbiological specifications for Foods (ICMSF).1996.
Microorganisms in Foods 5. Microbiological Specifications of Food Pathogens. Blackie Academic and Professional, Londres. 513p.
Jay, J. M. 1992. Spoilage of fruits and vegetables. En: J. M. Jay(Ed). ModernFoodMicrobiology. Cuarta edición. Van Nostrand Reinhold. Nueva York. pp. 187-198.
Jay, J. M., Loessner, M.J . y Golden, D.A. 2005. Modern Food Microbiology. Décimo séptima edición. Springer. India. 790p.
Juven, B. J., Kanner, J., Schved, F., y Weisslowicz, H. 1994. Factors that interact with the antibacterial action of thyme essential oil and its active constituents. Journal of Applied Bacteriology. 76:626-631.
Kabara, J. J. y Eklund, T. 1991. Organic acids and esters. En: N. J. Russel y G. W. Would (Eds). Food Preservatives. Blackie & Son Ltd. Glasgow. pp. 44-71.
Krogh, P. 1987. Mycotoxinsin Food. Academic Press. Londres. 246p.
Legan, J. D. 1993. Mold spoilage of bread: the problem and some solutions. International BiodeteriorationandBiodegradation. 32:33-53.
Leistner, L. 1985. Hurdle technology applied to meat products of the shelf stable product and intermediate moisture food types. En: D. Simatus y J. L. Multon (Eds). Properties of Water in Foods in Relation to Quality and Stability. Martinus Nijhoff Publishers. Dordrecht. pp. 309-329.
Leistner, L. 1987. Shelf-stable products and intermediate moisture foods based on meat. En: L. B. Rockland y L. R. Beuchat (Eds). Wateractivity: Theory and Applications to Food. Marcel Dekker. Nueva York. pp. 295-327.
Leistner, L. 1992a. Food preservation by combined methods. Food Research International. 25:151158.
Leistner, L. 1992b. The essentials of producing stable and safe raw fermented sausages. En: F. J. Smulders, M. F. Toldrá, J. Flores y M. Prieto (Eds). New Technologies for Meat and Meat Products. Audet Tijdschriften. Nijmegen. pp. 1-19.
Leistner, L. 1994. Further developments in the utilization of hurdle technology for food preservation. Journal of Food Engineering 22:421-432.
Leistner, L. 1995. Use of hurdle technology in food processing: recent advances. En: G. V. BarbosaCánovas y J. Welti-Chanes (Eds). Food Preservation by Moisture Control Fundamentals and Applications. Technomic Publishing Company, Inc. EE.UU. pp. 377-396.
Leistner, L. 1997. Microbial stability and safety of healthy meat, poultry and fish products. En: A. M. Pearson y T. R. Dutson (Eds). Production and Processing of Healthy Meat, Poultry and Fish Products. Blackie Academic and Professional. Londres. pp. 347-360.
Leistner, L. 1999. Combined methods for food preservation. En: M. Shafiur Rahman (Ed). Food Preservation Handbook. Marcel Dekker. Nueva York. pp. 457-485.
Leistner, L. 2000a. Hurdle technology in the design of minimally processed foods. En: S. M. Alzamora, M. S. Tapia y A. López-Malo (Eds). Minimally Processed Fruits and Vegetables. Fundamentals Aspects and Applications. Springer. India. pp. 1327.
Leistner, L. 2000b. Used of combined preservative factors in foods of developing countries. En: B. M. Lund, A. C. Baird-Parker y G. W. Gould (Eds). The Microbiological Safety and Quality of Food. Aspen Publishers. Gaithersburg. pp. 294-314.
Leistner, L. y Gorris, L. G. M. 1994. Food Preservation by Combined Processes. European Comission. DG XII, EUR 15776 EN, ISBN 90900-7303-5. 100p.
Leistner, L. y Gorris, L. G. M. 1995. Food preservation by hurdle technology. Trends in Food ScienceTechnology. 6:41-46.
Leistner, L. y Gould, G. W. 2002. Hurdle Technologies: Combination Treatments for Food Stability, Safety and Quality. Kluwer Academic/Plenum Publishers, Nueva York. 208p.
Leistner, L. y Gould, G. W. 2005. Update on hurdle technology approaches to food preservation. En: P. M. Davidson, J. N. Sofos y A. L. Branen (Eds). Antimicrobials in Food. Tercera edición. Taylor & Francis. EE.UU. pp. 621-630.
Leistner, L.y Rödel, W. 1976. The stability of intermediate moisture foods with respect to microorganisms. En: R. Davies, G. G. Birch y K. J. Parker (Eds). Intermediate Moisture Foods Applied Science Publishers. Londres. pp. 120-137.
Leyer , G. J. y Johnson, E. A. 1992. Acid adaptation promotes survival of Salmonella spp. in cheese. Applied Environmental Microbiology. 58:20752080.
López-Malo, A., Palou, E., Welti, J., Corte, P. y Argaiz, A. 1994. Shelf-stable high moisture papaya minimally processed by combined methods. Food Research International. 27(6):545553.
López-Malo, A., Alzamora, S. M. y Argaiz, A. 1995. Effect of natural vanillin on germination time and radial growth of moulds in fruit-based agar systems. FoodMicrobiology. 12:213-219.
López-Malo, A. y Argaiz, A. 1999. Citral and pH synergistic effects on mold growth. Documento No.37D-15, presentado en Congreso Anual IFT. Chicago, Julio 24-28.
López-Malo, A., Alzamora, S. M. y Guerrero, S. 2000. Natural antimicrobials from plants. En: S. M. Alzamora, M. S. Tapia y A. López-Malo (Eds). Minimally Processed Fruits and Vegetables. Aspen Publishers. EE.UU. pp. 237-263.
López-Malo, A., Alzamora, S. y Palou, E. 2002. Aspergillus flavus dose–response curves to selected natural and synthetic antimicrobials. International Journal of Food Microbiology 73(2/3):213-218.
López-Malo, A., Alzamora, S.M. y Palou, E. 2005. Aspergillus flavus growth in the presence of chemical preservatives and naturally occurring antimicrobial compounds. International Journal ofFoodMicrobiology. 99(2):119-128.
López-Malo, A., Barreto-Valdivieso, J., Palou, E. y San Martín, F. 2007. Aspergillus flavus growth response to cinnamon extract and sodium benzoate mixtures. FoodControl. 18 (11):1358-1362.
Lund, B. M. y Eklund, T. 2000. Control of pH and use of organic acids. En: B. M. Lund, T. C. Baird –Parker y G. W. Gould. The Microbiological Safety andQuality ofFood. Vol.1. Aspen Publishers, Inc. EE.UU. pp. 175-199.
Mahmoud , A. L E. 1994. Antifungal action and antiaflatoxigenic properties of some essential oils constituents. Letters Applied in Microbiology. 19:110-113.
Marín, S., Guynot, M. E., Sanchis, V., Arbonés, J. y Ramos, A. J. 2002a. Aspergillus flavus, Aspergillus niger and Penicillium corylophilum spoilage prevention of bakery products by means
of weak-acid preservatives. Journal of Food Science. 67:2271-2277.
Marín, S., Guynot, M. E., Neira, P., Bernadó, M., Sanchis, V. y Ramos, A. J. 2002b. Risk assessment of the use of suboptimal levels of weak-acid preservatives in the control of mold growth on bakery products. International Journal of Food Microbiology. 79:203-211.
Martínez, A. J. y Resnik, S. L. 1995. Status of the mycotoxin problem in Latin America as related to local preservation and storage practices. En: G. V. Barbosa-Cánovas y J. Welti-Chanes (Eds). Food Preservation by Moisture Control.Fundamentals and Applications. Technomic Publishing Company, Inc. EE.UU. pp. 613-633.
Matamoros-León, B., Argaiz, A., López-Malo, A. 1999. Individual and combined effects of vanillin and potassium sorbate on Penicillium digitatum, P.glabrum, and P.italicum growth. Journal of FoodProtection. 62(5):540-542.
Membre, J. M., Kubaczka, M., Chene, M. 2001. Growth rate and growth-no growth interface of Penicillium brevicompactum as functions of pH and preservative acids. Food Microbiology. 18:531-538.
Moreau, C. 1979. Moulds, Toxins and Food. John Wiley. Chichester. 144p.
Moss, M. O. 1996. Mycotoxins. Mycological Research. 100: 513-523.
Moss, M. O. 2000. Toxigenic fungi and mycotoxins. En: B. M. Lund, T. C. Baird –Parker y G. W. Gould. The Microbiological Safety and Quality of Food. Vol.2 . Aspen Publishers, Inc. EE.UU. pp. 1490-1517.
Northolt, M. D., Frisvad, J. C. y Samson, R. A. 1995. Occurrence of food-borne fungi and factors for growth. En: R. A. Samson, E. S. Hoekstra, J. C. Frisvad y O. Filtenborg. (Eds). Introduction to Food-BorneFungi. Cuarta edición. Centraalbureau voor Shimmel-cultures, Baarn. Holanda. pp. 243250.
Ohlsson, T. y Bengtsson, N. 2002. Minimal Processing Technologies in the Food Industry CRC Press. Nueva York. pp. 312.
Parish, M. E. y Carroll, D. E. 1988. Minimum inhibitory concentration studies of antimicrobial combinations against Sacharomycescerevisiae in a model broth system. Journal of Food Science 53:237-239,263.
A. I. Gómez - Sánchez / Temas Selectos de Ingeniería de Alimentos 2 – 2 (2008): 52 – 68
Paster, N., Juven, B. J., Shaaya, E., Menasherov, M., Nitzan, R., Weisslowicz, H. y Ravid, U. 1990. Inhibitory effect of oregano and thyme essential oils on molds and foodborne bacteria. Letters in AppliedMicrobiology. 11:33-37.
Pitt, J. I. y Hocking, A. D. 1997. Fungi and Food Spoilage. Segunda edición. Blackie Academic and Professional, Londres. 593p.
Resnik, S. L 1993. Prevención y control de las micotoxinas durante la cadena de post-cosecha. Simposio Internacional de Conservación de Granos. Río Grande do Sul. Brasil. Sección I, pp. 33-54.
Samapundo, S., Devlieghere, F., De Meulenaer, B., Lamboni, Y., Osei-Nimoh, D., Debevere, J. M. 2007. Interaction of water activity and bicarbonate salts in the inhibition of growth and mycotoxin production by Fusarium and Aspergillus species of importance to corn. International Journal of Food Microbiology. 116(2):266-274.
Sharma, R. P. y Salunkhe, D. K. 1991. Mycotoxins andPhytoalexins. CRC Press, Inc. EE.UU. p.800.
Shelef, L. A., Jyothi, E. K. y Bulgarelli, M. A. 1984. Growth of enteropathogenic and spoilage bacteria
in sage-containing broth and foods. Journal of FoodScience. 49:737-740, 809.
Shewfelt, R. 1987. Quality of minimally processed fruits and vegetables. Journal of Food Quality 10:143-156.
Smith , J. E. y Henderson, R. S. 1991. Mycotoxinsand AnimalFoods. CRC Press. EE.UU. 904p.
Smith, J. E. y Moss, M. O. 1985. Mycotoxins,Formation, Analysis and Significance John Wiley. Chichester. Inglaterra. 154p.
Snowdon, A. L. 1990. Post-Harvest Diseases and DisordersofFruitsandVegetables.Vol.1.General Introduction and Fruits. Wolfe Scientific. Londres. 302p.
Suhr, K.I . y Nielsen, P. V. 2004. Effect of weak acid preservatives on growth of bakery product spoilage fungi at different water activities and pH values. International Journal of Food Microbiology. 95(1):67-78.
Wheeler, K. A., Hurdman, B. F. y Pitt, J. I. 1991. Influence of pH on growth of some toxigenic species of Aspergillus, Penicillium and Fusarium International Journal of Food Microbiology 12:141-149.

Temas Selectos de Ingeniería de Alimentos 2 – 2 (2008): 69 – 78
Temas Selectos de Ingeniería de Alimentos
Desarrollo de un producto de zapote negro (Diospyros digyna) de alta humedad
G. G. Gastélum – Reynoso *, R. Ávila – Sosa y J. A. Guerrero – Beltrán
DepartamentodeIngenieríaQuímicayAlimentos,UniversidaddelasAméricas–Puebla.
SanAndrésCholula,Pue.,México.
Resumen
El zapote negro (Diospyros digyna) es un fruto que se da en el sur de México, contiene grandes cantidades de ácido ascórbico y es altamente perecedero. El potencial para comercializar esta fruta y las preferencias de los consumidores han llevado a considerar el desarrollo de productos de zapote de alta humedad, aplicando la tecnología de obstáculos. El objetivo del presente trabajo fue desarrollar un puré de zapote de alta humedad. Se elaboraron tres formulaciones: un control y dos muestras con actividad de agua (aw) de 0.96 y 0.97, ajustada con sacarosa. A ambas formulaciones se les disminuyó el pH a 4.1 con ácido cítrico y se les adicionó 500 ppm de sorbato de potasio. Las muestras fueron envasadas y almacenadas a 4°C durante 10 días. Se evaluaron parámetros fisicoquímicos (aw, pH, sólidos solubles totales y acidez) y microbiológicos (mohos, levaduras y bacterias mesófilas aerobias BMA). El puré usado como control se deterioró antes de cinco días. El análisis sensorial mostró una “aceptación moderada” en los purés de zapote procesados y sus parámetros fisicoquímicos permanecieron constantes a lo largo del tiempo de almacenamiento. Aunque, el puré de zapote de alta humedad fue un producto estable para el crecimiento de BMA y levaduras, presentó crecimiento de mohos durante el período de almacenamiento a 4°C.
Palabras clave: Zapote negro, productos de fruta de alta humedad, tecnología de obstáculos.
Abstract
Black sapote (Diospyros digyna) is a perishable fruit grown in Southern Mexico and Central America. Due to its delicate flavor and several unfavorable changes associated with freezing and heat treatments, hurdle technology could be an alternative preservation process for black sapote. The purpose of this work was to develop a stable high humidity black sapote puree using hurdle technology including the following factors: two levels of aw (0.96 and 0.97), pH 4.1, addition of potassium sorbate (500 ppm), storage temperature at 4°C during 10 days and periodically evaluated for standard count plate (SCP), pH, aw, soluble solids, acidity, instrumental color, and sensory evaluation. Control sapote puree spoiled before five days of storage. Overall sensory acceptability of purees was not affected. The pH, aw, acidity and soluble solids of preserved sapote purees did not changed during storage. The hurdle technology preservation process for a high moisture sapote puree was effective in microbial inhibition (SCP and yeast), although, mold growth was observed during the storage.
Key words: Black sapote, hurdle technology, high humidity fruit product.
* Programa de Doctorado en Ciencia de Alimentos
Tel.: +52 222 229 2126, fax: +52 222 229 2727
Direccion electrónica: ggastel@hotmail.com
G. G. Gastélum-Reynoso etal. / Temas Selectos de Ingeniería de Alimentos 2 – 2 (2008): 69 – 78
Introducción
Las frutas frescas son buenas fuentes de vitaminas, minerales y fibra; sin embargo, éstassonaltamenteperecederas(López-Malo et al., 1994). En países en vías de desarrollo, se pierde del 50% al 75% del total de la producción de frutas por la falta de infraestructura tecnológica accesible para el adecuado procesamiento de las mismas (Zaccari, 2007). México es productor de frutas tropicales, cuyo mercado mundial ha venido en aumento los últimos años. Las frutas tropicales que se producen en México incluyen: aguacate, plátano, mango, papaya, piña y frutas exóticas como tuna, mamey, pitaya, pitahaya, guayaba y zapote (LópezMalo et al.,1994;Saucedo yArévalo,2003), entreotras.
El zapote negro (Diospyros digyna) pertenecealafamilia Ebenaceae. Esunfruto que se cultiva en Centroamérica y en el sur de México; principalmente en los estados de Tabasco, Guerrero, Chiapas y Puebla. La producción de zapote en el año 2007 fue de 15,721.87 toneladas con un valor de 41.5 millones de pesos (SAGARPA, 2007). El fruto es climatérico y altamente perecedero, sedescribecomo unabaya globosade7 a12 cm de diámetro con cáliz persistente, de cáscaracolorverdebrillanteypresentade6a 10 semillas envueltas por una membrana transparente. El fruto inmaduro posee una pulpa de sabor astringente de color amarillodorado, debido a la presencia de carotenoides. En la madurez fisiológica del zapote, los carotenoides son oxidados y se incrementa la actividad de la enzima polifenoloxidasa (PFO) provocando la oxidación de compuestos fenólicos responsables del color café de la pulpa, la cual es de textura suave y sabor dulce (Arellano-Gómez et al., 2005). El zapote contiene grandes cantidades de ácido ascórbico. Bioquímicamente, el fruto produceetilenoyCO2 queestánrelacionados
con la actividad de las enzimas pectinmetilesterasa y PFO, mismas que intervienen en el ablandamiento y oscurecimiento de la pulpa del fruto durante la maduración. El zapote negro se consume fresco y la pulpa se utiliza en la elaboración de productos como nieves, paletas congeladas ypostres (Arellano-Gómez et al., 2005).
La producción de frutos exóticos como el zapote ysu potencialparacomercializarseen el extranjero, además delapreferenciadelos consumidores por adquirir productos frescos pero estables, han dado como resultado que la industria de alimentos, especialmente de países latinoamericanos, desarrolle productos de frutas de alta humedad basados en la tecnología de obstáculos (Alzamora et al., 1995; Leistner y Gorris, 1995; Welti-Chanes et al.,1996).
La conservación de alimentos en general, se fundamenta en el retraso o prevención de las reacciones fisicoquímicas, bioquímicas y microbiológicas que influyen en las características organolépticas y nutricionales del alimento. Estas reacciones se ven afectadas por la acción de diferentes factores u obstáculos (reducción de la aw, temperatura, pH, etc.). Los métodos tradicionales como el enlatado, el congelado y el secado, están sustentados en la aplicación exhaustiva de un sólo obstáculo provocando el deterioro de la calidad del alimento. La combinación adecuada de varios obstáculos permite conseguir la inocuidad y mejorar la calidad nutricional y sensorial de los alimentos, debido al efecto sinérgico de los mismos, como en el caso de la tecnología de obstáculos o métodos combinados (Tapia et al., 1996; Leistner, 2007).
Algunasfrutasyverdurasdealtahumedad conservados por la tecnología de obstáculos se clasifican como alimentos mínimamente
G. G. Gastélum-Reynoso etal. / Temas Selectos de Ingeniería de Alimentos 2 – 2 (2008): 69 – 78
procesados (Alzamora et al., 2000). Los productosdefrutadealtahumedadpresentan una ligera reducción en la actividad de agua (0.98-0.93); por lo tanto, es necesario el uso de otros factores de conservación, como escaldado, disminución de pH (3.0-4.1), adición de antimicrobianos y agentes antioscurecimiento (< 1,500 ppm) entre otros, para mejorar la estabilidad del producto y en algunos casos sustituir el uso de la temperatura de refrigeración durante el almacenamiento (Welti-Chanes et al., 1996; Leistner,2007).
Las frutas de alta humedad satisfacen las necesidades del consumidor, puesto que generalmente son alimentos poco procesados, inocuos y con características sensoriales ynutricionalesparecidasalas del alimento fresco; además, son baratos y su preparación es simple y de bajo requerimiento de energía (Aguilera et al., 1990; Argaiz et al., 1995; Leistner y Gorris, 1995; Welti-Chanes et al., 1996; Leistner, 2007; Rahman, 2007). Así mismo, estos productossonunaalternativaparareducirlas pérdidas post-cosecha, ya que permiten almacenar las frutas fuera de su temporada y utilizarlas en diversos procesos o productos como confitería, pastelería, productos lácteos, mermeladas, jaleas, entre otros (Leistner,2007).
El objetivo del presente trabajo fue desarrollar un puré de zapote negro (Diospyros digyna) de alta humedad utilizando la tecnología de obstáculos, aplicando como factores de conservación la disminución de la aw, la disminución del pH, la adición de sorbato de potasio y el almacenamiento a temperatura de refrigeración(4°C).
Materialesymétodos
Materiales
Se utilizaron zapotes negros (Diospyra digyna) con características de madurez fisiológica comestible similares. Los zapotes se adquirieron en el mercado local de San PedroCholula,Puebla.Seusósacarosagrado comercial para la disminución de la aw. Se usaron ácido cítrico y sorbato de potasio grado analítico (Merck, México) para la disminución del pH y el control microbiano, respectivamente.
Caracterizaciónfisicoquímicadelafruta
Loszapotesmadurosselavaronypelaron, se removieron las semillas y la pulpa se trituró usando una licuadora (Osterizer mod. 6640, Oster®, México) para preparar un puré. Posteriormente, se evaluaron el contenido de humedad, pH, aw, sólidos solubles totales (ºBrix) y acidez y se realizaron los análisis microbiológicos para la determinación de las cuentas de bacterias mesófilas aerobias (BMA), mohos y levaduras.
Preparacióndelas muestras
Elpurésedividióentres partes; unaparte seutilizócomocontrol ylasotrasdosparala elaboración de los purés con aw disminuida. A estos purés se les adicionó directamente la sacarosa, 30.77g ó 16.03 g por 1500 g de puré de zapote, para reducir la aw a 0.96 ó 0.97, respectivamente. La cantidad de sacarosa adicionada a cada lote se calculó conlaecuacióndeNorrish(1966):
( ) ( ) 2 2 1 sacarosa kX exp X aw = (Ec.1)
Donde k es la constante de Norrish (6.47) (Chirife et al.,1980), X1 es la fracción molar del agua determinada por el porcentaje de
G. G. Gastélum-Reynoso etal. / Temas Selectos de Ingeniería de Alimentos 2 – 2 (2008): 69 – 78
humedad del zapote (86.74%), y X2 es la fracción molar de la sacarosa (los gramos de sacarosa que se utilizaron para calcular la fracción molar de la sacarosa se obtuvieron mediante un proceso de iteración). Una vez obtenida la aw sacarosa se utiliza la ecuación de Ross (Ross, 1975) para determinar la aw en equilibrio del producto de zapote de alta humedad:
aw equilibrio =aw fruta *aw sacarosa (Ec.2)
Donde la aw fruta es la aw inicial del zapote (0.98 + 0.005) y la aw sacarosa es la que se obtuvo mediante la ecuación de Norrish (Ec.1).
Se adicionaron 500 ppm de sorbato de potasio a los purés con aw disminuida y, posteriormente, se les ajustó el pH a 4.1 mediantelaadiciónde7gdeácidocítricopor cada 1500 g de puré de zapote. Las muestras fueron envasadas en frascos de vidrio esterilizados y almacenadas en refrigeración (4°C) durante 10 días. Las determinaciones de aw, pH, sólidos solubles totales, color y acidez se realizaron al inicio del almacenamiento y a los 5 y 10 días. Todos losanálisisseefectuaronportriplicado.
DeterminacióndepHyacidez
Para las mediciones de pH se utilizó un potenciómetro calibrado (Beckman Φ 50, Beckman Instruments, Inc., Fullerton, CA.). El pH de los purés se midió por inmersión del electrodo en una muestra del puré. La acidez se determinó por triplicado usandoelmétodo22.058delaAOAC(1984) y se expresó como porcentaje de ácido cítrico.
Determinacióndehumedadyaw
La humedad se determinó por secado y diferencia de peso, aplicando el método
22.013 de la AOAC (1984). Las mediciones de aw se realizaron por triplicado utilizando higrómetrosdeLuft(Luft,Alemania).
Determinacióndesólidos solublestotales
La medición de sólidos solubles totales (°Bx) se hizo por triplicado empleando un refractómetro digital Atago (ABBE Atago Co., Ltd., Japón). La determinación se realizódirectamenteenelpuréportratarsede muestrashomogenizadas.
Determinacióndel color
Los parámetros de color (L*, a*, b*) se midieron con un colorímetro GardnerColorgard System 05 (BYK-Gardner Inc., Silver Spring, MD) empleando la escala de Hunter. Las mediciones se realizaron colocando el puré en una caja petri. Se calculó el cambio neto de color (∆Ε*) despuésde10díasdealmacenamientoconla siguientefórmula:
Donde ∆L*, ∆a* y ∆b* son los cambios delosparámetrosL*,a*,b*eneltiempocon respecto los valores iniciales del purécontrol (Guerrero-BeltrányBarbosa,2006).
Análisismicrobiológicos
Los análisis microbiológicos se realizaron a los 0, 5, y 10 días de almacenamiento. La determinación de las cuentas BMA se hicieron aplicando la técnica reportada en el manual de bacteriología analítica (BAM, 1984). La determinación de mohos y levaduras se realizó de acuerdo a la Norma Oficial Mexicana (NOM-111-SSA1, 1994). Los medios de cultivo se obtuvieron de Merck (Merck, México). Todos los análisis microbiológicosserealizaronportriplicado.
G. G. Gastélum-Reynoso etal. / Temas Selectos de Ingeniería de Alimentos 2 – 2 (2008): 69 – 78
Evaluaciónsensorial
Se evaluaron el color, la apariencia, la textura, el sabor y el olor por medio de una escalahedónicadecincopuntos.Laescalase convirtió posteriormente a valores numéricos, considerando una escala de 0 a 10, en donde 0 correspondía a “me disgusta muchísimo”, 2.5 “me disgusta moderadamente”, 5 “me es indiferente”, 7.5 “me gusta moderadamente” y 10 “me gusta muchísimo”. La prueba fue llevada a cabo por 11 jueces panelistas no entrenados (Anzaldúa-Morales,1999).
Análisisestadístico
Los resultados se evaluaron mediante un análisis estadístico de varianza (ANOVA). Los datos fueron analizados usando el paquete computacional SPSS (versión 11, Aspire Software Interntional, Ashburn, V.A.). Los valores significativos para los resultados de las pruebas microbiológicas fueron obtenidos mediante el análisis de mínimadiferenciasignificativa(LSD)conun nivel de confianza del 95%. Para obtener los valores significativos de los resultados de la evaluación sensorial se utilizó una prueba de t para medias de dos muestras emparejadas conunniveldeconfianzadel95%.
neutralidad y su elevada aw lo hacen un alimentosusceptiblealadescomposición.
Tabla I. Características del zapote fresco
(Diospyra digyna )
CaracterísticaValor
pH6.660 +0.100
aw 0.980 +0.005
Sólidos solubles totales (%)15.630 + 0.250
Acidez (% )a 0.008 +0.001
Humedad (%)b 86.740 + 0.080
Pulpa(%)69.450 + 1.050
Cáscara (%)25.600 + 2.000
a Ácido cítrico
b Base húmeda
Característicasfisicoquímicasdel puréde zapotedealtahumedad
Resultadosydiscusión
Características fisicoquímicas del zapote fresco
El zapote es un fruto poco estudiado, por lo cual fue necesario llevar a cabo la caracterización del mismo (Tabla I). El zapote es un alimento altamente perecedero debido a su intensa actividad respiratoria durante la etapa de maduración (ArellanoGómez et al., 2005); además, como se observa en la Tabla I, su pH cercano a la
En la Tabla II se muestran las características fisicoquímicas de los purés de zapote de alta humedad. Los valores de pH, los sólidos solubles totales y la acidez de los purés de zapote procesado y del control permanecieron sin cambio significativo (p< 0.05) durante los 10 días de almacenamiento a 4°C. Sin embargo, como se observa en la Tabla III, para los parámetros de color L*, a*, b* y ∆E* (cambio neto de color) se encuentran diferencias estadísticamente significativas (p< 0.05) entre el control y las muestras con aw disminuidaparacadadíade evaluación, a excepción del parámetro L* en el día0 yelparámetro a*eneldía10,enlos que los purés de zapote de alta humedad yel control no mostraron diferencias significativas entre sí. En estudios hechos con papaya (López-Malo et al., 1994), durazno,perayciruela(Catalán,1999),seha encontrado que el parámetro L* cambia debidoalaadicióndesacarosaalafruta.Por otro lado, la degradación del ácido ascórbico -la cual produce pigmentos oscuros-, así como la oxidación de los compuestos fenólicos debida a la acción de las enzimas fenilalaninaaminoliasa (FAL) y la PFO,
G. G. Gastélum-Reynoso etal. / Temas Selectos de Ingeniería de Alimentos 2 – 2 (2008): 69 – 78
pudieran ser las responsables de los cambios en estos parámetros (Arellano-Gómez et al., 2005).
Análisismicrobiológicos
En la Tabla IV se muestran los valores de carga microbiológica de los purés de zapote de alta humedad almacenados a baja temperatura. Como resultado de la manipulación del zapote durante el pelado y la elaboración del puré, las cuentas iniciales deBMAdelpurécontrol fueronaltas(1.29x 105 UFC/g); sin embargo, para los purés de zapoteconaw de0.97y0.96,elconteoinicial de BMA (3 x 103 UFC/g) fue significativamente menor (p<0.05) comparado con el puré control, debido probablemente a la acción inmediata de los factoresdeconservación.Despuésdelosdías 5 y 10, las cuentas de BMA disminuyeron gradualmente en los purés de zapote de alta humedad, evidenciando el efecto de los obstáculos(pH,aw,sorbatodepotasio)enlos purés procesados comparados con el puré
II.
control. Por otra parte, aunque las cuentas iniciales de levaduras tanto del control como de los purés de alta humedad fueron del orden de 101 UFC/g, se observó un aumento significativo (p < 0.05) para el puré control conrespectoalos purés deaw 0.97 y0.96,en los recuentos después de 5 y 10 de almacenamiento.Encambio,enlacuentasde mohos no hubo diferencias significativas entre el control y los purés con aw reducida, ni a los 5, ni a los 10 días de almacenamiento. Sin embargo, los resultados muestranquenohubo efectoinhibidordelos factores de conservación en los purés tratados, ya que se alcanzaron niveles hasta de2x107 UFC/g.
La carga microbiana inicial tiene un papel importante en la vida de anaquel del producto. Los microorganismos tienden a adherirse a la superficie de la fruta formando películas y de esta manera se hacen más resistentes a los obstáculos o factores presentes en el producto (Gianotti et al., 2001). La operación de escaldado ayuda a
fisicoquímicas de los purés de zapote de alta humedad almacenados a 4°C durante 10 días
Actividad de agua 0.98 ** 0.970.96
Día 0
pH6.350 + 0.170a 4.110 + 0.100d 4.110 + 0.100g
Sólidos solubles totales (%) 15.370 + 0.010b 28.93 0+ 0.150e
+ 0.240h
Acidez (%)* 0.008 + 0.000c 0.060 + 0.005f 0.040 + 0.001i
Día 5
pH 6.370 + 0.200a 4.070 + 0.030d 4.100 + 0.000g
Sólidos solubles totales (%) 15.01 + 0.020b 28.530 + 0.210e 36.760 + 1.050h
Acidez (%)*0.008 + 0.001c 0.060 + 0.009f 0.040 + 0.006i
Día 10
pH 6.480 + 0.230a 4.370 + 0.150d 4.190+ 0.000g
Sólidos solubles totales (%) 14.980 + 0.040b 28.410+ 0.150e 36.320 + 0.880h
Acidez (%)* 0.008 + 0.000c 0.050 + 0.001f 0.040 + 0.003i * Ácido cítrico.
** Puré control.
a,b,c,d,e,f,g,h,i Mismas letras en las columnas significan que no hubo cambios en los atributos de acuerdo al análisis de medias con un nivel de confianza de 95%. Los análisis se realizaron para cada atributo (pH, sólidos solubles, acidez) y comparando los cambios ocurridos en los días de almacenamiento (0, 5 y 10).
G.
G. Gastélum-Reynoso
etal. / Temas Selectos de Ingeniería de Alimentos 2 – 2 (2008): 69 – 78
Tabla III. Parámetros de color de purés de zapote de alta humedad almacenados a 4°C durante 10 días L*a*b*
Día 0 0.98** 6.35 + 0.17a 2.33 + 0.28d 1.54 + 0.07f 0.97
Día 5
+
Día 10
+ 0.10b
+ 0.14d 1.92 + 0.28g
+ 0.16b 2.21 + 0.18d 1.64 + 0.29g
***Cambio neto de color (∆E*)
0.98** 0.97 + 0.07a 0.97 1.23 + 0.12b 0.96 1.58 + 0.17c
** Puré control.
a,b,c,d,e,f,g Letras diferentes en la misma columna indican cambios significativos de acuerdo al análisis de medias LSD con un nivel de confianza de 95%, entre las muestras y el control ocurridos en los días de almacenamiento (0, 5 y 10)
***Cambio neto de color después de 10 días de almacenamiento a 4°C.
reducir dramáticamente las cuentas iniciales de microorganismos. Estudios hechos por Alzamora et al. (1993), muestran que después de escaldar trozos de papaya, durazno y piña se observa una reducción del 95% de las cuentas iniciales de BMA. El escaldado no formó parte del proceso para obtener los purés de zapote de alta humedad. Sin embargo, los obstáculos aplicados a los productos de zapote fueron suficientes para la inhibición de BMA y levaduras; pero esto no ocurrió para los mohos, debido probablemente a los niveles de aw (0.96 y 0.97) yal contenido de nutrientes del zapote, mismos que favorecen el crecimiento de mohos como Aspergillus sp y Penicillium
sp. (Frazier y Westhoff, 2003). No obstante, en estudios realizados por Parra et al. (1992) se logró la inhibición de Aspergillus flavus, A. ochraceus y Penicillium sp. con una combinación deaw 0.99,pH3.5 y50 ppmde sorbato de postasio en sistemas modelo. El efecto sinérgico de la reducción de la aw, el pH y el uso de sorbato de potasio disminuye la velocidad de las reacciones metabólicas y afecta los mecanismos de osmorregulación celular provocando que los microorganismos sean incapaces de recuperar su homeostasis (LeistneryGorris,1995).Losácidoscomoel sórbico y el cítrico son solubles en su forma no disociada favorecida por valores bajos de pH y penetran a la membrana celular,
G.
G. Gastélum-Reynoso
etal. / Temas Selectos de Ingeniería de Alimentos 2 – 2 (2008): 69 – 78
Tabla IV. Cargas microbiológicas de los purés de zapote de alta humedad almacenados a 4°C durante 10 días
Días
0510
Bacterias Mesófilas Aerobias (UFC/g)
0.98** (1.29 + 0.24)x105 a (1.56 + 0.27)x107 a (7.30 + 0.41)x108 a
0.97 (3.30 + 0.41)x103
(9.64 + 0.13)x102
(3.97 + 0.10)x101 c (1.00 + 0.00)x101 c
(7.57 + 0.95)x101 b 0.96 (3.60 + 0.45)x103
Levaduras (UFC/g)
0.98** (2.40 + 0.91)x101 d (5.57 + 0.86)x102 d (1.67 + 0.56)x104 d
0.97(6.00 + 0.71)x101 e (2.37 + 0.20)x101 e (1.00 + 0.00)x101 e 0.96 (3.70 + 0.45)x101 d (1.53 + 0.25)x101 e (1.00 + 0.00)x101 e
Mohos (UFC/g)
0.98** (2.81 + 0.23)x102 f (6.53 + 0.95)x104 f (2.04 + 0.43)x107 f
0.97 (3.30 + 0.75)x101 g (8.13 + 0.41)x104 f (1.88 + 0.12)x107 f
0.96 (6.40 + 0.11)x101 g (1.02 + 0.7)x104 f (2.02 + 0.18)x107 f
** Puré control.
a,b,c,d,e,f,g Las letras en las columnas significan grupos diferentes de acuerdo al análisis de medias LSD con nivel de confianza del 95%. Los análisis se realizaron para cada grupo de microorganismos (BMA, levaduras y mohos) entre el control y las muestras procesadas.
causando la acidificación del interior de la célula y la reducción del paso de solutos debido a cambios en el potencial de membrana (Restaino et al., 1982; LópezMalo et al., 1994); dando como resultado, la inhibición de bacterias, mohos y levaduras. Este efecto se ha observado para varios microorganismos; por ejemplo, Alzamora et al. (1993) reporta diferentes combinaciones parainhibirelcrecimientode Saccharomyces cerevisiae (aw 0.97, pH 4.0 y 500 ppm de sorbatodepotasio/ aw 0.93,pH3 y100ppm sorbatodepotasio).
Evaluaciónsensorial
En la Tabla V se muestran los resultados de la evaluación sensorial. Los resultados revelan que los parámetros con valores más altos fueron la textura yel sabor para el puré con aw de 0.97; yel color yla textura para el puré con aw de 0.96. La apariencia fue el atributo con calificación más baja para ambos purés, debido probablemente a las
características inherentes del zapote, puesto quesetrata deun fruto poco conocido con la pulpadecolornegro,inusualenalimentosde este tipo. Aunque se observan calificaciones que van desde 6.4 hasta 8, el promedió general reveló que las dos muestras procesadas caen en el nivel de “me gusta moderadamente”. Así también, se encontró que no hubo diferencias significativas entre lascalificaciones obtenidas porlosproductos procesados para ninguno de los atributos sensorialesevaluados.
Conclusiones
Seconcluyequelosobstáculosseleccionados para la elaboración de los purés de alta humedad fueron suficientes para mantener estables las características fisicoquímicas de los purés procesados, obteniendo productos de aceptación sensorial moderada. Sin embargo, no se logró obtener un producto
G. G. Gastélum-Reynoso etal. / Temas Selectos de Ingeniería de Alimentos 2 – 2 (2008): 69 – 78
Tabla V. Análisis sensorial de los purés de zapote de alta humedad despúes de 5 de almacenamiento a 4°C**
** El puré control presentó crecimiento de mohos a los 5 días de almacenamiento; por lo tanto no fue evaluado sensorialmente.
a,bc,d,e Letras iguales en cada columna indican que no hay diferencia significativa de acuerdo a la prueba de t con un nivel de 95% de confianza.
totalmente libre de microorganismos deteriorativos debido al crecimiento de mohos durante el período de 10 días de almacenamientoa4°C.
Se recomienda el escaldado de la fruta después de pelarla y antes de procesarla, además de probar diferentes combinaciones de los factores de conservación (aw, pH, concentraciones de sorbato de potasio y refrigeración) para lograr la inhibición de mohos.
Es necesario desarrollar y dar a conocer nuevos productos como la frutas de alta humedad, que permitan conservar frutas regionales con características similares a las de su estado fresco, reducir pérdidas postcosecha y disponer de ellas tanto en su temporadacomofueradelamisma.
Fruits and Vegetables. Aspen Publishers, Inc. Gaithersburg, Maryland.
Alzamora, S. M., Tapia, M. S. y Welti-Chanes, J. 1993. Application of combined methods technology in minimally processed fruits. Food ResearchInternational. 26:125-130.
Alzamora, S. M., Cerruti, P., Guerrero, S. y LópezMalo, A. 1995. Minimally processed fruits by combined methods. En: G. Barbosa y J. WeltiChanes (Eds.). Food Preservation by Moisture Control. CRC Press. EE.UU.
Anzaldúa-Morales, A. 1999. La Evaluación Sensorial de los Alimentos en la Teoría y la Práctica. Acribia. Zaragoza, España. 185 p.
AOAC. 1984. Official Methods of Analysis. Decimocuarta edición. Association of Official Analytical Chemists. Washington, D.C.
Arellano-Gómez, L., Saucedo, C. y Arévalo, M. L. 2005. Cambios bioquímicos y fisiológicos durante la maduración del fruto de zapote negro (Diospyros digyna jacq). Agrociencia 39(2):173181.
Referencias
Aguilera, J. M., Chirife, J., Tapia, M. S. y WeltiChanes, J. 1990. Programa Iberoamericano de Ciencia y Tecnología para el Desarrollo. V Centenario CYTED-D. Subprograma Tratamiento y Conservación de Alimentos. Inventario de Alimentos de Humedad Intermedia Tradicionales en Ibero América. Instituto Politécnico Nacional. México.
Alzamora, S. M., López-Malo, A. y Tapia, M. S. 2000. Overview. En: S. M. Alzamora, A. LópezMalo y M. S. Tapia (Eds.). Minimally Processed
Argaiz, A., López-Malo, A. y Welti-Chanes, J. 1995 Considerations for the development and the stability of high moisture fruit products during storage. En: G. Barbosa y J. Welti-Chanes (Eds.). Food Preservation by Moisture Control. Fundamentals and Applications. CRC Press. EE.UU.
BAM. 1984. BacteriologicalAnalyticalManual. Sexta edición. Association of Official Analytical Chemists. Washington, D.C.
Catalán, E. 1999. Transformación de frutas de alta humedad conservadas pormétodoscombinados en productos de fruta comerciales. Tesis de Licenciatura. Universidad de las Américas. Puebla, México.
G. G. Gastélum-Reynoso etal. / Temas Selectos de Ingeniería de Alimentos 2 – 2 (2008): 69 – 78
Chirife, J., Ferro-Fontan, C. y Benmergui, E. 1980
The prediction of water activity in aqueos solutions in connection with intermediate moisture foods. IV. aw prediction in aqueous nonelectrolyte solutions. JournalofFoodTechnology 15:59-70.
Frazier, W. C. y Westhoff, D. C. 2003. Microbiología de los Alimentos. Cuarta edición. Acribia. Zaragoza, España.
Gianotti, A., Saccheti, G., Guerzoni, M. E. y DallaRosa, M. 2001. Microbial aspects on short-time osmotic treatment of kiwifruit. Journal of Food Engineering 49:265-270.
Guerrero-Beltrán, J. A. y Barbosa, G. 2006. Inactivation of saccharomyces cerevisiae and polyphenoloxydase in mango nectar treated with UV light. Journal of Food Protection. 69(2):362368.
Leistner, L. 2007. Combined methods for food preservation. En: M. Rahman (Ed.). Handbook of Food Preservation. Segunda edición. CRC, Press. Boca Ratón, Florida. pp. 867-893.
Leistner, L. y Gorris, G. 1995. Food preservation by hurdle technology. Trends in Food Science and Technology 61:41-46.
López-Malo, A., Welti-Chanes, J., Palou, E. y Corte, P. 1994. Shelf-stable high moisture papaya minimally processed by combined methods. Food ResearchInternational 27:545-553.
NOM-111-SSA1. 1994. Norma Mexicana. Guía para la redacción, estructuración y presentación de las Normas Mexicanas. Secretaría de Patrimonio y Fomento Industrial. México.
Norrish, R. S. 1966. An equation for the activity coefficients and equilibrium relative humidities of water in confetionery syrup. Journal of Food Technology. 1:25-39.
Parra, L., López-Malo, A. y Argaiz, A. 1992. Efecto del pH y concentración de sorbato de potasio sobre la germinación y la velocidad de crecimiento de hongos. AvancesenIngenieríaQuímica. AMIDIQ, A.C. México.
Rahman, M. 2007. Food preservation: Overview. En: M. Rahman (Ed.). Handbook of Food Preservation. Segunda edición. CRC Press. Boca Ratón, Florida. pp. 3-18.
Restaino, L., Komatsu, K. y Syracause, M. 1982. Effects of acids on potassium sorbate inhibition of
food related microorganism in culture media. JournalofFoodScience. 47:134-138.
Ross, K. D. 1975. Estimation of water activity in intermediate moisture foods. Food Technology 29(3):26-29.
SAGARPA. 2007. Servicio de información agroalimentaria y pesquera. http://www.siap.sagarpa.gob.mx, accesada 10/11/08
Saucedo, C. y Arévalo, M. L. 2003. Fisiología pre y post cosecha de algunos frutos exóticos de México con potencial de comercialización http://www.chapingo.mx/agroind/congreso/ponenc ia/ponencias/Mesa%20V/Fisiologia%20pre%20y %20postcosecha....pdf., accesada 22/10/2008
Tapia, M. S., Alzamora, S. M. y Welti-Chanes, J. 1996. Combination of preservation factors applied to minimal processing of foods Critical Reviewsin FoodScienceandNutrition. 36:629-659.
Welti-Chanes, J., Vergara , F. y López-Malo, A. 1996. Minimally processed food. State of the art and future. En: P. Fito y G. Barbosa (Eds.). Food Engineering. Chapman y Hall. EE.UU.
Zaccari, F. 2007. Cosecha y poscosecha de frutas y hortalizas http://www.fagro.edu.uy/~poscosecha/docs/Materi ales%20de%20Apoyo/P%C9RDIDAS%20EN%20 POSCOSECHA.pdf, accesada 18/11/2008

Temas Selectos de Ingeniería de Alimentos 2 – 2 (2008): 79 – 86
Temas Selectos de Ingeniería de Alimentos
Efecto de agentes reductores en la propagación de Lactobacillus casei en leche
N. A. Santiesteban – López*, T. Cerón – Carrillo, A. López – Malo
DepartamentodeIngenieríaQuímicayAlimentos,UniversidaddelasAméricas–Puebla.
SanAndrésCholula,Pue.,México.
Resumen
En la actualidad los consumidores pueden seleccionar alimentos funcionales a partir de una amplia variedad de estos productos que contienen componentes como proteínas, carotenos, fibra dietética e inclusive microorganismos llamados “probióticos”, entre los que se encuentran los pertenecientes a los géneros Lactobacillus y Bifidobacterium. En este trabajo se evaluó el efecto de la adición de ácido ascórbico y Lcisteína como agentes reductores del potencial redox (Eh), en la propagación de un microorganismo prebiótico, Lactobacillus casei, en leche. Los agentes reductores se adicionaron de manera individual o combinada a la leche en concentraciones de 0, 100 y 200 ppm, con la finalidad de obtener la combinación que permitiera el máximo crecimiento del cultivo probiótico. Utilizando un análisis tipo superficie de respuesta, se evaluaron las diferentes combinaciones de ácido ascórbico y cisteína sobre el número de unidades formadoras de colonias de L. casei. La propagación del microorganismo se analizó por medio de la técnica de recuento en placa en agar MRS incubando en condiciones anaeróbicas a 35 ± 1°C durante 72 horas. La combinación de 150 ppm de ácido ascórbico y 200 ppm de cisteína permitió obtener un recuento máximo de L.casei, con una población superior a 1012 UFC/mL. Se demostró que la combinación de los dos agentes reductores resultó más efectiva que su uso en forma individual.
Palabras clave: probióticos, agentes reductores, ácido ascórbico, L-cisteína, L.casei
Abstract
Nowadays, Consumers can select a functional food from a wide variety of foods containing functional components such as protein, carotenes, dietary fiber and even microorganisms called "probiotics", which include those belonging to the genera Lactobacillus and Bifidobacterium. In this study the effect of the addition of ascorbic acid and L-cysteine as reducing agents of the redox potential (Eh) in the growth of Lactobacillus casei in milk was evaluated. Reducing agents are added either individually or combined to milk with the following concentrations: 0, 100 and 200 ppm in order to obtain the most favorable combination that would allow the maximum growth of probiotic culture in milk. Using a factorial experimental design, the effects of ascorbic acid and L-cysteine on the number of CFU / mL after 4 days of incubation at 35 ± 1 ° C were evaluated. The growht of the microorganism was analyzed by the technique of counting on MRS agar plate incubating under anaerobic conditions at 35 ± 1 ° C for 72 hours. The combination of 150 ppm of ascorbic acid and 200 ppm of L-cysteine yielded a maximum count of L.casei, with a population of more than 1012 CFU / mL. Results demonstrates that the combination of the reducing agents was more effective compared to the use of these agents individually
Keywords: Probiotics, reducing agents, ascorbic acid, L- cysteine, Lactobacillus casei
* Programa de Doctorado en Ciencia de Alimentos
Tel.: +52 222 229 2126, fax: +52 222 229 2727
Direccion electrónica: asantiesteban2@hotmail.com
N. A. Santiestaban-López et al. / Temas Selectos de Ingeniería de Alimentos 2 – 2 (2008): 79 – 86
Introducción
En los últimos años ha aumentado considerablemente el interés de los consumidoresporconocerlarelaciónentrela dieta y la salud. Se ha demostrado que alimentos tradicionales como las frutas, las verduras, el pescado y la leche, contienen componentes más allá de los nutrientes típicos que resultan benéficos para el organismo (Institute of Food Technology, 2005).
En la décadadelos años 80,surgieron los alimentos funcionales dados a conocer por las autoridades sanitarias japonesas. Estos alimentos toman diferentes formas, por ejemplo, tienen componentes bioactivos relacionados actualmente con efectos benéficos paralasalud, oestán fortificados o mejorados, específicamente para reducir riesgosdeenfermedades enciertos gruposde personas (European Food Information Council, 2005). Los consumidores pueden seleccionar entre una amplia gama de alimentos que contienen componentes funcionales, como proteínas, carotenoides, fibra dietética e inclusive microorganismos llamados “probióticos”. El término probiótico proviene de la palabra griega que significa “para la vida”, usado por primera vezparadefinirsustancias producidas porun lactobacilo que estimula el crecimiento de otros microorganismos (Naidu et al., 1999; Ouwehand et al., 1999). Sin embargo, Fuller (1989) definió a los probióticos como “un suplemento microbiano vivo que afecta benéficamente al animal huésped, mejorando su balance microbiano intestinal”. A los probióticos se les adjudican beneficios como mejorar los movimientos peristálticos, reducir los problemas de intolerancia a la lactosa, inhibir microorganismos patógenos, reducir los niveles de colesterol absorbidos, entre otros. Los géneros de los microorganismos Lactobacillus y Bifidobacterium pertenecen a este grupo,
pudiendo ser incorporados a los alimentos probióticos.
El mayor reto asociado con la incorporación de microorganismos probióticos en el desarrollo de alimentos funcionales, es la retención de su viabilidad en el procesamiento y almacenamiento y durante el paso por el sistema gastrointestinal. Para que estos microorganismos puedan llegar viables al intestino, es necesario que la bacteria probiótica sobreviva en número suficiente en el producto, de tal forma que el mismo contenga 106 UFC/mL, al momento de su consumo (Blanchette et al., 1996). Debido a esto, últimamente se han aplicado diversos procedimientos para ayudar a los probióticos allegarasusitiodeaccióndeformaviabley en cantidad suficiente. Para que la propagación de estos microorganismos se mantenga, muchos autores (Dave y Shah, 1997a,b,ShishatayShah.,1999;Kim, et al., 2002) han utilizado el cambio del potencial redox, ya que a mayores magnitudes de este potencial, se inhibe el crecimiento de las bacterias anaerobias, debido al oxígeno disuelto que hay en el medio. El potencial redox se define como la medida de la facilidad con que un sustrato pierde o gana electrones. Cuando un elemento pierde electrones,sediceque hasidooxidadoyque se ha reducido en caso contrario; cuanto más oxidadaestáunasustanciamáspositivoessu potencial redox (Eh) y viceversa en el caso de las sustancias reducidas (Díaz et al., 2002). La propagación y sobrevivencia de bacterias ácido lácticas se puede ver favorecida con el uso de compuestos reductores que generan valores negativos de Eh y se asocian a condiciones reductoras. El objetivo de este trabajo fue evaluar el efecto de dos agentes reductores, el ácido ascórbico y la L-cisteína, tanto en forma individual como conjunta, en la propagación del probiótico Lactobacillus casei enleche.
Santiestaban-López
Materialesymétodos
Materiaprima
Como materia prima se empleó leche entera de marca comercial “Lala”, ultrapasteurizada, adquirida en tiendas de autoservicio de la ciudad de Puebla. El ácido ascórbico y la L-cisteía usados, fueron grado reactivo (ambos Sigma Aldrich Chemicals, St.Louis,MO,EE.UU.).
Microorganismo
Lactobacillus casei se aisló a partir del producto lácteo fermentado Marca Yakult. Para esto, 100 mL del producto se centrifugaron a 13,000 rpm durante 10 minutos. El sedimento obtenido conteniendo las células de L.casei, fue suspendido en 10 mL de agua estéril, para obtener una población aproximada de 1010 UFC/mL. La suspensión de células fue usada para inocularlossistemasdeestudio.
Metodología
Efecto de los agentes reductores en la propagaciónde Lactobacilluscasei
Se inoculó 1 mL de la suspensión conteniendolascélulasde L.casei en100mL deleche, adicionando la L-cisteína yel ácido ascórbico de acuerdo al diseño factorial mostradoenlaTablaI.
Una vez inoculados los sistemas, se mantuvieron a 35 ± 1°C en una incubadora (Imperial Lab Line III, IL, EE.UU.) a condiciones estáticas, a fin de favorecer la anaerobiosis. Se realizó el recuento de los microorganismosdecadaunodelossistemas altiempo0yalos4díasdeincubación.
Para realizar los recuentos se prepararon diluciones 10-1, 10-2, 10-3, 10-4, 10-5 y10-6 en
Tabla I. Sistemaspropuestospara la adición con ácido ascórbico y L -cisteína
SistemaÁcido ascórbico (ppm) L -cisteína (ppm)
solución salina isotónica estéril, sembrando por duplicado, por vertido en placa en agar MRS (Difco, Detroit, MI, EE.UU.), incubando en condiciones de anaerobiosis durante72ha35±1°C(Song et al.,2003).
Análisisestadístico
Para evaluar el efecto de los agentes reductoresysuscombinaciones,serealizóun análisis de superficie de respuesta por medio del programa Minitab versión 15 (Minitab Inc, EE.UU). El modelo cuadrático asociado aldiseñoexperimentales:
Donde:
Y=log(N),UFC/mL
ßi =coeficientesdeajustedelmodelo
X1 =concentracióndelácido ascórbico(ppm)
X2 = concentraciónde L-cisteína (ppm)
Se realizó un análisis de varianza (p>0.05),parapredecirelcomportamientode L.casei en diferentes condiciones y proponer concentraciones de los agentes reductores que maximizaran la propagación del probiótico.
N. A. Santiestaban-López et al. / Temas Selectos de Ingeniería de Alimentos 2 – 2 (2008): 79 – 86
Resultadosydiscusión
Efecto de ácido ascórbico y cisteína sobre la propagaciónde Lactobacilluscasei
Las colonias características de L.casei en agar MRS se muestran en la Fig.1. Estas colonias son blancas, brillantes y de aspecto mucoso.
Los resultados obtenidos de los recuentos microbianos para los sistemas formulados con las diferentes concentraciones de ácido ascórbico y L-cisteína se presentan en la Tabla II. En todos los casos, el número de células viables aumentó aunque no en la misma proporción; preliminarmente se ve diferenciaconrespectoalcontrol,asímismo, cuando los agentes reductores se encontraron de manera individual o combinada, la propagación del microorganismo fue mayor,
Ácido ascórbico (ppm) L -cisteína (ppm)
sobretodoenestaúltimasituación(TablaII). Seseleccionaron4díasdeincubacióndebido a que estudios anteriores demostraron que para este tiempo se presenta el máximo crecimiento de L.casei en leche. Después de los 4 días de incubación se presentó disminución en el número de células de L. casei (datos no mostrados en la Tabla II), en comparación con el control (0 ppm ácido ascórbico,0ppm L-cisteína) (Cerón,2008).
Por otro lado, se observó una reducción del pH de la leche desde 6,7 hasta 4,0-4,7 (datos no mostrados), debida probablemente a la producción de ácido láctico, ya que Lcasei es una bacteria homofermentativa que producedichoácido.Estemicroorganismose puede seguir desarrollando hasta valores aproximadosdepHde3,0;pordebajodeeste valor, el crecimiento de L-casei se inhibe (Cerón,2008).
Uno de los compuestos que actúa como neutralizante del oxígeno disuelto es el ácido ascórbico, reduciendo el potencial redox e incrementando la propagación de bacterias ácido lácticas como es el caso de L. casei (Brunner et al., 1993 a, b). Por otra parte, la L-cisteína es un aminoácido que contiene sulfuro, que administra nitrógeno amino como un factor de crecimiento para las
Día 0Día 4 a
Log (UFC/mL)
0010.62±0.5210.77±0.09
01009.93±1.5210.97±0.23
020010.29±0.2911.41±0.94
100010.17±0.8112.48±0.59
10010010.42±0.6911.6±0.59
10020010.27±0.9212.76±0.02
200010.36±0.611.88±0.43
20010010.42±0.511.34±0.26
20020010.01±0.5612.62±0
a: Incubación a 35°C
Tabla III.Análisis de varianza del modelo cuadrático reducido ajustado con los datos de los recuentos de L. casei bajo las distintas condiciones del diseño experimental.
FuenteGLSCCMFp
Regresion4
7.651.919.350.001
lineal2 3.342.4111.780.001
Cuadrática2 4.302.1510.520.002
Error residual13 2.660.20
Falta de ajuste4 0.760.190.90.504
Error puro9 1.900.21
Total17 10.31
GL : Grados de libertad
SC : Suma de cuadrados
CM : Cuadrado medio
F : Tabla F
p : Nivel de significancia
bacterias ácido lácticas y al mismo tiempo reduce el potencial redox favoreciendo el crecimiento de estas bacterias anaerobias (DaveyShah,1997b).
Los datos obtenidos fueron analizados estadísticamente por medio de un análisis de varianza (ANOVA) cuyos resultados se muestran en la Tabla III. Se observa que los efectos lineales y cuadráticos fueron significativos (p<0.05). La interacción fue eliminada del modelo (Ec.1), ya que no fue significativa (p>0.05). El modelo cuadrático reducido, cuyos coeficientes se muestran en la Tabla IV, es adecuado para predecir el comportamientode L. casei, yaquelaprueba de falta de ajuste no fue significativa (p>0.05) y el modelo explica el 86% de la variabilidaddelosresultados(R2 0.862).
A partir del modelo cuadrático reducido seconstruyóunagráficadecontorno(Fig.2), para mostrar el efecto de la concentración de ácido ascórbico y L-cisteína en el desarrollo de L. casei.Existenzonasdemarcadasporlas concentraciones de los agentes reductores que favorecen el crecimiento de L. casei, teniendo que el máximo (dentro de las concentraciones evaluadas) se encuentra cuando la L-cisteínase adicionaen 200 ppm,
en combinación con concentraciones de ácido ascórbico entre 75 y 175 ppm. De aquí que se recomiende la adición de 150 ppm de ácidoascórbicoy200ppmde L-cisteína.
Tabla IV. Coeficientes estimados (ß) del modelo cuadrático reducido a para predecir el comportamiento de L. casei bajo
Término Coeficiente
ß0 Constante1.10E+01
ß1 Ácido Ascórbico2.01E-02
ß2 L -Cisteína -1.09E-05
ß3 Ascórbico*Ascórbico-7.80E-05
ß4 Cisteína*Cisteína6.84E-05 a: Ecuación 1
Los beneficios de la incorporación de agentesreductoresdelpotencialredoxparala propagación de bacterias ácido lácticas, han sido estudiados por varios investigadores. Dave y Shah (1997a,b) comprobaron que la L-cisteína además de proporcionar nitrógeno como factor de crecimiento, reduce el potencial redox y el oxígeno molecular disuelto, favoreciendo las condiciones de crecimiento de las bacterias anaerobias (L.casei). Estos autores reportan que el ácido ascórbico también reduce el potencial redox, observándose que en muchos casos es más efectivo cuando está en combinación con Lcisteína.
Brunner et al. (1993 a, b) han demostrado que el uso de compuestos reductores como ácido ascórbico y L-cisteína es importante para la propagación de bacterias ácido lácticas,duranteelalmacenamientodeleches fermentadas. El ácido ascórbico actúa como agente reductor de oxígeno molecular y su uso es permitido en jugos de frutas y otros productos en donde se requiere favorecer procesosfermentativosanaerobios.
La adición de ácido ascórbico de manera individual, favoreció el desarrollo de L.casei en concentraciones de 100 o 200 ppm (Tabla II). Un resultado similar fue reportado por Dave y Shah (1997c), quienes demostraron que la adición de ácido ascórbico a la formulación de yogurt probiótico ayudó a la supervivencia de las bacterias ácido lácticas y atribuyeron los efectos benéficos a la disminución del contenido de oxígeno disuelto a la reducción del potencial redox. Estos autores sugieren emplear 250 ppm de ácido ascórbico, a fin de mantener a niveles bajos el potencial redox durante al menos 20 días de almacenamiento del yogurt probiótico y asegurar la supervivencia de L.acidophillus.
Los resultados de la adición de L-cisteína de manera individual obtenidos en el presente estudio (Tabla II), mostraron que hubo un efecto importante sobre la propagación de L-casei, siendo más notorio cuando fueron añadidas 200 ppm del aminoácido. Este resultado se puede comparar con el obtenido por Dave y Shah (1997b), quienes demostraron que con concentraciones de L-cisteina de 250 y 500 ppm se logró favorecer el crecimiento de L. acidophilus, adiferenciadeaquellossistemas que fueron adicionados con bajas cantidades del aminoácido (50 ppm) o en los que no se adicionó L-cisteína.
Esto mismo ha sido observado por otros investigadores. Kim et al. (2002), reportan resultados similares a los obtenidos en el presente estudio, adicionando L-cisteína como agente reductor del potencial redox en cuatrodistintas marcasdeyogurtcomercial y evaluaron la supervivencia de L.casei como probiótico. Estos autores observaron que el medio generó un ambiente óptimo de crecimiento y desarrollo para este tipo de microorganismo, durante 10 días de almacenamientorefrigeradodelosyogures.
N. A. Santiestaban-López et al. / Temas Selectos de Ingeniería de Alimentos 2 – 2 (2008): 79 – 86
En otro estudio realizado por Shishata y Shah (1999)sedemostró queal disminuir el pH de leche ultrapasteurizada a valores cercanos a 4.6 (pH óptimo de crecimiento de las bacterias ácido lácticas), se presentó la propagaciónde L.acidophillus
Por otraparte, Shah (2000) comprobó que cuando el pH del medio de un sistema real (yogurt) disminuye a valores menores o cercanos a 3,0, la propagación de L. casei se ve disminuida debido a la alta concentración de ácido láctico, lo cual fue comprobado en la presente investigación, sólo que en este caso se empleó leche como sistema modelo. Sin embargo, cuando se adicionó L-cisteína para disminuir el potencial redox se logró una mayor supervivencia del probiótico, reafirmando que el aminoácido actúa como un poderoso agente reductor, promoviendo condiciones para disminuir la cantidad de oxígeno disuelto, lo que favorece al desarrollode L-casei.
Conclusiones
Se comprobó que el uso de los agentes reductores L-cisteína y ácido ascórbico, es efectivo para la propagación de L.casei, demostrándose que estos compuestos funcionan mejor si se usan en forma combinadaqueindividualmente.
Para trabajos posteriores se recomienda analizar el efecto de la disminución del potencial redox sobre el pH y la acidez de productos lácteos fermentados adicionados conprobióticos.
dressing fermented bybifidobacteria. Journalof DairyScience. 79:8-15
Brunner, J. C., Spillmanns, H. y Puhan, Z. 1993a. Metabolism and survival of Bifidobacterium in fermented milk during storage. MilchwirtschaftlicheForsehung. 22:19-25
Brunner, J. C., Spillmanns, H. y Puhan, Z. 1993b. Changes in pH, free sulphydryl groups, oxygen and redox potential during fermentation of milk with Bifidobacteriumlongum. MilchwirtschaftlicheForsehung. 22:26-31
Cerón, C. T. 2008. Evaluación de la viabilidad de Lactobacilluscasei encapsulado. Tesis de Maestría. Universidad de las Américas, Puebla.
Dave, R. I. y Shah, N. P. 1997a. Effect of cysteine on the viabilityof yogurth and probiotic bacteria in yogurths made with commercial starter cultures. InternationalDairyJournal. 7:537-545.
Dave, R. I. y Shah, N. P. 1997b. Effect of the level of starter culture on viabilityof yoghurth and probiotic bacteria in yogurths. FoodAustralia 49:164-168.
Dave, R. I. y Shah, N. P. 1997c. Effectiveness of ascorbic acid as an oxygen scavenger in improving viability of probiotic bacteria in yoghurts made with commercial starter cultures. Internacional DairyJournal. 7:435-443.
Díaz, P. I., Zilm, P. S. y Rogers, A. H. 2002. The response to oxidative stress of Fusobacterium nucleatum grown in continuos culture. FEMS MicrobiologyLetter. 187: 31-34.
European Food Information Council. 2005. The basics:FunctionalFoods. EUFIC.http://www.eufic.org/article/es/nutricion/fu ntionalfoods accesada 03/06/2008
Fuller, R. 1989. Probiotics in man and animals. JournalofAppliedBacteriology. 66:365-378
Institute of Food Technologists. 2005. Functional food:opportunitiesandchallenges. Expert Report. IFT.
http://www.ift.org/sp/nutrition/functional/index.cf m. accesada 8/12/06
Referencias
Blanchette, L., Roy, D., Be´langer, G. yGauthier, S. F. 1996. Production of cottage cheese using
Kim, E. R., Lee, K. W. yPark, Y. H. 2002. The study of lactic acid bacteria in yoghurt during delivery and storage. KoreanJournalofDairyScience 14:260-263
N. A. Santiestaban-López et al. / Temas Selectos de Ingeniería de Alimentos 2 – 2 (2008): 79 – 86
Naidu, A. S., Biblack, W. R. y Clemens, R. A. 1999. Probiotic spectra of Lactic Acid Bacteria (BAL). FoodScienceNutrition. 39:13-16
Ouwehand, A. C., Kirjavainen, P. V., Shontt, C. y Salminen, S. 1999. Probiotics mechanism and stablished effects. InternationalDairyJournal 9:43-52
Shah, N. P. 2000. Probiotic bacteria. JournalofDairy Science. 83: 899-907
Shishata, A. y Shah, N. P. 1999. Bacteriocin produced by S.thermophillus against Bifidobacterium species. InternationalDairyJournal. 5:515-521
Song, Y. H., Cho, Y. H. yPark, J. 2003. Microencapsulation of Lactobacilluscasei YIT9018 using a microporous glass membrana emulsification system. JournalofFoodScience. 68:195 – 200.

Temas Selectos de Ingeniería de Alimentos 2 – 2 (2008): 87 – 101
Temas Selectos de Ingeniería de Alimentos
Evaluación de mezclas binarias y ternarias de carvacrol, timol y eugenol para la inhibición de Listeria innocua
R. M. García – García*, E. Palou – García, A. López – Malo
DepartamentodeIngenieríaQuímicayAlimentos,UniversidaddelasAméricas–Puebla.
SanAndrésCholula,Pue.,México.
Resumen
La investigación de agentes antimicrobianos naturales como conservadores de alimentos cada día toma más auge. Por tal motivo, en este trabajo se evaluó el efecto antimicrobiano de carvacrol, timol y eugenol así como de sus mezclas binarias y ternarias sobre Listeria innocua en sistemas modelo líquidos. Para ello, se determinaron las concentraciones mínimas inhibitorias (CMI) de estos agentes en forma individual y después se evaluaron sus mezclas binarias y ternarias. Los sistemas fueron inoculados con L. innocua y se incubaron durante 72 horas a 35ºC. Se determinó el desarrollo microbiano a través de la turbidez de cada uno de ellos cada 24 horas. De los resultados obtenidos, se observó que el agente antimicrobiano más efectivo en forma individual es carvacrol, seguido de timol y finalmente eugenol en concentraciones de 150, 250 y 450 ppm respectivamente. Se observó que la mezcla binaria más efectiva es la que contiene 75 ppm de carvacrol y 62.5 ppm de timol. Así mismo, la mezcla ternaria conteniendo 75 ppm de carvacrol, 31.25 ppm de timol y 56.25 ppm de eugenol fue la más efectiva. Se concluye que las combinaciones de carvacrol, timol y eugenol funcionan adecuadamente para inhibir el crecimiento de L. innocua
Palabras clave: mezclas antimicrobianas, carvacrol, timol, eugenol, L. innocua.
Abstract
Nowadays the investigation of natural antimicrobial agents as food preservatives, takes an important role in food processing. By such reason in this work, the antimicrobial effect of three natural agents (carvacrol, thymol and eugenol) was evaluated as well as their binary and ternary mixtures on Listeria innocua inhibition in liquid model systems. Minimal inhibitory concentrations (MIC) of these agents were determined and binary and ternary mixtures were evaluated. The culture media were inoculated with L. innocua and were incubated for 72 hours at 35ºC. The turbidity of each system was determined every 24 hours. From the obtained results, it was observed that the most effective antimicrobial individual agent was carvacrol, followed by thymol and finally eugenol in concentrations of 150, 250 and 450 ppm, respectively. It was observed that the most effective binary mixture was 75 ppm of carvacrol and 62.5 ppm of thymol. Also, the ternary mixture carvacrol-thymol-eugenol in concentrations of 75, 31.25 and 56.25 ppm respectively, was the most effective for L. innocua inhibition. We conclude that the mixtures of these three natural antimicrobial agents work adequately to inhibit L. innocua growth
Key words: antimicrobial mixtures, carvacrol, thymol, eugenol, L. innocua
* Programa de Doctorado en Ciencia de Alimentos
Tel.: +52 222 229 2126, fax: +52 222 229 2727
Direccion electrónica: grebecag@yahoo.com.mx
R. M. García-García
etal. / Temas Selectos de Ingeniería de Alimentos 2 – 2 (2008): 87 – 101
Introducción
La presencia de microorganismos patógenos ydeteriorativos enlos alimentos,así comola exigencia de los consumidores por ingerir alimentos lo más naturales posibles, ha provocado que la investigación sobre el uso de agentes antimicrobianos naturales aumenteconsiderablemente.
Los agentes antimicrobianos son compuestos presentes o añadidos a los alimentos para causar la muerte de los microorganismos o retardar su crecimiento (López-Malo et al., 2000). El uso de agentes antimicrobianos es una de las técnicas más antiguas para conservar los alimentos (López-Malo et al., 2005).
Tradicionalmente, sólo un agente antimicrobiano era utilizado para conservar un alimento (Busta y Foegeding, 1983); sin embargo,recientemente el usodemezclas de agentesparalaconservacióndelosalimentos han sido utilizadas. Teóricamente, el uso de mezclas de agentes antimicrobianos provee un mayor espectro de actividad provocando un incremento en la acción antimicrobiana sobre microorganismos patógenos o deteriorativos. Se cree que la mezcla de agentes antimicrobianos puede actuar sobre diferentes especies de una mezcla de microorganismos, o actuar sobre diferentes puntosvitalesdentrodeespeciessimilares,lo cual resulta en un mejor control de los microorganismospresentesenelalimento,en comparación a que si se utilizara de manera individual un agente antimicrobiano (Santiesteban-López et al.,2006).
La evaluación de la combinación de agentes antimicrobianos es necesaria debido aqueunmicroorganismopuedeserresistente a la inhibición y/o eliminación por dosis convencionales de un solo agente antimicrobiano. Sin embargo,al ser expuesto a una combinación de agentes, el
microorganismo se vuelve menos resistente provocando su inhibición o muerte (León, 2002).
Los métodos para evaluar las mezclas de agentes antimicrobianos generalmente incluyen: difusiónenagar,diluciónenagaro caldo o curvas de muerte. Los métodos de dilución producen datos cuantitativos obtenidos frecuentemente de la combinación de diferentes concentraciones de dos agentes antimicrobianos siguiendo el diseño tipo tablero de ajedrez. Este diseño es la técnica utilizada con mayor frecuencia para evaluar las mezclas de agentes antimicrobianos in vitro,debidoaque(Eliopoulos yMoellering, 1991):
a) Es fácil de entender.
b) Los cálculos matemáticos necesarios para entender e interpretar los resultados son fáciles.
c) Se puede llevar a cabo en el laboratorio de manera sencilla utilizando sistemas de dilución.
d) Ha sido la técnica más utilizada en estudios que han investigado interacciones sinérgicas de antibióticos en tratamientos clínicos.
Los estudios de las mezclas de agentes antimicrobianos también tienen como propósito determinar el tipo específico de interacción que ocurre entre los agentes combinados. Tradicionalmente, los términos aditivo, antagónico y sinérgico son usados para describir la posible interacción de dichos agentes. Para interpretar el tipo de interacción generalmente se utiliza la concentración fraccional inhibitoria (CFI), la cuál se define como la concentración que se requiere de un agente antimicrobiano para inhibir el crecimiento de un microorganismo cuando está combinado con una concentración conocida de otros agentes (López-Malo et al., 2005). Para obtener los valores de CFI se utilizan las fórmulas reportadasporDavidsonyParish(1989).
R. M. García-García
etal. / Temas Selectos de Ingeniería de Alimentos 2 – 2 (2008): 87 – 101
( ) ( )mente individual A de CMI C y B de presencia en A de CMI A CFI =
( ) ( ) mente individual B de CMI C y A de presencia en B de CMI B CFI =
( ) ( )mente individual C de CMI B y A de presencia en C de CMI C CFI = C CFI B CFI A CFI CFI Índice + + =
Una vez obtenidos los valores de CFI, se determinaelíndiceCFImediantelaecuación 4.
Teóricamente, un índice CFI igual o próximo a uno indica un efecto aditivo, < 1 indica un efecto sinérgico y >1 indica un efectoantagónico(DavidsonyParish,1989).
Los mecanismos aceptados sobre el sinergismo que produce la interacción de agentes antimicrobianos son mencionados por Eliopoulos y Moellering (1991). Entre estosmecanismosseencuentran:
1. La inhibición secuencial de una ruta bioquímica.
2. La inhibición de enzimas protectoras.
3. La combinación de agentes activos de paredes celulares para incrementar el daño de la misma.
Existen algunos trabajos realizados como los de Santiesteban-López et al. (2006) y García (2005) en dónde se evalúan los efectos de mezclas de agentes antimicrobianos naturales (carvacrol, timol y eugenol) y sintéticos (sorbato de potasio) sobre diferentes bacterias de interés en alimentos como: Staphylococcus aureus, Salmonella typhimurium, L. innocua y Escherichia coli. Sin embargo, debido a que
no es fácil anticipar los efectos o la interacción de mezclas de agentes antimicrobianos sobre los microorganismos, surgeel interés deestetrabajo,cuyo objetivo primordial fue evaluar mezclas binarias y
(Ec.1)
(Ec.2)
(Ec.3)
(Ec.4)
ternarias de agentes antimicrobianos naturales tales como carvacrol, timol y eugenol en sistemas modelo líquidos para inhibirelcrecimientode Listeriainnocua.
Materialesymétodos
Microorganismos
Se utilizó la cepa de Listeria innocua ATCC 51742 obtenida del laboratorio de Microbiología de Alimentos de la UniversidadAutónomadeSanLuísPotosí,la cuál se hizo crecer en cuñas de agar soya tripticaseína (CASOY) (Merck, México) a 35ºC por 48 horas para después mantenerlas en refrigeración a 4ºC; dicha cepa se resembró continuamente (López-Malo, 1995).
Preparacióndel inóculo
Para la preparación del inóculo se tomó una asada de la cepa mantenida en cuña de agar CASOY y se hizo crecer en caldo soya tripticaseína (CASOY) (Merck, México) a las condiciones óptimas de temperatura (35ºC). Los inóculos se resembraron cada 24 horas para mantener la fase exponencial de crecimiento.
Preparacióndelos sistemasmodelo
Se prepararon sistemas modelo líquidos en tubos de vidrio con una capacidad de 10
R.
M. García-García
etal. / Temas Selectos de Ingeniería de Alimentos 2 – 2 (2008): 87 – 101
TablaI.Concentracionesevaluadasdelosagentes antimicrobianosparadeterminarlaconcentración mínima inhibitoria (CMI)
CarvacrolTimolEugenol (ppm)(ppm)(ppm)
100150250 150200350 250450
ml utilizando como base caldo soya tripticaseína (CASOY), estos sistemas se esterilizarona121ºCpor15minutos.
Para la adición de los diferentes antimicrobianos, se prepararon soluciones alcohólicas al 0.5% p/v de carvacrol, timol y eugenol.Estas soluciones seesterilizaron por filtración en membrana de celulosa con tamaño de poro de 0.45 micras (Micro Filtration Systems, Dublín, CA); se almacenaron en refrigeración (4ºC) en frascos forrados con papel estaño. Los agentes antimicrobianos se añadieron a los sistemas modelo líquidos en las concentracionescorrespondientes.
Determinación de la concentración mínima inhibitoria (CMI) de los agentes antimicrobianosindividuales.
La determinación de la CMI de los agentes antimicrobianos timol, carvacrol y eugenol de manera individual, se realizó medianteunacinéticademuerte.Paralocuál se tomó una asada del microorganismo y se hizocrecera35ºC por24horasen100ml de caldo soya tripticaseína (CASOY). Una vez obtenida la fase exponencial, se adicionó el agenteantimicrobiano al medio de cultivo en las concentraciones señaladas (Tabla I). De este medio, se tomó una muestra cada hora durantelasprimeras6horas,despuésalas24 y 48 horas. La muestra tomada se sembró en cajas Petri de 100 ml por la técnica de vertido en placa utilizando como base agar soya tripticaseína (Merck, México). Estas
cajas se incubaron por 48 horas a 35ºC y se realizóelrecuento.
Evaluación de mezclas binarias y ternarias de los agentes antimicrobianos carvacrol, timoly eugenol
Una vez determinada la CMI de los agentes antimicrobianos de manera individual, se evaluó el efecto de las mezclas binarias carvacrol-timol, timol-eugenol y carvacrol-eugenol; así mismo se evaluó el efecto de la mezcla ternaria carvacrol-timoleugenol a diferentes concentraciones de cada uno de los agentes siguiendo un diseño tipo tablerodeajedrez(Davidson yParish,1989). Las combinaciones delas concentraciones de los agentes antimicrobianos para las mezclas binarias se muestran en la tabla II y para las mezclas ternarias en la tabla III. En estas tablas, el valor de CMI es el obtenido previamente.
Inoculación del sistema modelo para la evaluación de las mezclas binarias y ternarias
Los sistemas modelo líquidos con 9 ml de caldo CASOY y con la cantidad de antimicrobianos correspondientes, se inocularon por triplicado con una población de 109 UFC/ml de L. innocua. Los sistemas seincubaron72horasa35ºCycada24horas se determinó turbidez a cada uno de ellos mediante comparación con un control para identificar crecimiento (G) o no crecimiento (NG) del microorganismo. Los sistemas modelo que presentaron turbidez se consideraron con crecimiento microbiano. A ellos se les determinó la carga microbiana, tomando una muestra de un mililitro y sembrándola en cajas Petri por la técnica de vertido en placa utilizando como base agar soya tripticaseína. Las cajas se incubaron a 35ºCpor24horas.
R.
M. García-García
etal. / Temas
de
de Alimentos 2 – 2 (2008): 87 – 101
Tabla II. Combinaciones de los agentes antimicrobianos utilizados para evaluar la capacidad antibacteriana de las mezclas binarias. CMI 1/2 CMI 1/4 CMI 1/8 CMI 0 AGENTE CMI CMI / CMI CMI / 1/2CMI CMI / 1/4CMI CMI / 1/8CMI CMI / 0 ANTIMICROBIANO 2 1/2 CMI 1/2CMI / CMI 1/2CMI / 1/2CMI 1/2CMI / 1/4CMI 1/2CMI / 1/8CMI CMI / 0 1/4 CMI 1/4CMI / CMI 1/4CMI / 1/2CMI 1/4CMI / 1/4CMI 1/4CMI / 1/8CMI CMI / 0 1/8 CMI 1/8CMI / CMI 1/8CMI / 1/2CMI 1/8CMI / 1/4CMI 1/8CMI / 1/8CMI CMI / 0 0 0 / CMI 0 / 1/2CMI 0 / 1/4CMI 0 / 1/8CMI CMI / 0
AGENTE ANTIMICROBIANO 1
Tabla III. Combinaciones de los agentes antimicrobianos utilizados para evaluar la capacidad antibacteriana de las mezclas ternarias.
AGENTE ANTIMICROBIANO 1 (CMI, 1/2CMI, 1/4CMI, 1/8CMI, 0)
AGENTE ANTIMICROBIANO 2
Determinación del efecto bactericida o bacteriostático
De los sistemas modelo líquido que no presentaron turbidez se tomó una muestra y se hicieron diluciones 10-1, 10-2 y 10-3. De cada dilución se tomó una muestra de un mililitro y se sembró en cajas Petri por la técnica de vertido en placa utilizando como base agar soya tripticaseína (Merck, México); la determinación se hizo por duplicado a las 24, 48 y 72 horas después de haber inoculado los sistemas modelo líquidos. Las cajas se incubaron por 48 horas a35ºCyserealizóelrecuento.
Determinación de las concentraciones mínimasinhibitorias(CMI)
Se determinaron las concentraciones mínimas inhibitorias (CMI) en aquellos sistemas líquidos en donde no se detectó crecimiento al final de las 72 horas. Esto se llevó a cabo mediante el cálculo de los valores de CFI utilizando las ecuaciones 1, 2 y 3. Así mismo, se determinó el índice CFI
mediante la ecuación 4 para observar efectos aditivos,sinérgicosoantagónicos.
Resultadosydiscusión
Determinación de las CMI individuales de carvacrol, timol yeugenol sobreL.innocua
LaCMIesdefinidacomoelnivel mínimode las concentraciones evaluadas del agente antimicrobiano que produce la inhibición del crecimiento microbiano (Skandamis y Nychas,2001).
Carvacrol
En el caso de carvacrol se estudiaron dos concentraciones: 100 y 150 ppm, determinando que a 100 ppm no se inhibe el crecimiento de L. innocua después de 48 horas a 35ºC, en cambio, a 150 ppm (Figura 1) después de 4 horas ya no se observa crecimiento manteniéndose en estas condiciones a las 24 y 48 horas respectivamente.
M. García-García
Estudios realizados por SantiestebanLópez et al. (2006) señalaron que la CMI de carvacrol para L. innocua a pH de 4.5 y una actividaddeagua(aw)de0.97esde100ppm en medios de cultivo sólidos. De la misma manera García (2005) señaló en estudios realizados en medios de cultivo líquidos que la CMI para L. innocua era de 150 ppm. Es importanteseñalarqueenmedioslíquidoslas bacterias tienen la capacidad de movilizarse y estar en contacto directo con los agentes antimicrobianos(Pelczar etal., 1995).
De acuerdo con Quinn (1986) y Suutari y Laakso (1994), en general se pueden distinguir 3 fases físicas de las membranas celulares: una bicapa en fase gel (cadena de lípidosordenada),unabicapaenfaselíquidacristalina (cadena de lípidos desordenada) y una estructura hexagonal. Para una funcionalidadbiológicaóptima,lamembrana debe estar mantenida en el estado fluido líquido cristalino (Ingram, 1976), y la temperatura de transición (Tm) de la fase gel a la líquida-cristalina constituye la principal influencia sobre la flexibilidad y estabilidad de la membrana (Suutari yLaakso, 1994). El carácter hidrofóbico de carvacrol interactúa
de
2 – 2 (2008): 87 – 101
con la membrana celular del microorganismo, permitiendo la salida de lipopolisacáridos e incrementando la permeabilidad de la membrana citoplasmática.
A concentraciones menores de carvacrol (100 ppm en este estudio), los microorganismos poseen algunos mecanismos de adaptación contra los efectos dañinos de los componentes citotóxicos, (Bygraves y Russell, 1988; Russell y Fukunaga, 1990; Weber y De Bont, 1996), talescomo(Bolhius et al., 1994):
a) Mantener una adecuada proporción de los lípidos de la fase líquida-cristalina en la membrana (restauración de la fluidez de la membrana).
b) Mantener un balance apropiado entre la bicapa y la no bicapa de fosfolípidos (manteniendo la integridad de la membrana).
c) Expulsión por los sistemas de materia extraña.
Es importante mencionar, que cuando la concentración de carvacrol aumenta, mayor cantidad de este componente es acumulado
R. M. García-García
tiempo (horas)
Fig. 2. Cinética de muerte de Liseria innocua en presencia de 250 ppm de timol en el caldo CASOY a 35ºC.
en la membrana y por consiguiente el daño enlamismaesmayor(Ultee etal., 2002).
Timol
Enloquerespectaatimol,seestudiaron3 concentraciones: 150, 200 y 250 ppm. Estableciendoquea150y200ppmdetimol, no se logra inhibir a L. innocua ya que después de las primeras seis horas, el microorganismo se recupera presentando crecimiento microbiano a las 24 y 48 horas posteriores (Figuras no mostradas). Sin embargo a 250 ppm L. innocua se ve inhibida evitando el crecimiento microbiano (Figura 2). Por lo tanto, en este estudio, el valor de CMI de timol para dicho microorganismo es 250 ppm. Es importante señalar que la acción antimicrobiana y la sensibilidad al timol (al igual que cualquier agente antimicrobiano) es dependiente de ciertos factores como el tipo de microorganismo, el pH del medio y la temperatura de incubación (Falcone et al., 2005). Es por ello que se pueden encontrar
estudioscomoelrealizadoporGarcía(2005), endóndeelvalordelCMIpara L. innocua en medios de cultivo líquido es 162.5 ppm, siendo menor al obtenido en este trabajo. Esta diferencia en el valor del CMI también sepuededeberalpHdel medio yaquesegún loreportadoporJuven et al. (1994),elefecto inhibitorio de timol es mayor a un pH de 5.5 que a 6.5, ya que a bajos valores de pH la molécula del agente antimicrobiano está no disociada, logrando unir mejor las partes hidrofóbicas de las proteínas y por lo tanto, facilitandoladisolucióndelafaselipídicade la membrana. En este estudio el pH de los mediosdecultivofuede7.
El mecanismo de acción del timol es semejante al de carvacrol, ya que su estructura química es similar, cambiando únicamente la posición del grupo hidroxilo dentrodelanillo,porloqueambassustancias hacen permeable la membrana celular (Lambert et al., 2001).Helander et al.(1998) señalaron que timol libera lipopolisacáridos (LPS) incrementando la permeabilidad de la
M. García-García
2 – 2 (2008): 87 – 101
tiempo (horas)
Fig. 3. Cinética de muerte de Liseria innocua en presencia de 450 ppm de eugenol en caldo CASOY a 35º
membrana. Juven et al. (1994) estudiaron el efecto del timol contra S. typhimurium y S. aureus concluyendo que este agente antimicrobiano une, mediante puentes de hidrógeno, las proteínas hidrofóbicas de la membrana cambiando las características de permeabilidad de la misma. Helander et al (1998), al probar el efecto del carvacrol y el timol sobre E. coli O157:H7 y S. typhimurium, notaron que la manera de actuar de estos agentes antimicrobianos era disminuyendo el contenido de ATP intracelular de los microorganismos al mismo tiempo que incrementaba el ATP extracelular, lo que provocaba el rompimientodelamembranaplasmática.
Eugenol
En lo que respecta a eugenol, se estudiaron3concentraciones: 250,350 y450 ppm; estableciendo que a concentraciones de 250 y 350 ppm L. innocua no se ve inhibida por el agente antimicrobiano eugenol; sin embargo a 450 ppm de este agente (Figura
3), dicho microorganismo se ve inhibido desde las primeras horas. Este resultado nos indica que, en este estudio, 450 ppm de eugenol fue la CMI para L. innocua en el sistemamodeloevaluado.
Existen pocos estudios sobre el mecanismo de acción de eugenol, sin embargo se sabe que actúa inhibiendo la produccióndeciertasenzimascomoamilasas y proteasas (Farag et al., 1989). En algunos estudios sobre Enterobacter aerogenes se ha observado que el grupo hidroxilo de la molécula de eugenol se une a las proteínas para prevenir la acción de las enzimas (Wendakoon y Sakaguchi, 1995). De la misma manera, Gill y Holley (2004) señalaron que el agente antimicrobiano eugenol tiene efecto bactericida sobre Listeria monocytogenes, observando queeste agente actúa como transportador de iones, impidiendoelaumentodelosnivelesdeATP celular. Walsh et al. (2003) reportaron que células de E. coli yde S. aureus tratadas con eugenol presentaron cambios en la
M. García-García
– 101
Tabla IV. Respuesta de crecimiento (G) o no crecimiento (NG) de L. innocua en caldo CASOY con diversas concentraciones de la mezcla binaria carvacrol-timol
TIMOL (ppm)
250 125 62.5 31.25 0
CARVACROL 150 NG a NG a NG a NG a NG a (ppm)
NG a NG a NG a NGNG 37.5 NG a NG a NGGG 18.75 NG a NGNGGG 0 NG a NGNGGG
NG a Mezclas binarias con actividad bactericida
permeabilidad de la membrana debido a la salida de iones potasio. Wendakoon y Sakaguchi(1995),encontraronqueeugenol a concentraciones mayores a 6 mM inhibe la enzima histidina decarboxilasa de E. aerogenes; porloqueseñalanqueel eugenol inhibe la síntesis de enzimas teniendo efecto directosobrelaenergíametabólica.
De acuerdo con los resultados obtenidos, seconcluyequelas concentraciones mínimas inhibitorias en este estudio para inhibir a L. innocua en medios de cultivo líquidos son: 150 ppm para carvacrol, 250 ppm para timol y450ppmparaeugenol.Estosresultadosson similares a los mostrados por SantiestebanLópez et al. (2006) en estudios sobre S. aureus, L. innocua, E. coli y S. typhimurium, en dónde señalan que carvacrol es el agente antimicrobiano más efectivo para inhibir el crecimiento de dichas bacterias seguido de timolyeugenol.
Efecto de las mezclas binarias y ternarias de los agentes antimicrobianos sobre L. innocua.
El efecto bactericidaserefierealamuerte de bacterias, mientras que el efecto bacteriostático se refiere a la supresión del desarrollo de las mismas (Pelczar et al., 1995). Esto indica que si el efecto fue bactericida no hubo crecimiento microbiano en la caja Petri, mientras que si el efecto fue
bacteriostático, el tubo no presentó turbidez pero en el momento de sembrarlo en caja Petri hubo crecimiento de L. innocua, ya que el agente antimicrobiano únicamente evitó el crecimiento del microorganismo pero no provocólamuertecelular.
La respuesta crecimiento (G) o no crecimiento (NG) de L. innocua en la combinación de la mezcla binaria carvacroltimolseobservaenlaTablaIV.Endóndede 25 combinaciones evaluadas, 19 (el 76%) no presentaron crecimiento microbiano en medio líquido. De estas 19 combinaciones, 12 presentaron efecto bactericida mientras que solamente 7 presentaron efecto bacteriostático.
De la misma manera, los resultados obtenidos para la mezcla binaria carvacroleugenol son presentados en la Tabla V. Observándose que de 25 combinaciones evaluadas, únicamente 13 (el 52%) fueron efectivas para inhibir a L. innocua y de estas 13, únicamente 9 presentaron efecto bactericida.
Los resultados de la evaluación de la mezcla binaria timol-eugenol se observan en la Tabla VI, en dónde de 25 combinaciones evaluadas, 16 (el 64%) fueron efectivas para inhibir a L. innocua, de las cuales 12 presentaronefectobactericida.
R.
M. García-García
etal. / Temas Selectos de Ingeniería de Alimentos 2 – 2 (2008): 87 – 101
Analizando las 3 mezclas binarias evaluadas, con base en los resultados del efecto bactericida, se puede concluir que la mezcla más efectiva para inhibir el crecimiento de L. innocua en sistemas modelo líquidos, es aquella que contiene 75 ppm de carvacrol y 62.5 ppm de timol, seguida de la mezcla binaria timol-eugenol en una concentración de 125 ppm de timol y 56.25 ppm de eugenol. La mezcla menos efectivafuecarvacrol-eugenol.
Los resultados obtenidos para las mezclas ternarias, se observan en la Tabla VII; en dóndesepuedeverquede36combinaciones probadas, 31 (el 86.11%) son efectivas para inhibir el crecimiento de L. innocua en medios de cultivo líquidos. Sin embargo de estas 31 combinaciones, únicamente 14 presentan efecto bactericida. La CMI de la mezcla ternaria establecida para L. innocua en este estudio es: 75 ppm de carvacrol -
31.25ppmdetimol–56.25ppmdeeugenol.
García (2005) señala que de 125 combinaciones evaluadas entre mezclas binarias y ternarias de carvacrol, timol y sorbato de potasio, únicamente 40 fueron efectivasparainhibira L. innocua,ydeéstas, 29 presentaron efecto bactericida y 11 efecto bacteriostático. Estos resultados corroboran los obtenidos en este trabajo, en dónde existen mezclas binarias y ternarias de agentes antimicrobianos naturales efectivas para inhibir a dicho microorganismo. De la misma manera Santiesteban-López et al (2006) señalaron, en estudios realizados con L. innocua, S. typhimurium y E. coli, que existen combinaciones binarias yternarias de carvacrol, timol, eugenol y sorbato de potasio, efectivas para inhibir a dichos microorganismos. Así mismo, señalaron de manera general, que los antimicrobianos naturales (carvacrol, timol y eugenol) son
Tabla V. Respuesta de crecimiento (G) o no crecimiento (NG) de L. innocua en caldo CASOY con diversas concentraciones de la mezcla binaria carvacrol-eugenol. 450 225 112.5 56.25 0
EUGENOL (ppm)
NG a Mezclas binarias con actividad bactericida
Tabla VI. Respuesta de crecimiento (G) o no crecimiento (NG) de L. innocua en caldo CASOY con diversas concentraciones de la mezcla binaria timol-eugenol. 450 225 112.5 56.25 0 TIMOL 250 NG a NG a NG a NG a NG a (ppm) 125 NG a NG a NG a NG a NG 62.5 NG a NGNGNGG 31.25 NG a GGGG
EUGENOL (ppm)
NG a GGGG
NG a Mezclas binarias con actividad bactericida
R. M. García-García etal. / Temas Selectos de Ingeniería de Alimentos 2 – 2 (2008): 87 – 101
Tabla VII. Respuesta de crecimiento (G) o no crecimiento (NG) de L. innocua en caldo CASOY con diversas concentraciones de la mezcla ternaria carvacrol-timol-eugenol
Eugenol 225 (ppm)
Timol (ppm)
Carvacrol (ppm)
62.5 31.25 75 NG a NG a NG a 37.5 NG a NG a NG 18.75 NG a NGNG
Eugenol 112.5 (ppm)
Timol (ppm)
Carvacrol (ppm) 125 62.5 31.25
75 NG a NG a NG a
37.5 NG a NGNG 18.75 NG a NGNG
Eugenol 56.25 (ppm)
Timol (ppm)
Carvacrol (ppm) 125 62.5 31.25 75 NG a NG a NG a 37.5 NG NG G
NG NG G
Eugenol 28.125 (ppm)
Timol (ppm)
Carvacrol (ppm)
NG G G
NG a Combinaciones con efecto bactericida
más efectivos que el sorbato de potasio a las condiciones de pH y aw estudiadas, de tal manera que estos agentes antimicrobianos son menos dependientes de los factores mencionados.
De todas las combinaciones binarias y ternarias efectivas para inhibir el crecimiento del microorganismo en estudio, se determinaron las concentraciones fraccionales inhibitorias (CFI) y el índice de las concentraciones fraccionales inhibitorias (índice CFI ). Si el efecto es aditivo indica que la actividad antimicrobiana de un
compuesto no aumenta ni disminuye con la presenciadeotroagenteantimicrobiano;siel efecto es antagónico, indica que la actividad antimicrobiana de un compuesto es reducida con la presencia de los otros agentes antimicrobianos y si el efecto es sinérgico indica que la actividad antimicrobiana de un compuesto se ve incrementada con la presencia de otro agente antimicrobiano (Barry,1976).
En laTabla VIIIse muestran los CFI, los índices CFI yel tipo de efecto que generaron las diferentes combinaciones binarias
R.
M. García-García
etal. / Temas Selectos de Ingeniería de Alimentos 2 – 2 (2008): 87 – 101
Tabla VIII. Concentraciones fraccionales inhibitorias (CFI) de las combinaciones binarias efectivas de carvacrol, timol y eugenol para inhibir el crecimiento de L. innocua. CARVACROL
efectivas para inhibir a L. innocua. Se observaqueconbaseenelefectobactericida, la combinación carvacrol-timol es la que presenta mayor número de combinaciones sinérgicas (dos de tres efectivas), mientras que la combinación de carvacrol-eugenol generaunefectoantagónico.
De las combinaciones que presentaron efecto bacteriostático, se observa que todas las mezclas presentan efecto sinérgico, no importando el agente antimicrobiano del que setrate.
Con lo que respecta a las combinaciones ternarias, en la Tabla IX se observan los
resultados obtenidos. De tres mezclas bactericidas efectivas, dos presentan efecto sinérgico y únicamente una presenta efecto aditivo, mientras que de las combinaciones con actividad bacteriostática todas presentan efectosinérgico.
García (2005), señaló que de 12 combinaciones ternarias efectivas para inhibir a L. innocua 10 son sinérgicas mientras que dos son aditivas. Los estudios realizados por Santiesteban-López et al. (2006) señalan que existen mezclas sinérgicas de carvacrol, timol y sorbato de potasio efectivas para inhibir el crecimiento de L. innocua y que en la mayoría de los
R. M. García-García
Tabla IX. Concentraciones fraccionales inhibitorias (CFI) de las combinaciones ternarias efectivas de carvacrol, timol y eugenol para inhibir el crecimiento de L. innocua.
EFECTOBACTERICIDA
EFECTOBACTERIOSTATICO
casos, las combinaciones binarias sinérgicas favorecen que las mezclas ternarias con los mismos agentes antimicrobianos sean tambiénsinérgicas.
Santiesteban-López et al. (2006) señalaron que en una mezcla las concentraciones inhibitorias de los agentes antimicrobianos dependen de la aw, del pH y del tipo debacteriaquesequiereinhibir. Así mismo mencionaron que los agentes antimicrobianos tienen mayor potencial para eliminar una gran diversidad de bacterias cuando se combinan que cuando actúan de maneraindividual.
Es importante señalar que los estudios previos sobre las actividades antimicrobianas de los compuestos fenólicos, se han dirigido más hacia el potencial inhibidor de los compuestos individuales que de las mezclas. Sin embargo, en todos ellos se señala que la concentración requerida para inhibir a los microorganismos, es menor cuando se combinan que cuando se utilizan de manera individual(Santiesteban-López et al., 2006).
Conclusiones
A pesar del escaso conocimiento científico sobre los mecanismos de interacción de los agentes antimicrobianos, muchas de sus combinaciones sinérgicas pueden ser útiles para inhibir microorganismos patógenos y deteriorativos de interés en alimentos. Así mismo, el interés por encontrar mezclas sinérgicas efectivas debe ir en aumento, ya que el uso de la mayoría de los aceites esenciales con actividad antimicrobiana, se ve limitado debido a que tienen afectación directa en el sabor de los alimentos. Las concentraciones efectivas para inhibir a los microorganismos exceden los niveles sensoriales aceptables. Es por ello, que es importante continuar con las investigaciones para determinar las CMI de los agentes antimicrobianos en mezclas sinérgicas, para establecer un balance entre la eficacia antimicrobial y la aceptación sensorial. En esteestudiosedeterminaronmezclasbinarias y ternarias sinérgicamente efectivas para la inhibición de L. innocua en sistemas modelo líquidos, sin embargo, es importante que éstas combinaciones antimicrobianas se evalúen a diferentes valores de pH y aw así como directamente en alimentos y con cada tipo de microorganismo, ya que en ocasiones la efectividad de los agentes antimicrobianos
R. M. García-García etal. / Temas Selectos de Ingeniería de Alimentos 2 – 2 (2008): 87 – 101
puedeverseafectadapor los componentes de los alimentos así como la resistencia que presentan algunos microorganismos a determinadosagentesantimicrobianos.
Agradecimientos
Los autores de este trabajo agradecen el apoyo y financiamiento recibido por el CONACyT yalaUDLAPparalarealización delmismo.
Farag, R. S., Daw, Z. Y., Hewedi, F. M. y El-Baroty, G. S. A., 1989. Antimicrobial activity of some Egyptian spice essential oils. Journal of Food Protection 52(9):665-667.
García, R. M. 2005. Agentes bactericidas/bacteriostáticos a partir de sorbato de potasio, carvacrol y timol. Tesis de Maestría. Universidad de las Américas Puebla. México.
Gill, A. y Holley R. 2004. Mechanisms of bactericidal action of cinnamaldehyde against Listeria monocytogenes and eugenol against L. monocytogenes and Lactobacillus sakei. Applied and Environmental Microbiology. 70(10):57505755.
Referencias
Barry, A. L. 1976. The Antimicrobial Susceptibility Test: Principles and Practices. Lea & Febiger. Filadelfia. 335 p.
Bolhuis, H., Molenaar, D., Poelarends, G., Van Veen, H. W., Poolman, B., Driessen, A. J., Konings, W N. 1994. Proton motive force-driven and ATPdependent drug extrusion systems in multidrugresistant Lactococcus lactis. Journal of Bacteriology 176:6957-6964.
Busta, F. F. y Foegeding, P. M. 1983. Chemical food preservatives. En: S. S. Block (Ed). Disinfection, Sterilization and Preservation. Tercera Edición. Lea & Febiger. Filadelfia. pp. 656-675.
Bygraves, J. A. y Russell, N. J. 1988. Solute tolerance and membrane lipid composition in some halotolerant food-spoilage bacteria. Food Microbiology. 5:109-116.
Davidson, P.M. y Parish, M.E. 1989. Methods for testing the efficacy of food antimicrobials. Food Technology. 43(1):148-155.
Eliopoulos, G. M. y Moellering, R. C. 1991. Antimicrobial combinations. En: V. Lorian (Ed). Antibiotics in Laboratory Medicine. Tercera Edición. Williams & Wilkins. Baltimore. pp. 406432.
Falcone, P., Speranza B., Del Nobile, M. A., Corbo, M. R. y Sinigaglia M. 2005. A study on the antimicrobial activity of thymol intended as a natural preservative. Journal of Food Protection. 68(8):1664-1670.
100
Helander, I. M., Alakomi, H-L., Latva-Kala, K., Mattila-Sandholm, T., Pol, I. Smid, E. J., Gorris, L. G. M. y Wright, A. V. 1998. Characterization of the action of selected essential oil components on Gram-negative bacteria. Journal of Agricultural andFoodChemistry. 46:3590-3595.
Ingram, L. O. 1976. Adaptation of membrane lipids to alcohol. Journalof Bacteriology. 125:670-678.
Juven, B. J., Kanner, J., Schved, F. y Weissolowics, H. 1994. Factors that interact with the antibacterial action of thyme essential oils and its active constituents. Journal of Applied Bacteriology. 76:626-631.
Lambert, R. J. W., Skandamis, P. N., Coote, P. J. y Nychas, G. J. E. 2001. A study of the minimum inhibitory concentration and mode of action of oregano essential oil, thymol and carvacrol. JournalofAppliedMicrobiology. 91:453-462.
León, R., 2002. Espectro de acción de mezclas ternarias de agentes antimicrobianos. Tesis de Maestría. Universidad de las Américas, Puebla. México.
López-Malo, A. 1995. Efecto de diversos factores sobre la capacidad antimicótica de vainillina. Tesis de Maestría. Universidad de las Américas, Puebla. México.
López-Malo, A., Alzamora, S. M. yGuerrero, S. 2000 Natural antimicrobials from plants. En: S. M. Alzamora, M. S. Tapia, y A. López-Malo (Eds). Minimally Processed Fruits and Vegetables. Fundamental Aspects and Applications. Aspen Publishers, Inc. Nueva York. pp. 237-264.
López-Malo, A., Alzamora, S. M. y Palou, E. 2005. Naturally occurring compounds-plant sources. En: P. M. Davidson, J. N. Sofos, y A. L. Branen (Eds).
R. M. García-García etal. / Temas Selectos de Ingeniería de Alimentos 2 – 2 (2008): 87 – 101
Antimicrobials in Food. Tercera Edición. CRC Press. Nueva York. pp. 429-451.
Pelczar, M., Reid, R. y Chan, E. C. S. 1995. Microbiología. Cuarta Edición. Mc. Graw-Hill. E.U.A. 364 p.
Quinn P. J. 1986. Models of haloadaptation in bacterial membranes. FEMS Microbiology Letters. 39:87-94.
Russell, N. J. y Fukunaga, N. 1990. A comparison of thermal adaptation of membrane lipids in psychrophilic and thermophilic bacteria. FEMS MicrobiologyLetters. 75:171-182.
Santiesteban-López, A., Palou, E. y López-Malo, A. 2006. Susceptibility of food borne bacteria to binary combinations of antimicrobials at selected aw and pH. Journal of Applied Microbiology 102(2): 486-497.
Skandamis, P. N. y Nychas, G. J-E. 2001. Effect of oregano essential oil on microbiological and physico-chemical attributes of minced meat stored in air and modified atmospheres. Journal of AppliedMicrobiology. 91:1011-1022.
Suutari M y Laakso S. 1994. Microbial fatty acids and thermal adaptation. Critical Reviews in Microbiology 20:285-328.
Ultee, A., Bennink, M. H. J. y Moezelaar, R. 2002. The phenolic hydroxyl group of carvacrol is essential for action against the food-borne pathogen Bacillus cereus Applied and EnvironmentalMicrobiology. 68(4):1561-1568.
Walsh, S. E., Maillard, J. Y., Russell, A. D., Catrenich, C. E., Charbonneaus, D. L. y Bartolo R. G. 2003. Activity and mechanisms of action of selected biocidal agents on Gram positive and negative bacteria. Journal of Applied Microbiology. 94:240-247.
Weber, F. J. y De Bont, J. A. M., 1996. Adaptation mechanisms of microorganisms to the toxic effects of organic solvents of membranes. Biochimica et BiophysicaActa 1286:225-245.
Wendakoon, C. N. y Sakaguchi, M. 1995. Inhibition of amino acid decarboxylase activity of Enterobacter aerogenes by active components in spices. JournalofFoodProtection. 58:280-283

Temas Selectos de Ingeniería de Alimentos 2 – 2 (2008): 102 – 111
Temas Selectos de Ingeniería de Alimentos
Modelación de la inactivación termoultrasónica de Staphyloccocus aureus, un enfoque multifactorial
R. Avila
–
Sosa *, G. G. Gastélum, A. López – Malo
DepartamentodeIngenieríaQuímicayAlimentos,UniversidaddelasAméricas–Puebla.
SanAndrésCholula,Pue.,México.
Resumen
En la actualidad se buscan procesos de conservación en alimentos que logren un menor daño a su calidad total. Por lo que el uso de ultrasonido puede ayudar a reducir la intensidad de los procesos tradicionales, particularmente cuando se combina con otros factores de conservación. Generalmente este tipo de combinaciones multifactoriales se denomina tecnología de obstáculos. Para evaluar la acción multifactorial, se recurrió al uso de modelos matemáticos que describen la inactivación microbiana. Se modeló la inactivación termoultrasónica de Staphyloccocus aureus, aplicando simultáneamente temperatura (40, 50 y 60°C), bajas frecuencias de ultrasonido (20KHz) con diferentes amplitudes de onda (60, 75 y 90µm), y diferentes concentraciones de vainillina (200, 350 y 500ppm) como antimicrobiano, en medios de cultivo con aw 0.96 y pH 3.5. Se generaron curvas de muerte que se ajustaron al modelo de Fermi, obteniendo los parámetros a (pendiente de la curva) y tc (tiempo en que se disminuye el 50% de la población). Se encontró un efecto sinérgico de los factores probados, a valores de temperatura cercanos a 40°C con diferentes amplitudes de ondas ultrasónicas y diferentes concentraciones de vainillina. Los resultados obtenidos al usar estos factores de manera conjunta, demuestran la utilidad que estas combinaciones podrían tener en la industria de alimentos.
Palabras clave: Termoultrasonicación, factores combinados, vainillina
Abstract
In recent years different emerging technologies have been evaluated such as ultrasound, which is usually combined with other factors in order to increase the microorganism inactivation. The modeling of thermosonication inactivation of Staphyloccocus aureus was evaluated by simultaneous application of heat treatment (40, 50 and 60°C) and low frequency ultrasound (20KHz) at different wave amplitudes (60, 75 and 90µm). The experiment was carried out in culture broth with aw 0.96, pH 3.5 and different concentrations of vanillin (200, 350 and 500ppm). Death curves were generated and fitted to the Fermi equation. A synergistic effect when temperature is close to 40°C at different ultrasonic amplitude waves, and vanillin concentrations was found. This experiment showed that the simultaneous application of ultrasound, temperature and vanillin concentration had a sinergystic inhibitory effect on Staphylococcus aureus and this process could be applied to the food industry.
Key words: Thermoultasonication, combined factors, vanillin.
* Programa de Doctorado en Ciencia de Alimentos
Tel.: +52 222 229 2126, fax: +52 222 229 2727
Direccion electrónica: raulavilasosa@hotmail.com
R.
Avila-Sosa
etal. / Temas Selectos de Ingeniería de Alimentos 2 – 2 (2008): 102 – 111
Introducción
En los últimos años se han evaluado diferentes tecnologías denominadas emergentes, entre las que se encuentran la aplicación de alta presión, pulsos eléctricos, pulsos magnéticos, luz ultravioleta y ultrasonido de baja frecuencia, las cuales se están estudiando como sustitutos de los tratamientos térmicos. El principal objetivo de estas tecnologías es la inactivación de microorganismos reduciendo significativamente o eliminando el uso de calor (Señorans et al., 2003). El ultrasonido dealtaintensidadybajafrecuencia,sedefine como ondas sonoras cuyas frecuencias se encuentran por encima del umbral de detección del ser humano (>16 KHz). El daño que genera el ultrasonido a las células microbianas es provocado por un fenómeno conocido como cavitación. Éste causa la alteración de la membrana celular mediante la formación de pequeñas burbujas, que al rompersecercadelacélulageneranciclosde compresión/expansión. Cuando se utilizan bajas frecuencias yaltas intensidades la onda ultrasónica genera altos gradientes de presión, corte y temperatura, provocando el colapsocelularmediantelaformacióndeuna gran cantidad de poros en la membrana, causando la fuga del líquido intracelular. También durante la cavitación se generan altas temperaturas que pueden tener algún efecto sobre los microorganismos, pero estos cambios de temperatura ocurren momentáneamente y sólo en el líquido que rodea a las células, causando daño a un número limitado de éstas (Gould, 1988; López-Malo et al., 1999; Piyasena et al., 2003; Raso y Barbosa-Cánovas, 2003; Condón etal.,2005).
El tratamiento con ultrasonido por sí sólo no es suficientemente efectivo para inactivar los microorganismos presentes en un alimento, por lo que debe combinarse con otros factores que aumenten de forma
considerable la inactivación microbiana. Se ha comprobado que cuando el ultrasonido se combina con niveles moderados de otros factores como presión (manoultrasonicación), temperatura (termoultrasonicación) o ambos (termomanoultrasonicación), hay un incremento notable en el efecto letal sobre los microorganismos, sin que se presenten alteraciones considerables de las características físicas, químicas y/o sensoriales del alimento (Guerrero et al., 2001; López-Malo et al., 2005; Mañas y Pagán,2005).
La combinación de estos factores junto con otros como la reducción del pH, la aw, y la adición de compuestos antimicrobianos, entre otros, genera un ambiente adverso, alterando los mecanismos homeostáticos en las células vegetativas y/o esporas microbianas de una forma cooperativa o sinérgica. Si el proceso involucra la interferencia multifactorial, los requerimientos o niveles de los distintos factores de preservación serán teóricamente menores y, por lo tanto, se logrará un menor daño a la calidad total del alimento (Gould, 1995;Mañas et al.,2000;AlzamorayLópezMalo, 2002). Tradicionalmente se conoce a este tipo de combinaciones multifactoriales como tecnología de obstáculos. Aunque se han realizado un gran número de estudios relacionados con la tecnología de obstáculos (Señorans et al., 2003; Broda, 2007; Kuldiloke et al., 2007), no existe todavía un enfoque sistemático de la aplicación de este concepto, limitado actualmente a muchas tecnologías empíricas artesanales yaalgunos cuantos desarrollos intencionales de nuevos productos(Alzamora et al.,1995).
Para comprender y evaluar la acción que los diversos factores de conservación presentes en la tecnología de obstáculos ejercen en la inactivación de microorganismos, esnecesariorecurriral uso
R.
Avila-Sosa
etal. / Temas Selectos de Ingeniería de Alimentos 2 – 2 (2008): 102 – 111
de modelos matemáticos. Éstos describen y predicen el crecimiento, supervivencia e inactivación microbiana, así como sus procesos bioquímicos bajo condiciones específicas. Para aplicar modelos matemáticos, primero se obtienen datos poblacionales en función del tiempo, de microorganismos que son cultivados en condiciones controladas con diferentes factores de conservación. Una vez obtenidos los resultados del comportamiento microbiano, se realiza una modelación de tipo primario por medio de ajustes con ecuaciones matemáticas específicas, con la finalidad deobtener diferentes parámetros de tipo biológico, los cuales describen los cambios de una población con respecto al tiempo y además dan información acerca del microorganismo (duración de la fase lag). Posteriormentesellevaa cabola modelación secundaria, en la cual los parámetros biológicos obtenidos en el modelado primario son analizados estadísticamente, con la finalidad de observar cambios en los parámetros por efecto de los diferentes factores de conservación que fueron significativos de la respuesta. En este punto seobservasi losefectos sonsignificativosen el desarrollo del microorganismo, así como la posible existencia de interacciones de dichos factores. Por último, el análisis estadístico genera ecuaciones que se usan para modelar y/o predecir las respuestas del microorganismo bajo nuevas condiciones (o sus combinaciones), permitiendo la interpolación dentro de los intervalos estudiados (Buchanan y Whiting, 1997; Peleg y Cole, 1998; Alzamora et al., 2000; BettsyEveris,2005;LebertyLebert,2006).
El propósito del presente trabajo fue modelar la inactivación termoultrasónica de Staphyloccocus aureus, mediante la aplicación simultánea de ultrasonido de baja frecuencia a diferentes amplitudes de onda, alta temperatura, y diferentes
concentracionesdevainillina,enunmediode cultivocon aw ypHreducido.
Materialesymétodos
Staphyloccocusaureus
Seutilizó Staphyloccocus aureus obtenidoen el Laboratorio de Microbiología de la Universidad de las Américas Puebla. El microorganismo se mantuvo inoculado en caldo de soya tripticasa (Merck, México). Para la realización de los diferentes experimentos, los microorganismos se hicieron crecer a fase exponencial (109 UFC/ml) inoculando una asada del cultivo puro en 10 mL de caldo soya tripticasa e incubándoloa35°Cdurante18horas.
Aplicacióndetratamientosultrasónicos
Los tratamientos termoultrasónicos fueron realizados en un vaso de doble pared estéril (4.5cmdediámetrointerno,8.5cmdealtura), en el cual circulaba agua con temperatura controladamedianteunbañoderecirculación (Modelo1268-24,Cole-Palmer,Chicago IL), para obtener temperaturas de 40-60°C. Se aplicóultrasonidoa20KHzcon unapuntade 25.4mm de diámetro (CPX-400, ColeParmer, Chicago, IL), utilizando continuamenteamplitudes de60,75 ó 90µm. La punta se mantuvo a 4cm de distancia del fondodelvaso(López-Malo et al.,2005).
Las combinaciones de los diferentes factores (temperatura, amplitud de onda ultrasónica y concentración de vainillina) fueron generadas por el programa DesingExpert (Stat Ease Inc., 2002) mediante la aplicación del diseño de superficie de respuesta Box Behnken de un solo bloque (Montgomery, 1998), con 17 experimentos a tres niveles, y a diferentes intervalos de
R. Avila-Sosa etal. / Temas Selectos de Ingeniería de Alimentos 2 – 2 (2008): 102 – 111
Tabla I. Diseño experimental final de Box Benken para los factores evaluados
Experimento
Temperatura Amplitud de onda Concentración de Vainillina Tiempo
1507535015 250 75350 15 350 75350 15 460 75200 15 540 60350 40 650 75350 15 750 90200 15 860 75500 15 950 75350 15 1060 60350 15 1140 75500 40 12407520040 13507550015 14409035040 15506020015 16506050015 17609035015
tiempo de tratamiento (Tabla I). Para cada tratamiento se inoculó el microorganismo (≈104UFC/ml) en 50ml de caldo soya tripticasaajustado a aw 0.96 consacarosa ya pH de 3.5 con ácido clorhídrico 1N (Fisher, México) esterilizado por filtración (tamaño de poro de 10µm). Se agregó vainillina (Sigma-Aldrich, EE.UU.) en solución alcohólica(1000ppm),lacualfueesterilizada por filtración (10µm) para ajustar los sistemas a 200, 350 y 500ppm. Se tomaron muestras de los medios formulados sujetos a tratamientos termoultrasónicos, a las que se realizaron diluciones seriadas (0.1% peptona decaseína,Merk,México)ysesembraronen cajas de agar soya tripticasa (Merk, México) por medio del sistema de siembra por dilución en espiral (Autoplate 4000, Spiral Biotech, Norwood, MA) y se incubaron a 35°C durante 24 horas para su lectura en el contador automático de colonias (Q-Count, Spiral Biotech, Norwood, MA). Cada toma sehizoportriplicado.
Modelaciónmatemática
Para realizar la modelación matemática, con los datos obtenidos se generaron curvas de muerte para Staphylococcus aureus, que fueron ajustadas mediante una regresión no lineal utilizando el modelo de Fermi (Peleg, 1997),delcualseobtuvieronlosparámetros: a (pendientedelacurva) y tc (tiempo enque sedisminuyeel50%delapoblacióninicial).
La modelación secundaria se realizó para cada parámetro del modelo de Fermi, a y tc, analizando los factores de los tratamientos, que resultaron significativos con un nivel de confianza del 95%, utilizando el programa Desing-Expert(StatEaseInc.,2002).
Resultadosydiscusión
De los experimentos realizados, cuando se aplicaron los niveles más altos de temperatura (60°C) se obtuvieron cinéticas de muerte de primer orden (Fig. 1a); sin embargo cuando se utilizaron temperaturas
R. Avila-Sosa etal. / Temas Selectos de Ingeniería de Alimentos 2 – 2 (2008): 102 – 111
Tiempo (Min)
010203040
Tiempo (min)
Tiempo (min)
Fig. 1 Curva de muerte de Staphylococcus aureus, en un sistema modelo formulado a pH 3.5 y aw 0.96: a) con 500ppm de vainillina, tratado a 60°C y 75µm de amplitud de onda ultrasónica; b) con 350ppm de vainillina, tratadoa 50°C y 75µm de amplitud de onda ultrasónica; c) con 350ppm de vainillina, tratadoa 40°C y90µmdeamplitud de onda ultrasónica
menores a 60°C, las cinéticas de muerte no presentaron una tendencia de primer orden dependientedelatemperatura(Fig.1b yFig. 1c). Esto fue probablemente provocado por
la intervención de los otros factores (amplitud de onda ultrasónica y concentración de vainillina), que afectaron tanto la forma como la velocidad de muerte.
R.
Avila-Sosa
etal. / Temas Selectos de Ingeniería de Alimentos 2 – 2 (2008): 102 – 111
TablaII. Análisis devarianza del parámetro a dela ecuacióndeFermi encurvas demuertede Staphylococcus aureus
FuenteCoeficientesSCg.lCME F P
Modelo0.99
20.7245.1826.74< 0.0001
a Temperatura*-1.4015.6115.680.55< 0.0001
b Vainillina*-0.290.6810.683.510.0086
Temperatura 2 * 0.822.8612.8614.790.0023
Temperatura x Vainillina*0.631.5711.578.120.0146
Residuales 2.32120.19
Ajuste1.8980.242.190.2345
Error0.4340.11
Total 23.0416
a Temperatura (°C)
b Vainillina (ppm)
* Significativo a P <0.05
Porello,sebuscaronmodelosnolinealesque ajustaran a este tipo de curvas. El modelo que tuvo el mejor ajuste, para todas las curvas de muerte generadas con los datos obtenidos, fue el de Fermi con una correlación (R2) promedio de 0.967±0.03, propuestoparaalimentosporPeleg(1997),el cual describe una curva de muerte tipo sigmoidea. Se utilizó la ecuación de Fermi debido a que tiene las características matemáticas básicas de la ecuación logística continua, por lo que sólo justifica curvas que no son completamente asimétricas alrededor de su punto de inflexión. Una ventaja de dicha ecuación es que sus constantes son interpretadas fácilmente en función de la forma de las curvas. Sin embargo, lo que lo haceparticular yatractivoessucapacidadde describir decaimientos muy agudos. Al aplicarelmodelodeFermi(Ec.1)segeneran dosparámetrosimportantes, a y tc,apartirde lasiguienteecuación:
log(N/No); t es el tiempo al cual se tomó la muestra; tc corresponde al tiempo que se necesitó para reducir al 50% la población inicial; y a que es la pendiente de la curva e indica el tiempo al cual hay un cambio de velocidad de muerte a partir del punto de inflexióndelacurva.
Donde: x es el número de microorganismos expresados como
Para la determinación del parámetro a, fueron significativos (P<0.05) los factores de temperatura, concentración de vainillina, la temperatura al cuadrado, y la interacción entre temperatura y vainillina (Tabla II). En la Fig. 2 se observa que cuando se utilizan altos valores de temperatura (>55°C), el valordeaesmenor ynoseveafectadoporla concentración de vainillina, ya que éste permanece constante. La interacción de ambos factores se puede observar en los niveles de temperatura más bajos (40-45°C); existe un claro efecto sinérgico con la vainillina en altas concentraciones (300 a 400ppm), el cual provoca una disminución delparámetroadeaproximadamente50%.El factor de amplitud de onda ultrasónica no tuvo significancia para este parámetro. Mourtzinos et al. (2008) reportaron que las bacterias Gram negativas son más sensibles que las Gram positivas ante la presencia de
R. Avila-Sosa etal. / Temas Selectos de Ingeniería de Alimentos 2 – 2 (2008): 102 – 111
a (min)

Fig. 2. Gráfica de
de respuesta para el
a de la
de Fermi en las curvas de
para Staphylococcus aureus, en un sistema modelo formulado a pH 3.5 y aw 0.96
vainillina, y que la concentración mínima inhibitoria para Staphylococcus aureus es de 1200ppm. También se han publicado una gran cantidad de estudios acerca del efecto de la vainillina como sustancia antimicrobiana en diferentes tipos de microorganismos (Cerrutti y Alazmora, 1997; Delaquis et al., 2005; Rupasinghe et al., 2006; Ngarmsak et al., 2006), en los cuales elfactorcomúneselrequerimientode altas concentraciones de vainillina para
inhibirelcrecimientomicrobiano(entre1000 y 1500ppm para inhibición in Vitro). Por tanto, la combinación de temperatura, aw y pH favorece a la utilización de menores concentraciones de vainillina. Para que la vainillina tenga un efecto inhibitorio, Mourtzinos et al. (2008) consideran como punto crítico el pH, ya que la molécula de vainillina es más activa cuando se encuentra en un estado no disociado; se afirma que a mayor pH, mayor actividad antimicrobiana.
TablaIII. Análisis de varianza del parámetro t c dela ecuacióndeFermi encurvas de muertede Staphylococcus aureus
FuenteCoeficientesSCg.lCMEF P
Modelo3.85 569.324142.3378.37< 0.0001
a Temperatura*-7.58459.761459.76253.17< 0.0001
b Amplitud de onda*-1.058.7618.764.820.0485
Temperatura 2 * 4.6691.87191.8750.59< 0.0001
Temperatura x Amplitud de Onda*1.498.9318.934.920.0467
Residuales 21.79121.82
Ajuste19.0982.393.530.1191
Error2.740.68
Total 591.1116
a Temperatura (°C)
b Amplitud de onda ( m)
* Significativo a P <0.05
Avila-Sosa
tc (min)

µm)
Fig. 3. Gráfica de superficie de respuesta para el parámetro tc de la ecuación de Fermi en las curvas de muerte para Staphylococcus aureus, en un sistema modelo formulado a pH
3.5 y aw 0.96
En este estudio, a pesar de que el pH es muy bajo y, por tanto, se supone se tiene un alto grado de disociación molecular en la vainillina, tanto la temperatura como la acción de las ondas ultrasónicas, juegan un papel importante en aumentar la actividad antimicrobiana de este compuesto, debido a que provocan una aumento en la energía cinética de las moléculas. Fitzgerald et al (2004) afirman que el mecanismo primario de acción de la vainillina es sobre la membrana celular, ya que causa una disipación de los gradientes iónicos y la inhibicióndelarespiracióncelular.
Por lo que respecta a tc, como se observa en la Tabla III sólo los factores de temperatura y amplitud de onda ultrasónica (temperatura al cuadrado e interacción temperatura-amplitud de onda ultrasónica) fueron significativos (P<0.05). En la gráfica de la superficie de respuesta, (Fig. 3) se aprecia un comportamiento similar al presentado por el parámetro a: cuando hay altas temperaturas se logra el menor tc sin importar el valor de la amplitud de onda del ultrasonido. Así mismo, el efecto sinérgico de la amplitud de onda es a bajas
temperaturas (40-45°C), causando una disminución de tc significativa. Se ha reportado (Piyasena et al., 2003) que no hay diferencias significativas en la resistencia entre organismos Gram negativos y positivos, debidas a la amplitud de las ondas ultrasónicas, ya que el daño principal no se genera en la pared celular, sino en la doble capa lipídica de la membrana celular. Esto permite comparar con trabajos publicados recientemente, como el de Ugarte-Romero et al. (2006) quienes reportan comportamientos similares de inhibición con temperatura de 40°C y diferentes amplitudes de onda ultrasónica en la inactivación de Escherichia coli en sidra de manzana, y observan el mismo fenómeno cuando se aplican temperaturas cercanas a los 60°C, a las cuales la amplitud de onda de ultrasonido no interviene en el proceso de inactivación. Walklin-Ribeiro et al. (2008) reportaron una inactivación de tipo lineal para S. aureus en jugo de naranja reconstituido, utilizando valores similares de amplitud de ondas ultrasónicas y temperatura, pero sin la adición de ningún tipo de antimicrobiano, logrando una reducción microbiana del
R. Avila-Sosa etal. / Temas Selectos de Ingeniería de Alimentos 2 – 2 (2008): 102 – 111
mismo orden, pero en mayor tiempo (30 minutos)detratamiento.
Conclusiones
Las curvas de muerte de S. aureus generadas en este experimento se ajustaron adecuadamente al modelo de Fermi. Al observar el comportamiento de los parámetros analizados de la ecuación de Fermi, a valores cercanos a 60°C la temperatura es el factor dominante en la velocidad y el tipo de muerte; sin embargo cuando los valores de temperatura son cercanos a 40°C, existe un efecto sinérgico de los diferentes factores experimentados en la inhibición de S. aureus, utilizándose menores concentraciones de vainillina que las reportadas. La combinación de multifactores como la amplitud de onda ultrasónica, temperatura, sustancias antimicrobianas, y bajos valores de pH y aw, demuestra tener un potencial aplicativo en la industria de alimentos. Para ello es necesario hacer más estudios para generar las bases de una posible pasteurización con un enfoque multifactorial.
control of minimally processed foods. En: J. WeltiChanes, G. V. Barbosa-Cánovas y J. M. Aguilera (Eds.). EngineeringandFoodforthe21stCentury CRC Press, Boca Raton, Florida. pp. 631-650.
Alzamora, S. M., Tapia, M. S. y López-Malo, A. 2000. Overview. En: S. M. Alzamora, M. S. Tapia, y A. López-Malo (Eds.). Minimally Processed Fruits and Vegetables. Fundamental Aspects and Applications. Aspen Publishers, Inc., Gaithersburg, Maryland. pp. 1-9.
Alzamora, S.M., Cerrutti, P., Guerrero, S. y LópezMalo, A. 1995. Minimally processed fruits by combined methods. En: G.V. Barbosa-Cánovas y J. Welti-Chanes (Eds.) Food Preservation by Moisture Control.Fundamentalsand Applications Technomic Publishing Co. Inc., Lancaster. pp. 463-492.
Betts, G. y Everis, L. 2005. Modeling systems and impact on food microbiology. En: G.V. BarbosaCánovas, M.S. Tapia y P.M. Cano (Eds.). Novel Food Processing Technologies. CRC Press, Boca Raton, Florida. pp. 555-578.
Broda, D. M. 2007. The effect of peroxyacetic acidbased sanitizer, heat and ultrasonic waves on the survival of Clostridium estertheticum spores in vitro. Letters in Applied Microbiology. 45: 336341.
Buchanan, R. L. y Whiting, R. C. 1997. Predictive modeling. En: M. P. Doyle, L. R. Beuchat, y T. J. Montville (Eds.). Food Microbiology Fundamentals and Frontiers. ASM Press, Washington, D.C. pp. 728-739.
Cerrutti, P. y Alzamora, S. M. 1997. Vanillin as an antimicrobial for producing shelf-stable strawberry puree. JournalofFoodScience. 62(3):608-612.
Agradecimientos
Los autores agradecen al CONACYT (Proyecto 44088: “Enfoque multifactorial en la inocuidad y estabilidad de alimentos vegetales–productos de frutas") por el financiamiento para la realización de esta investigación.
Condón, S., Raso, J. y Pagán, R. 2005. Microbial inactivation by ultrasound. En: G.V. BarbosaCánovas, M.S. Tapia y P.M. Cano (Eds.). Novel Food Processing Technologies. CRC Press, Boca Ratón, Florida. pp. 423-442.
Delaquis, P., Stanich, K. y Toivonen, P. 2005. Effect of pH on the inhibition of Listeria spp. by vanillin and vanillic acid. Journal of Food Protection. 68(7): 1472-1476.
Referencias
Alzamora, S. M. y López-Malo, A. 2002. Microbial behavior modeling as a tool in the design and
Fitzgerald, D. J., Stratford, M., Gasson, M. J., Vekert, J., Bos, A. y Narbad, A. 2004. Mode of antimicrobial action of vanillin against Escherichia coli, Lactobacillus plantarum and Listeria innocua. Journal of Applied Microbiology. 97(1): 104-113.
R. Avila-Sosa etal. / Temas Selectos de Ingeniería de Alimentos 2 – 2 (2008): 102 – 111
Gould, G. W. 1988. Interference with homeostasisfood. En: R. Whittenbury, G. W. Gould, J.G. Banks, y R. G. Board (Eds.). Homeostatic Mechanisms in Microorganisms. Bath University Press, Bath, pp. 220-228.
Gould G. W. 1995. New Methods of Food Preservation. Balckie Academic & Profesional. Glasgow, Reino Unido. 743 p.
Guerrero, S., López-Malo, A. y Alzamora, S. M. 2001. Effect of ultrasound on the survival of Saccharomyces cerevisae: influence of temperature, pH and amplitude. Innovative Food Science&EmergingTechnologies. 2: 31-39.
Kuldiloke, J., Eshtioghi, M., Zenker, M. y Knorr, D 2007. Inactivation of lemon pectinesterase by thermosonication. International Journal of Food Engineering. 3(2): 1-8.
Lebert, I. y Lebert, A. 2006. Quantitative prediction of microbial behaviour during food processing using an integrated modelling approach: a Review. International Journal of Refrigeration. 29: 968984.
López-Malo, A., Guerrero, S. y Alzamora, S. M. 1999. Saccharomyces cerevisiae thermal inactivation kinetics combined with ultrasound. JournalofFoodProtection. 62(10): 1215-1217.
López-Malo, A., Palou, E., Jiménez-Fernández, M., Alzamora, S. M. y Guerrero, S. 2005. Multifactorial fungal inactivation combining thermosonication and antimicrobials. Journal of FoodEngineering. 67: 87-93.
Mañas, P. y Pagán, R. 2005. Microbial inactivation by new technologies of food preservation. Journal of AppliedMicrobiology. 98: 1387–1399
Mañas P., Pagán R. y Raso J. 2000. Predicting lethal effect of ultrasonic waves under pressure treatments on Listeria monocytogenes ATCC 15313 by power measurements. Journal of Food Science. 65(4): 663-667
Montgomery, D. C. 1998. Diseño y Análisis de Experimentos. Grupo Editorial Iberoamérica, Mexico D.F. 632 p.
Mourtzinos, I., Konteles, S., Kalogeropoulos, N. y Karathanos, V.T. 2008. Thermal oxidation of vanillin affects its antioxidant and antimicrobial properties. FoodChemistry. En prensa.
Ngarmsak, M., Delaquis, P., Toivonen, P., Ngarmsak, T., Ooraikul, B. y Mazza, G. 2006. Antimicrobial
activity of vanillin against spoliage microorganisms in strore fresh-cut mangoes. JournalofFoodProtection. 69(7):1724-1727.
Peleg, M. 1997. Modeling microbial populations with the original and modified versions of the continuous and discrete logistic equations. Critical Reviews inFood Science and Nutrition. 37(5):471490.
Peleg, M. y Cole M. B. 1998. Reinterpretation of microbial survival curves. Critical Reviews in FoodScienceandNutrition. 38(5):353-380.
Piyasena, P., Moharelo, E. y McKellar, R. C. 2003. Inactivation of microbes using ultrasound: a review. International Journal of Food Microbiology. 87:207-216.
Raso, J. y Barbosa-Cánovas, G. V. 2003. Nonthermal preservation of foods using combined processing techniques. Critical Reviews in Food ScienceandNutrition. 43(3):265-285.
Rupasinghe, H. P., Boulter-Bitzer, J., Ahn, T. y Odumeru, J. A. 2006. Vanillin inhibits pathogenic and spoilage microorganisms in vitro and aerobic microbial growth in fresh cut apples. Food ResearchInternational. 39(5):575-580
Señorans, F. J., Ibáñez, E. y Cifuentes, A. 2003. New trends in food processing. Critical Reviews in FoodScienceandNutrition. 43(5):507-526.
Ugarte-Romero, E., Feng, H., Martin, S. E., Cadwallader, K. R. y Robinson, S. J. 2006. Inactivation of Escherichia coli with power ultrasound in apple cider. JournalofFoodScience 71(2): E102-E108.
Walkling-Ribeiro, M., Noci, F., Reiner, J., Cronin, D. A., Lyng, J. G. y Morgan D. J. 2008. The impact of thermosonication and pulsed electric fields on Staphylococcus aureus inactivation and selected quality parameters in orange juice. Food BioprocessTechnology. En prensa.